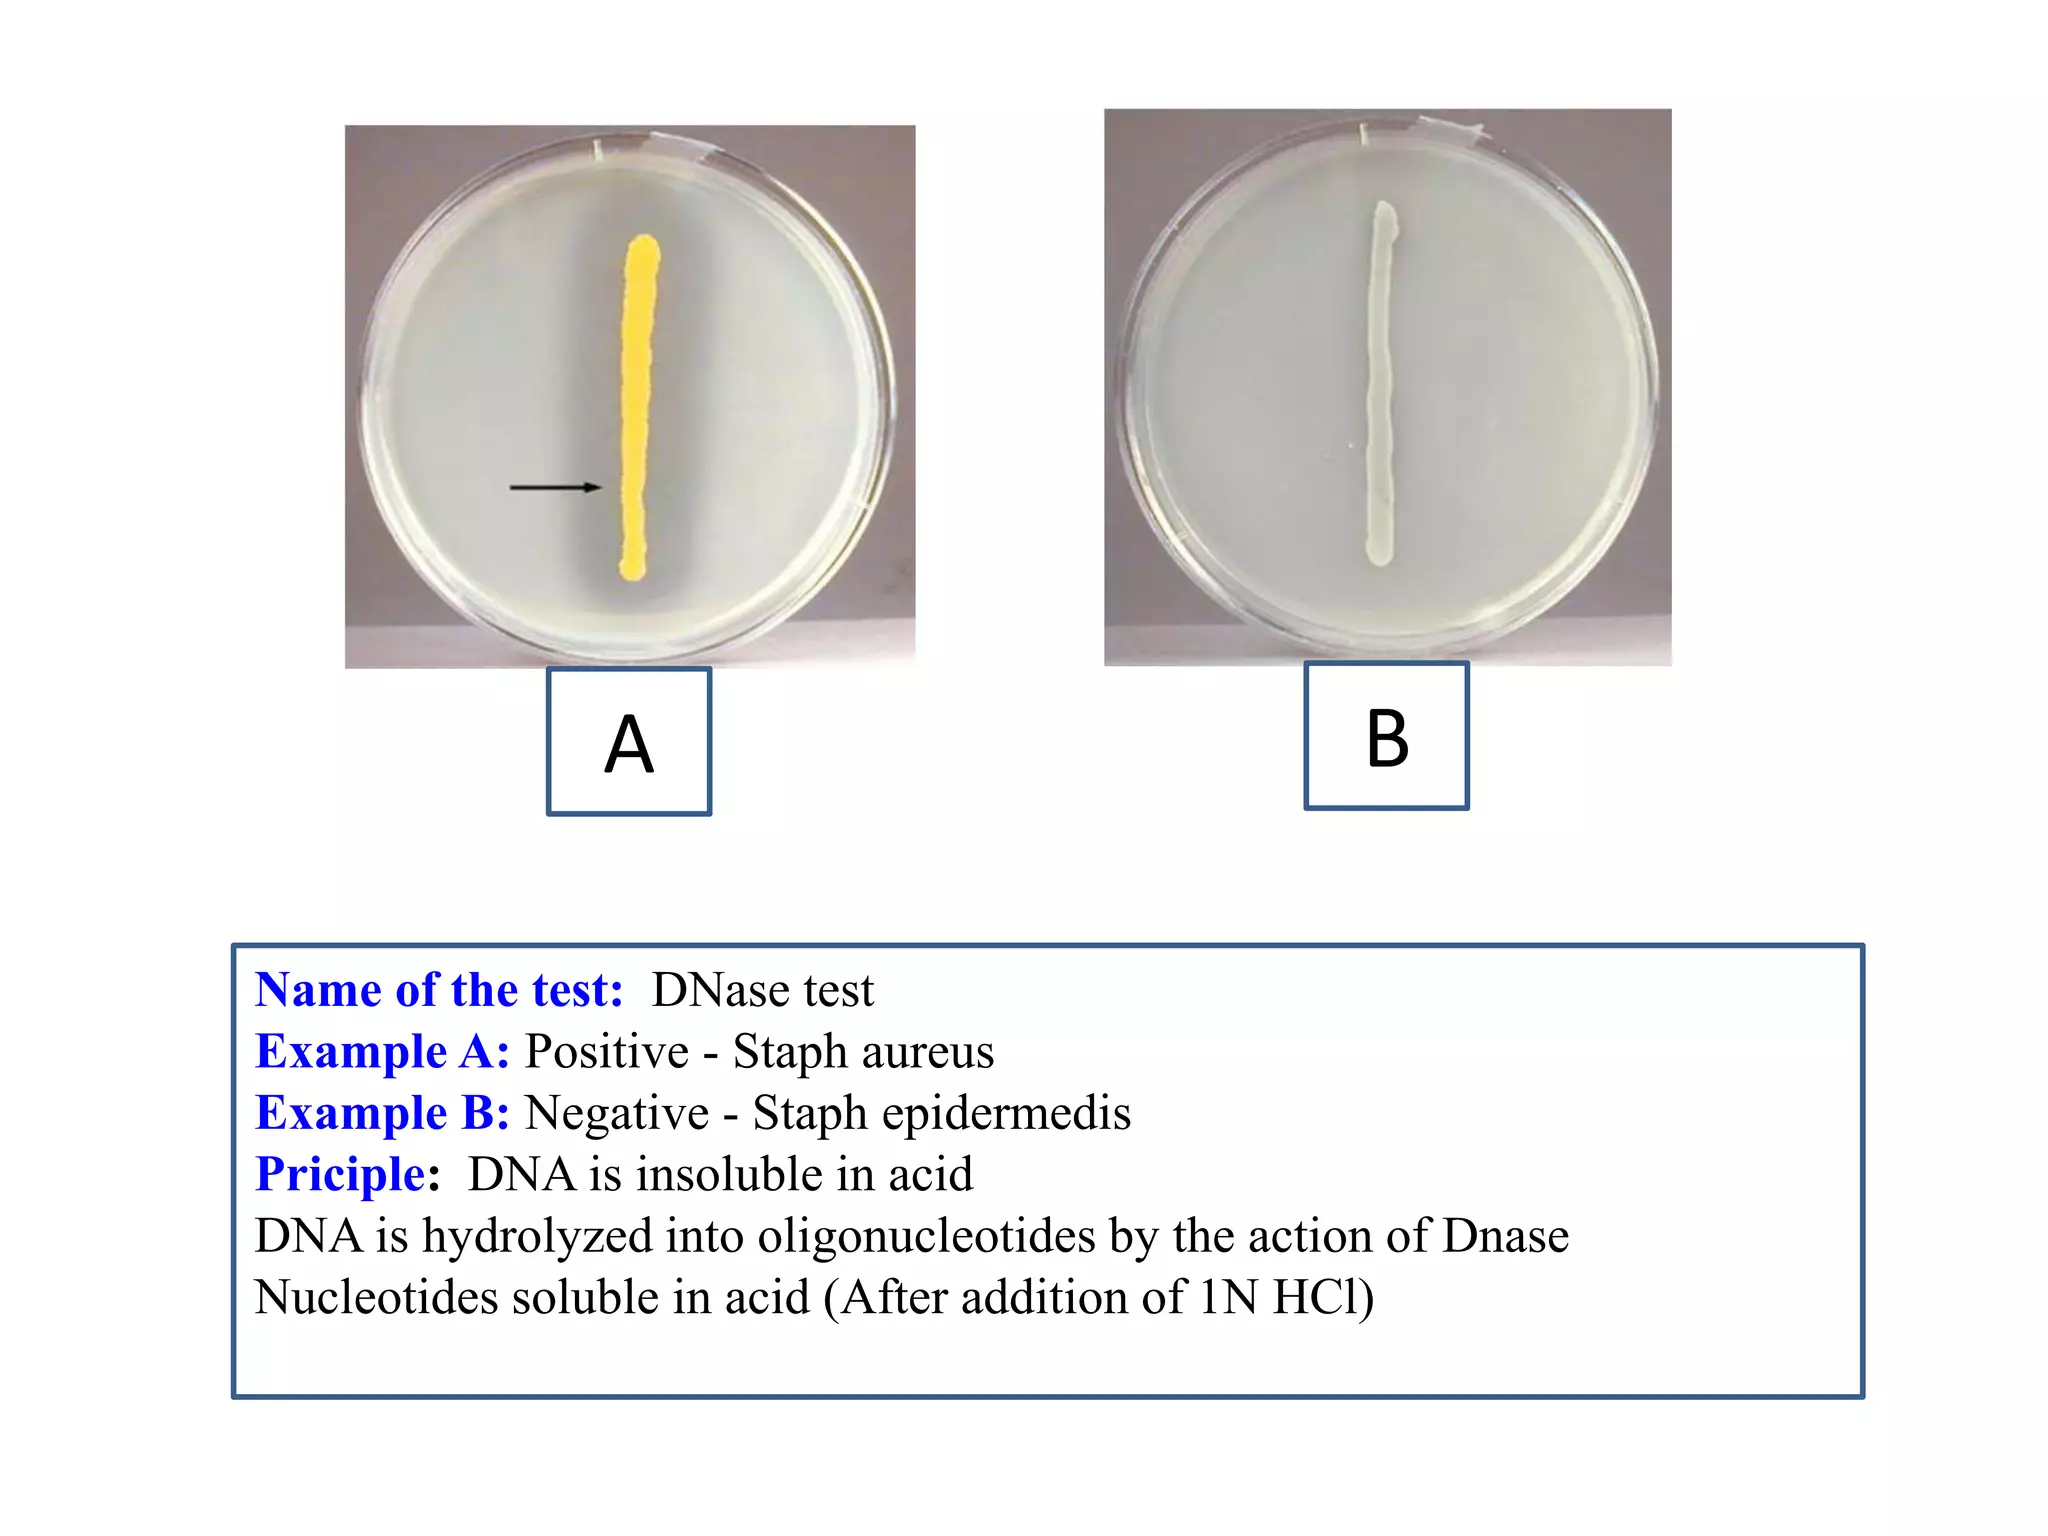
A 
B 
Name of the test: DNase test 
Example A: Positive - Staph aureus 
Example B: Negative - Staph epidermedis 
Priciple: DNA is insoluble in acid 
DNA is hydrolyzed into oligonucleotides by the action of Dnase 
Nucleotides soluble in acid (After addition of 1N HCl)
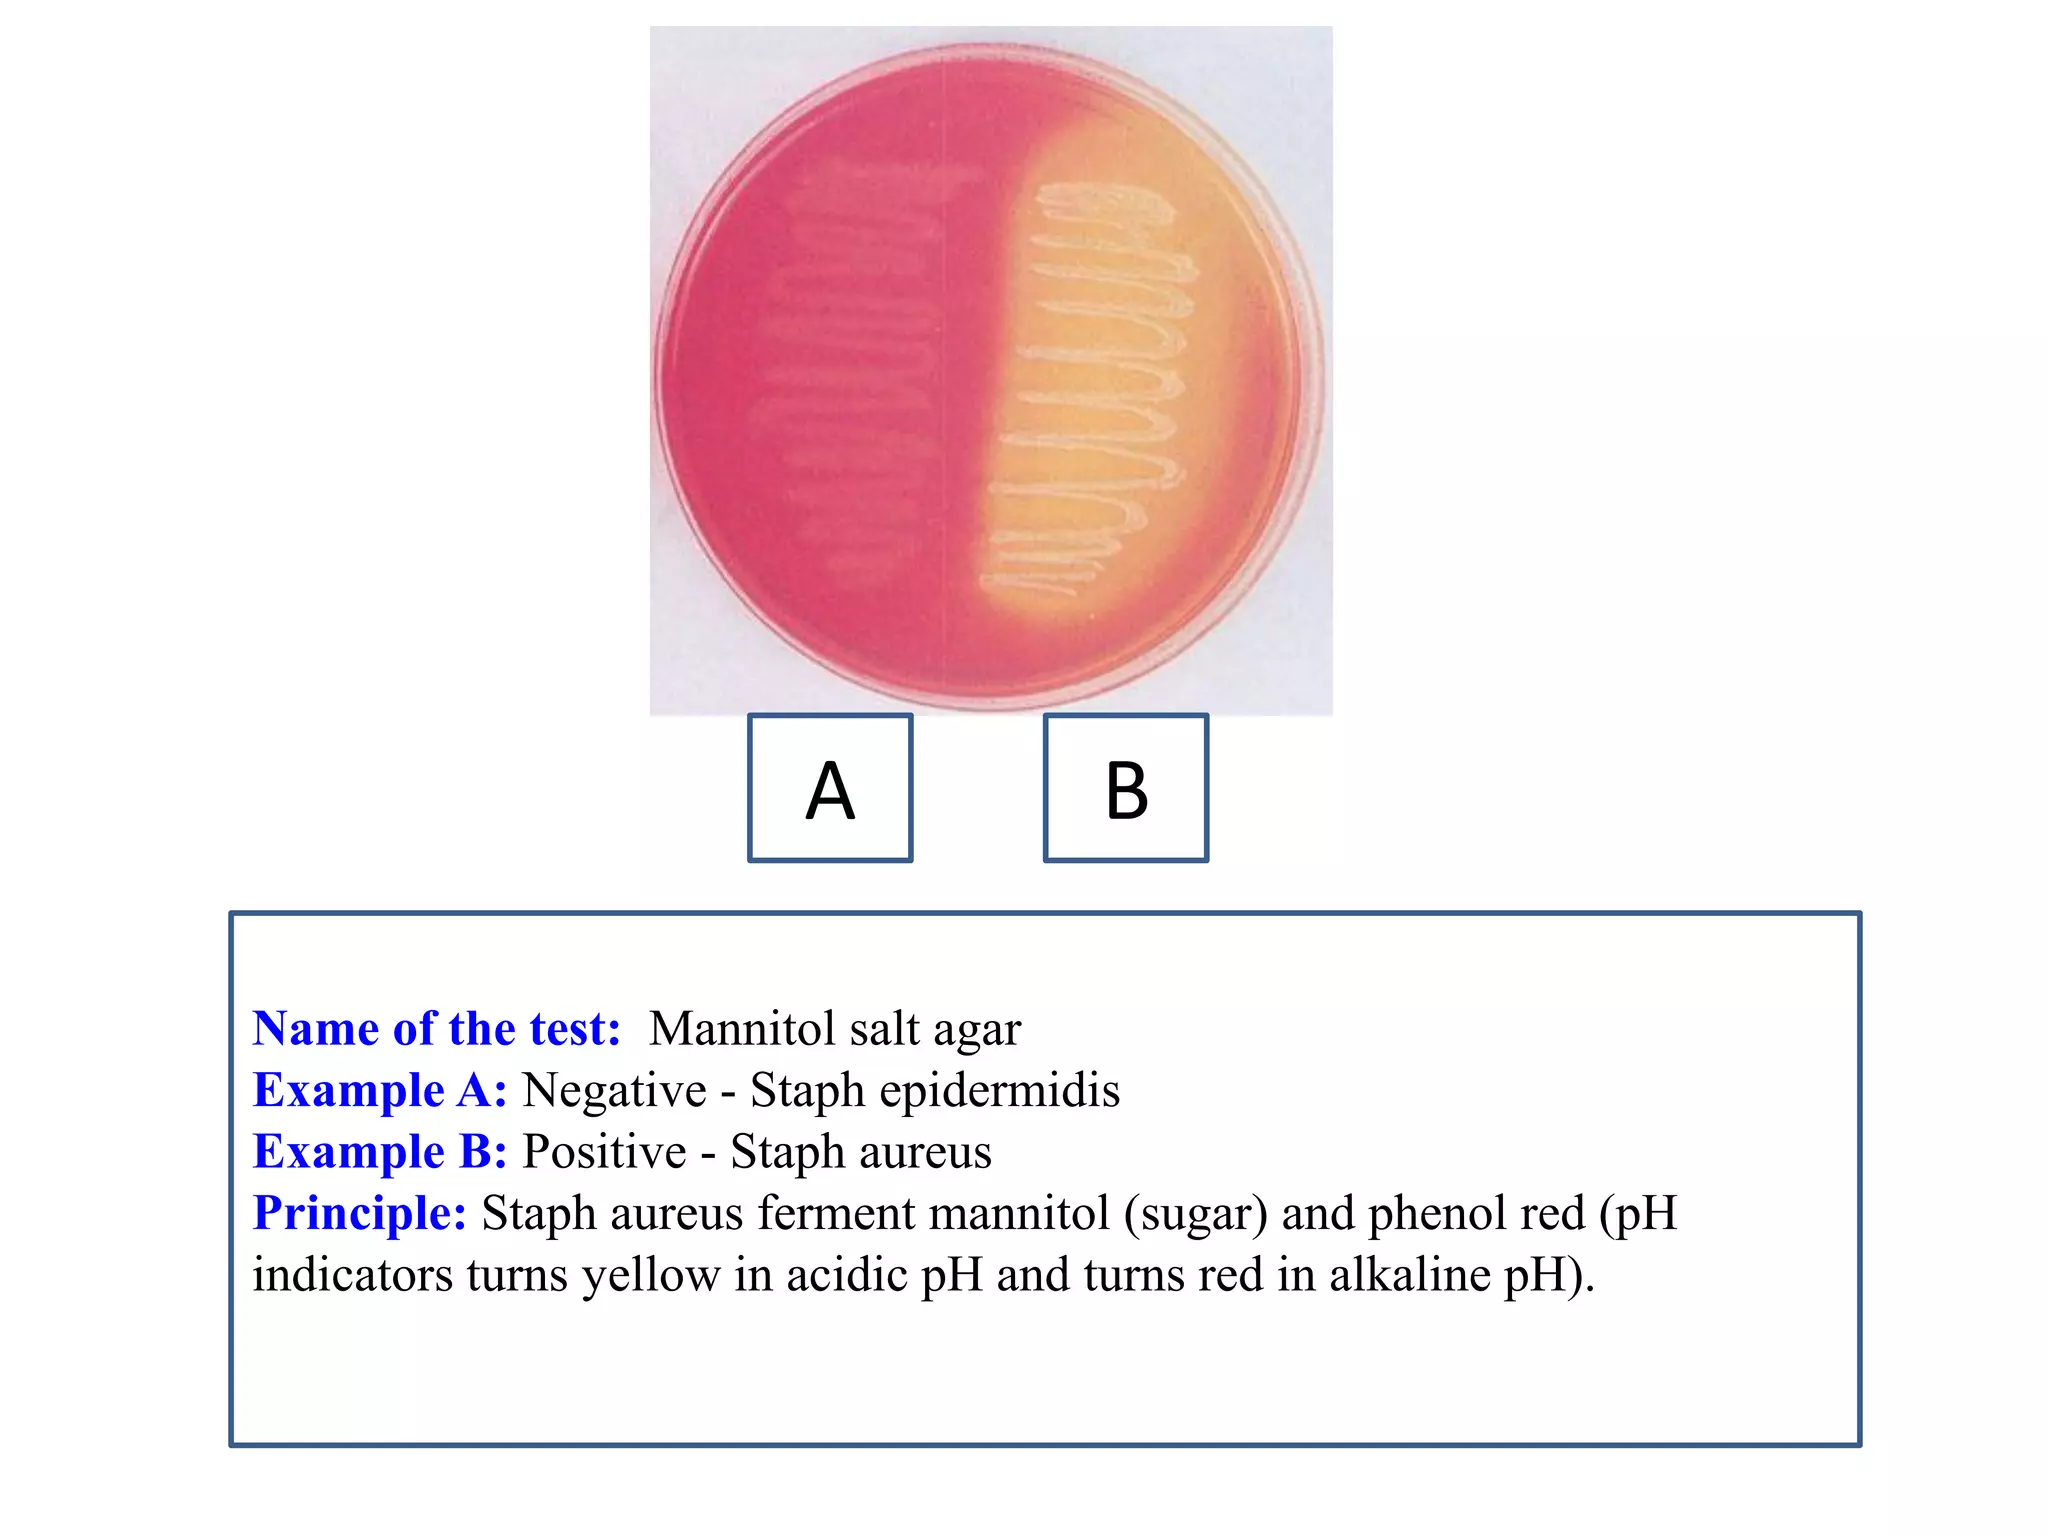
Name of the test: Mannitol salt agar 
Example A: Negative - Staph epidermidis 
Example B: Positive - Staph aureus 
Principle: Staph aureus ferment mannitol (sugar) and phenol red (pH indicators turns yellow in acidic pH and turns red in alkaline pH). 
A 
B
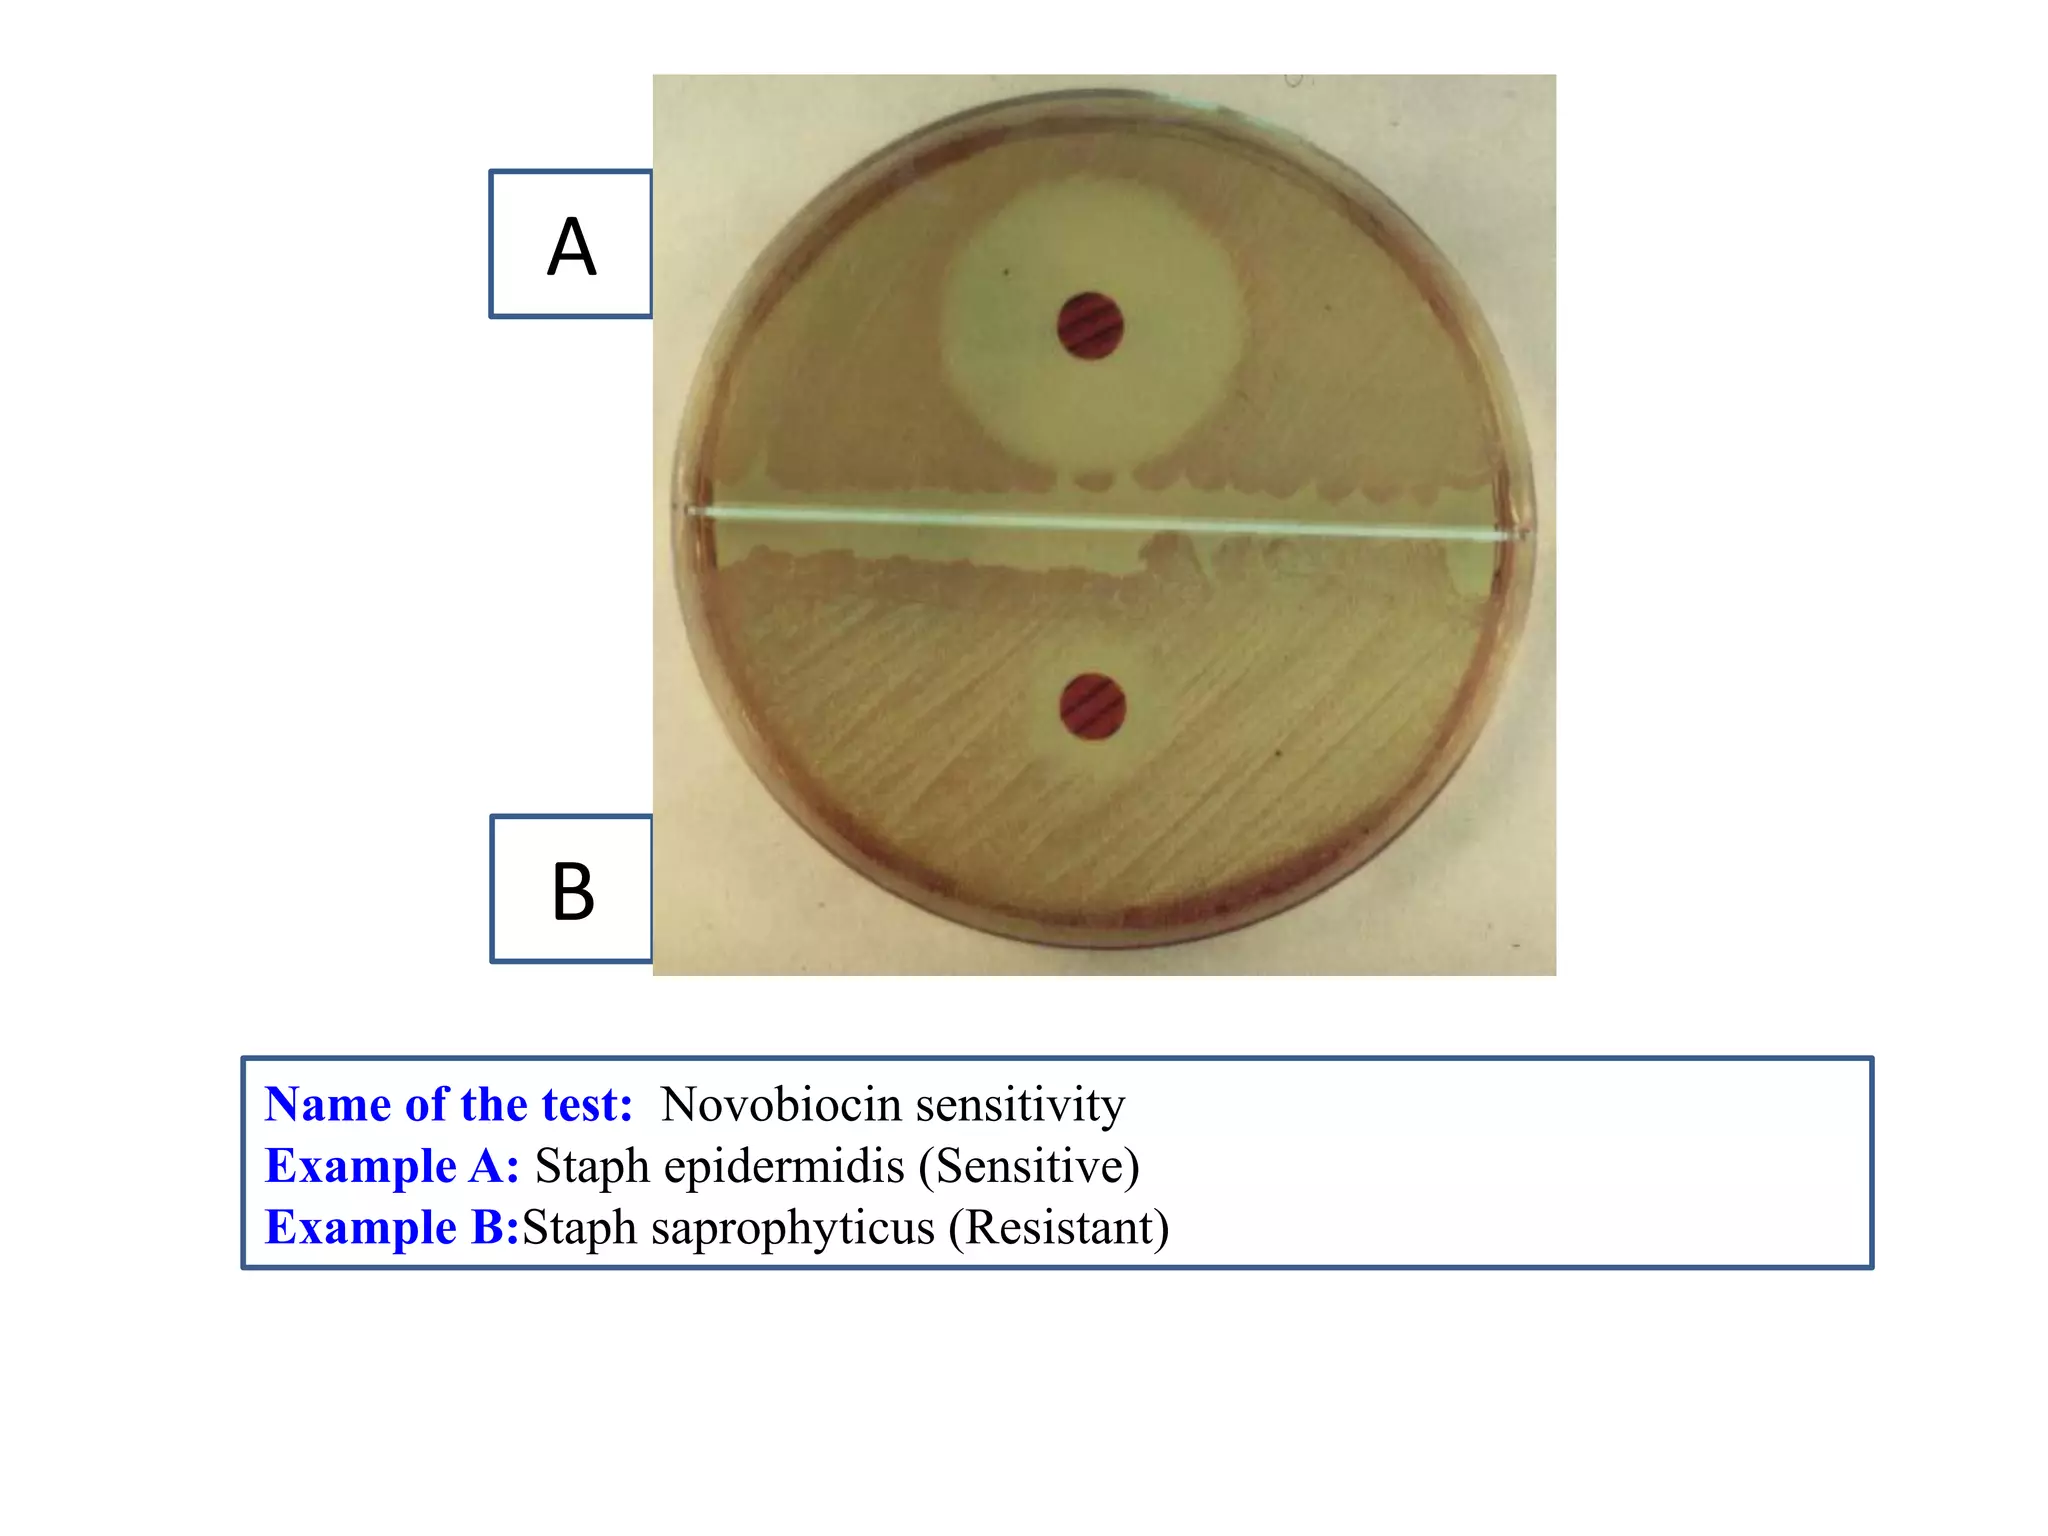
Name of the test: Novobiocin sensitivity 
Example A: Staph epidermidis (Sensitive) 
Example B:Staph saprophyticus (Resistant) 
A 
B
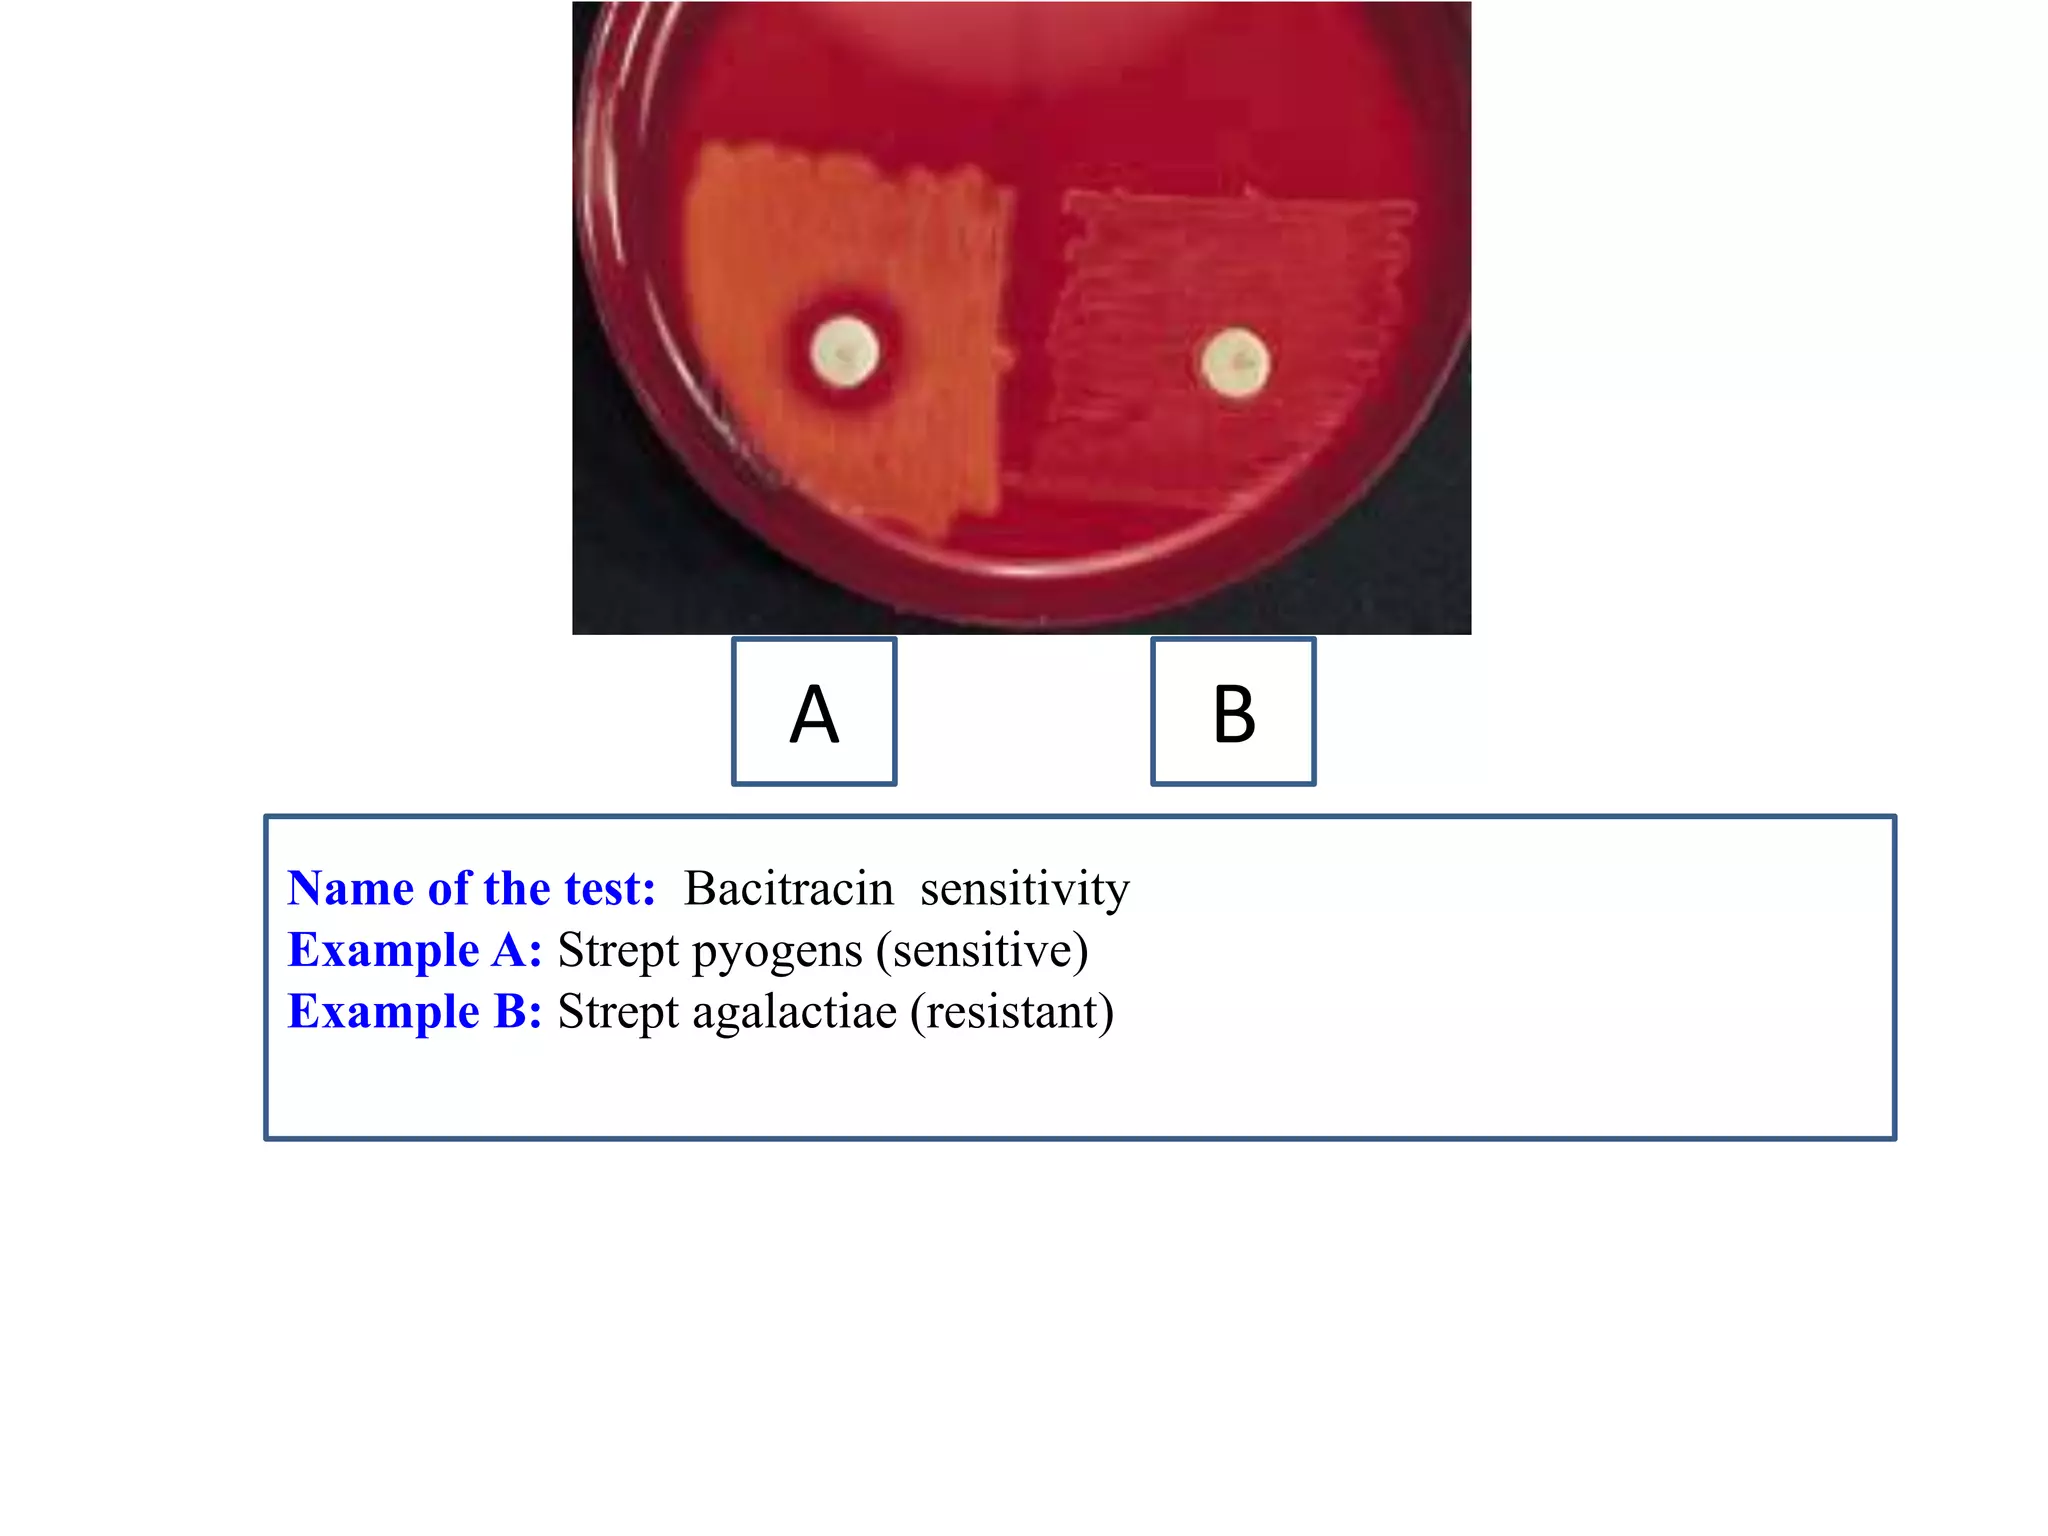
Name of the test: Bacitracin sensitivity 
Example A: Strept pyogens (sensitive) 
Example B: Strept agalactiae (resistant) 
A 
B
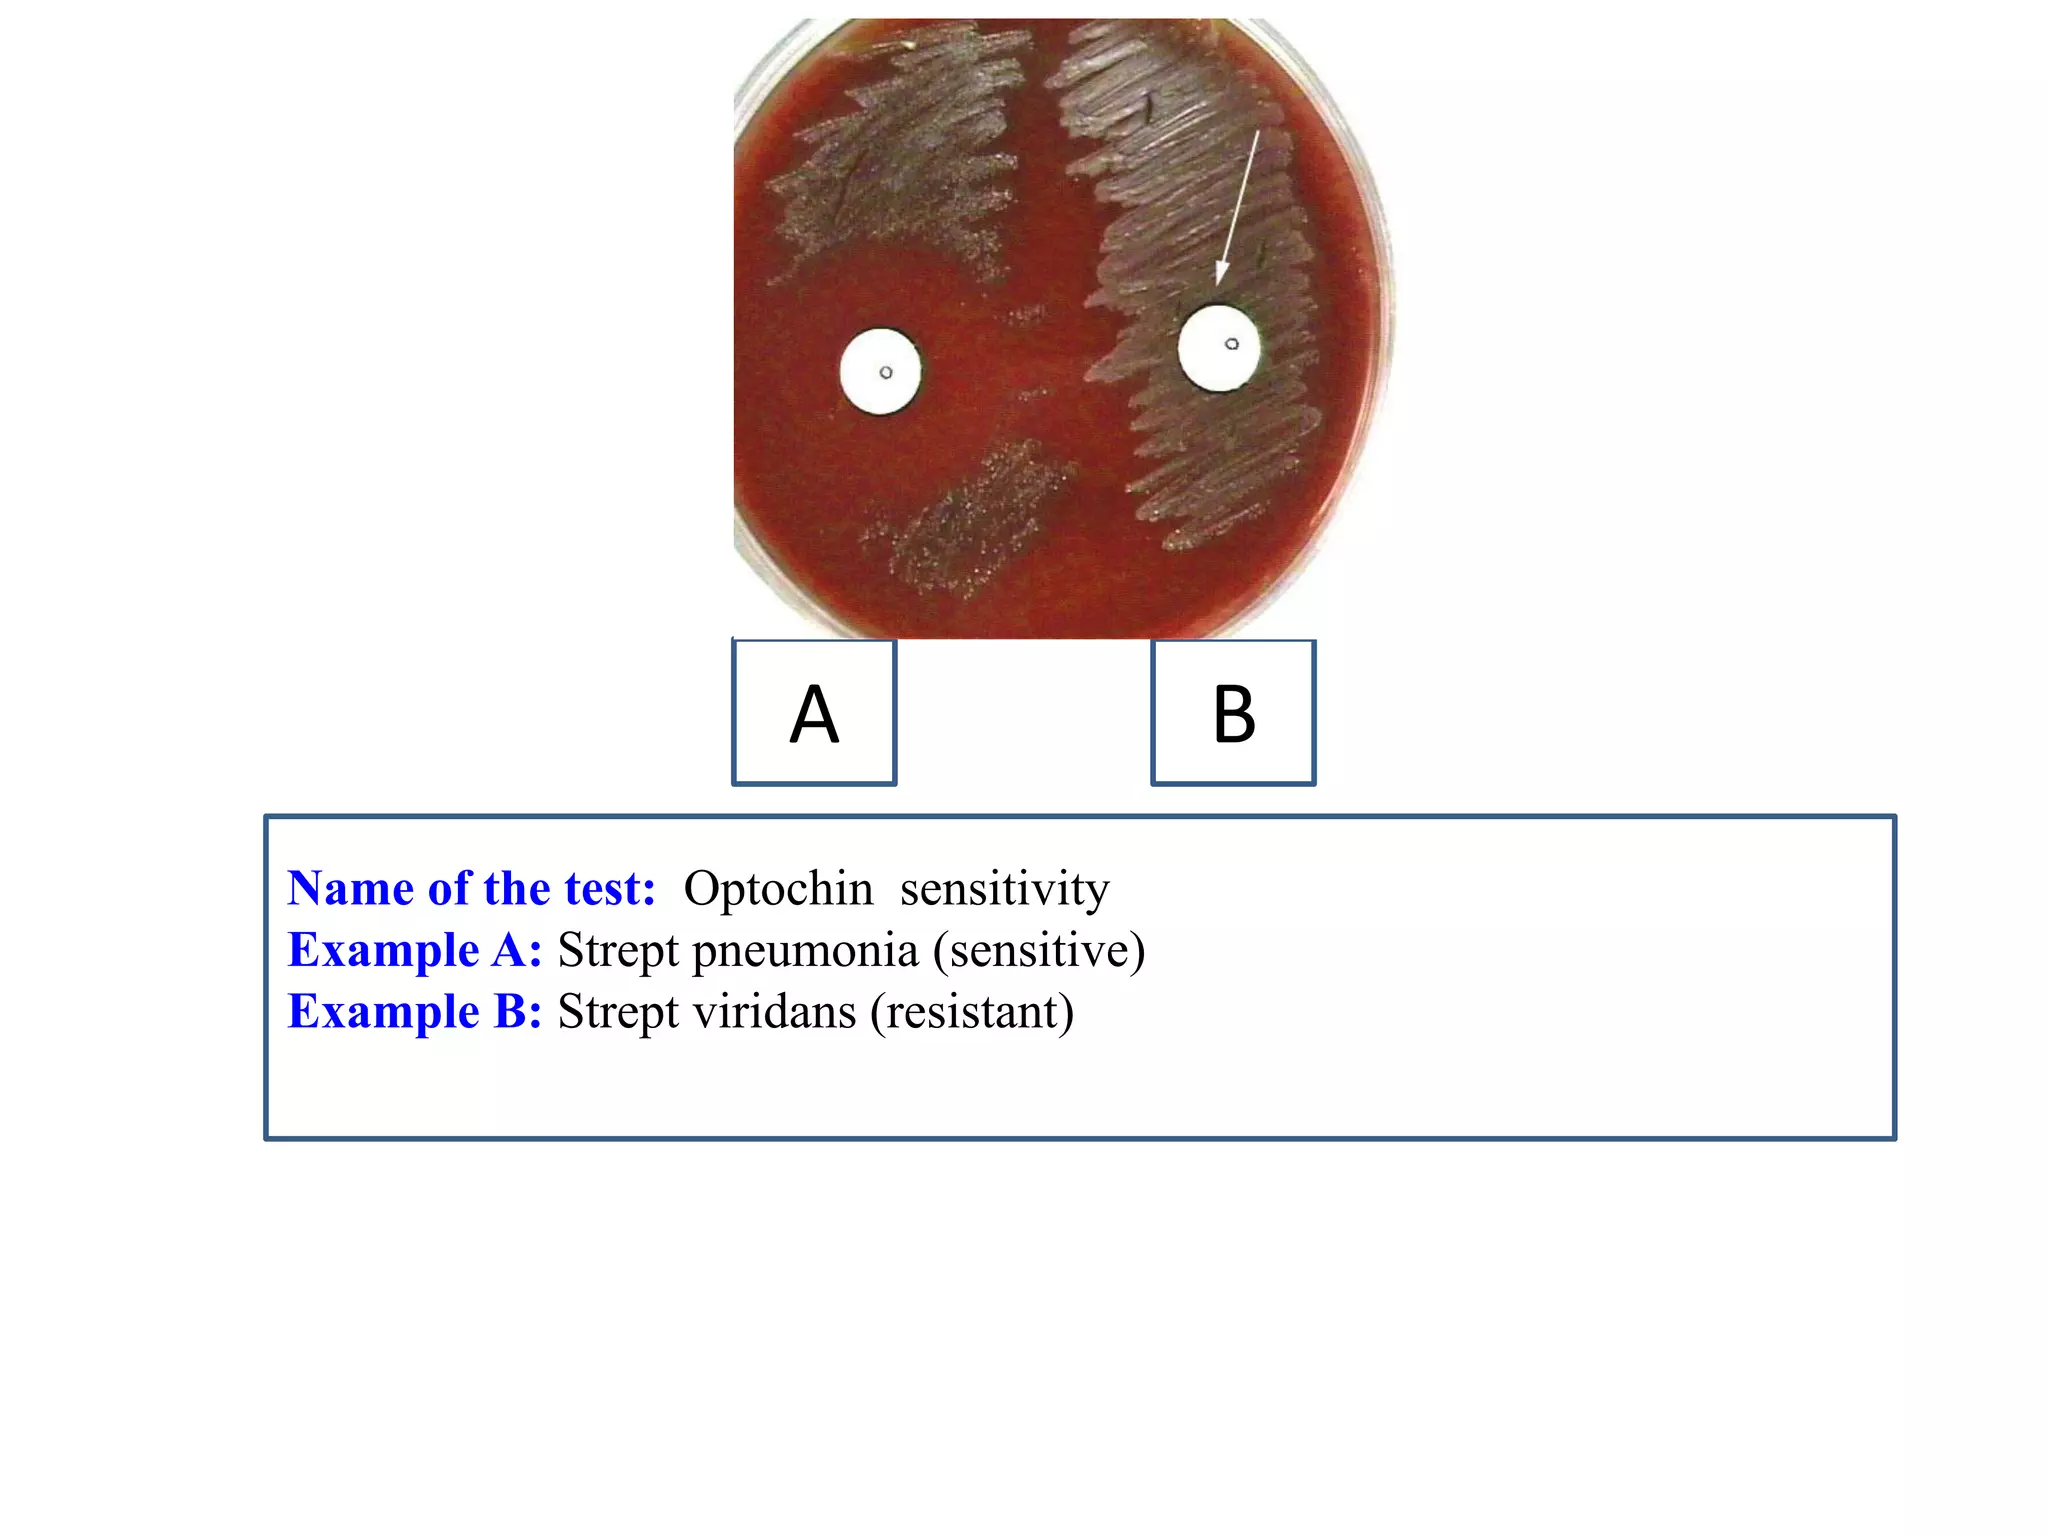
Name of the test: Optochin sensitivity 
Example A: Strept pneumonia (sensitive) 
Example B: Strept viridans (resistant) 
A 
B
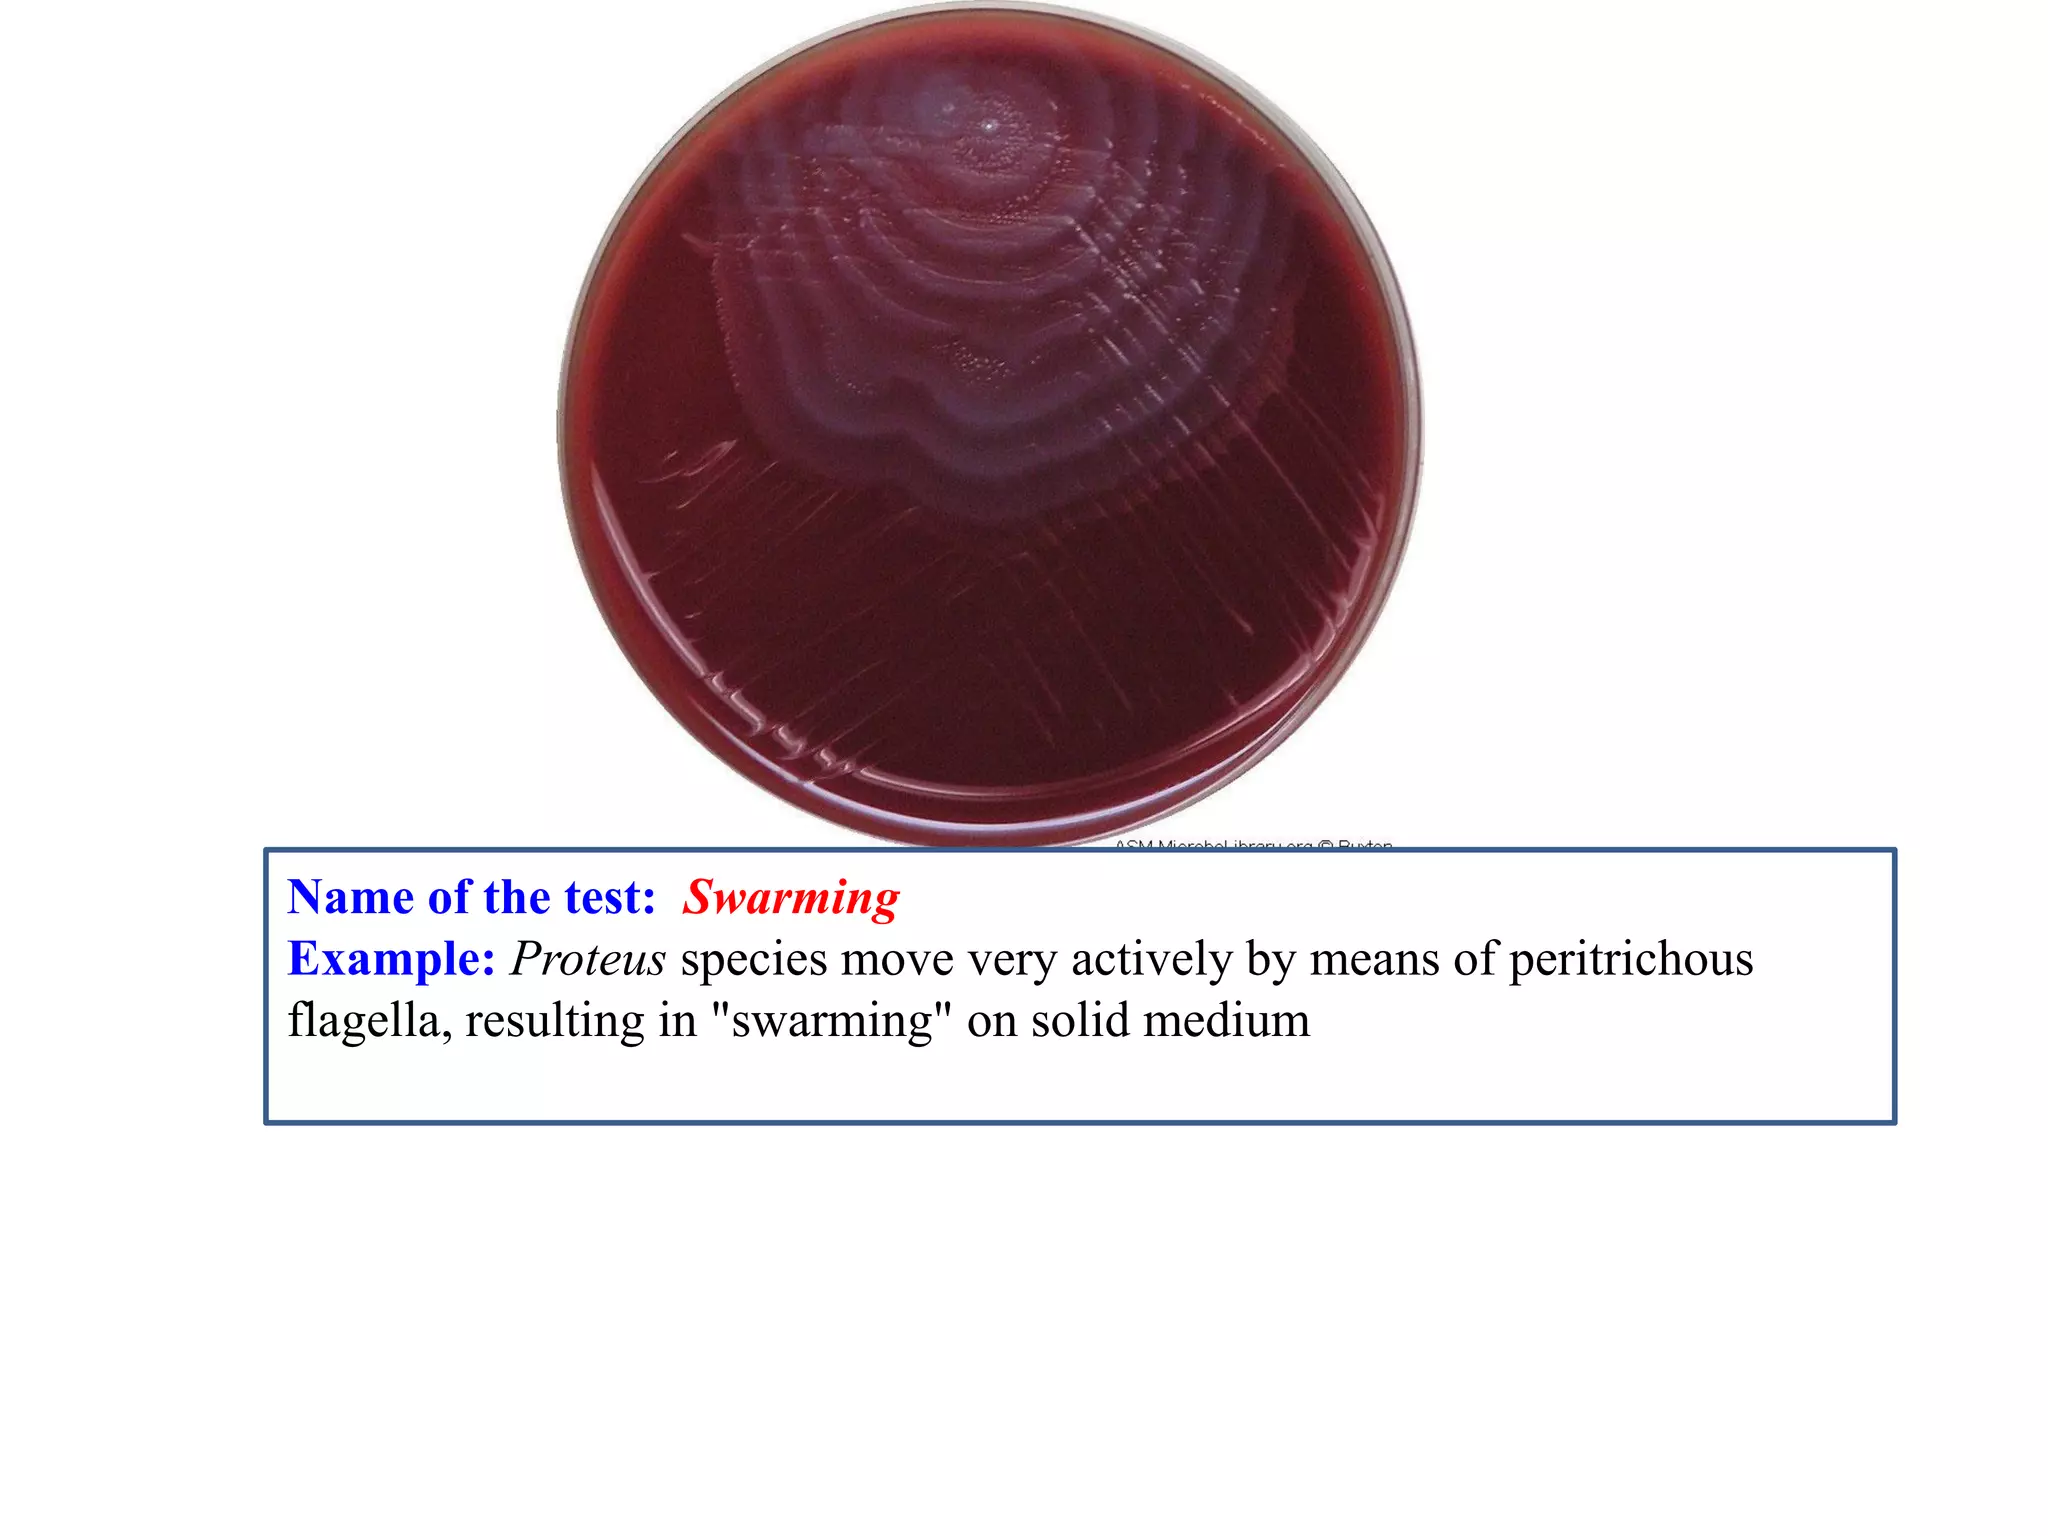
Name of the test: Swarming 
Example: Proteus species move very actively by means of peritrichous flagella, resulting in "swarming" on solid medium
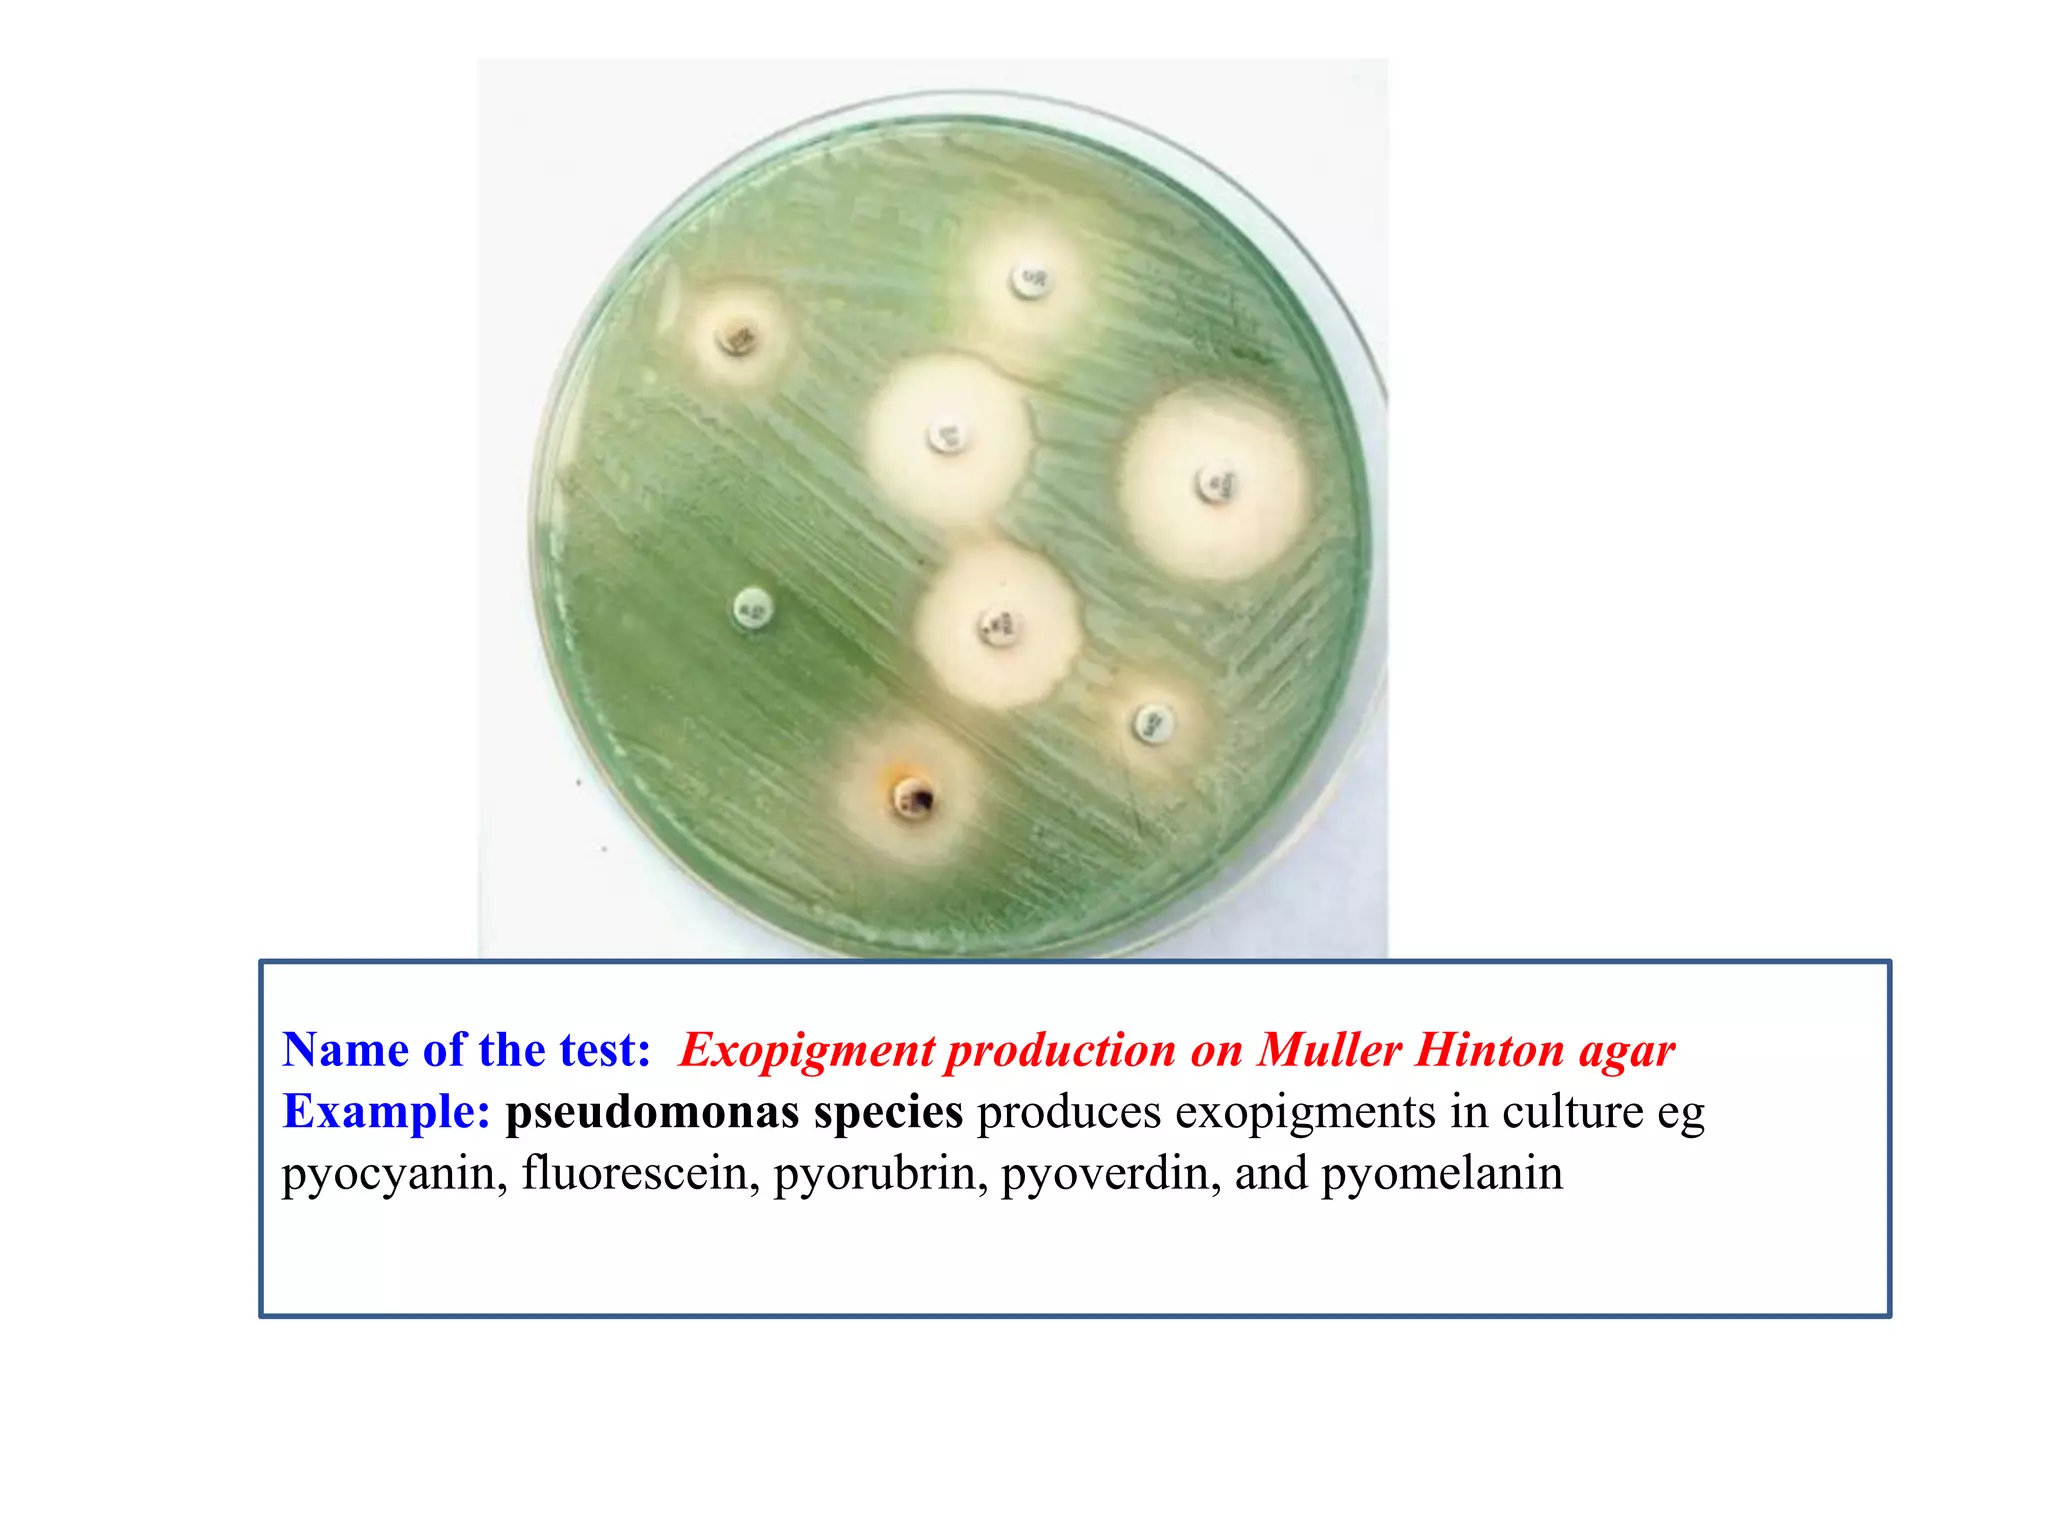
Name of the test: Exopigment production on Muller Hinton agar 
Example: pseudomonas species produces exopigments in culture eg pyocyanin, fluorescein, pyorubrin, pyoverdin, and pyomelanin
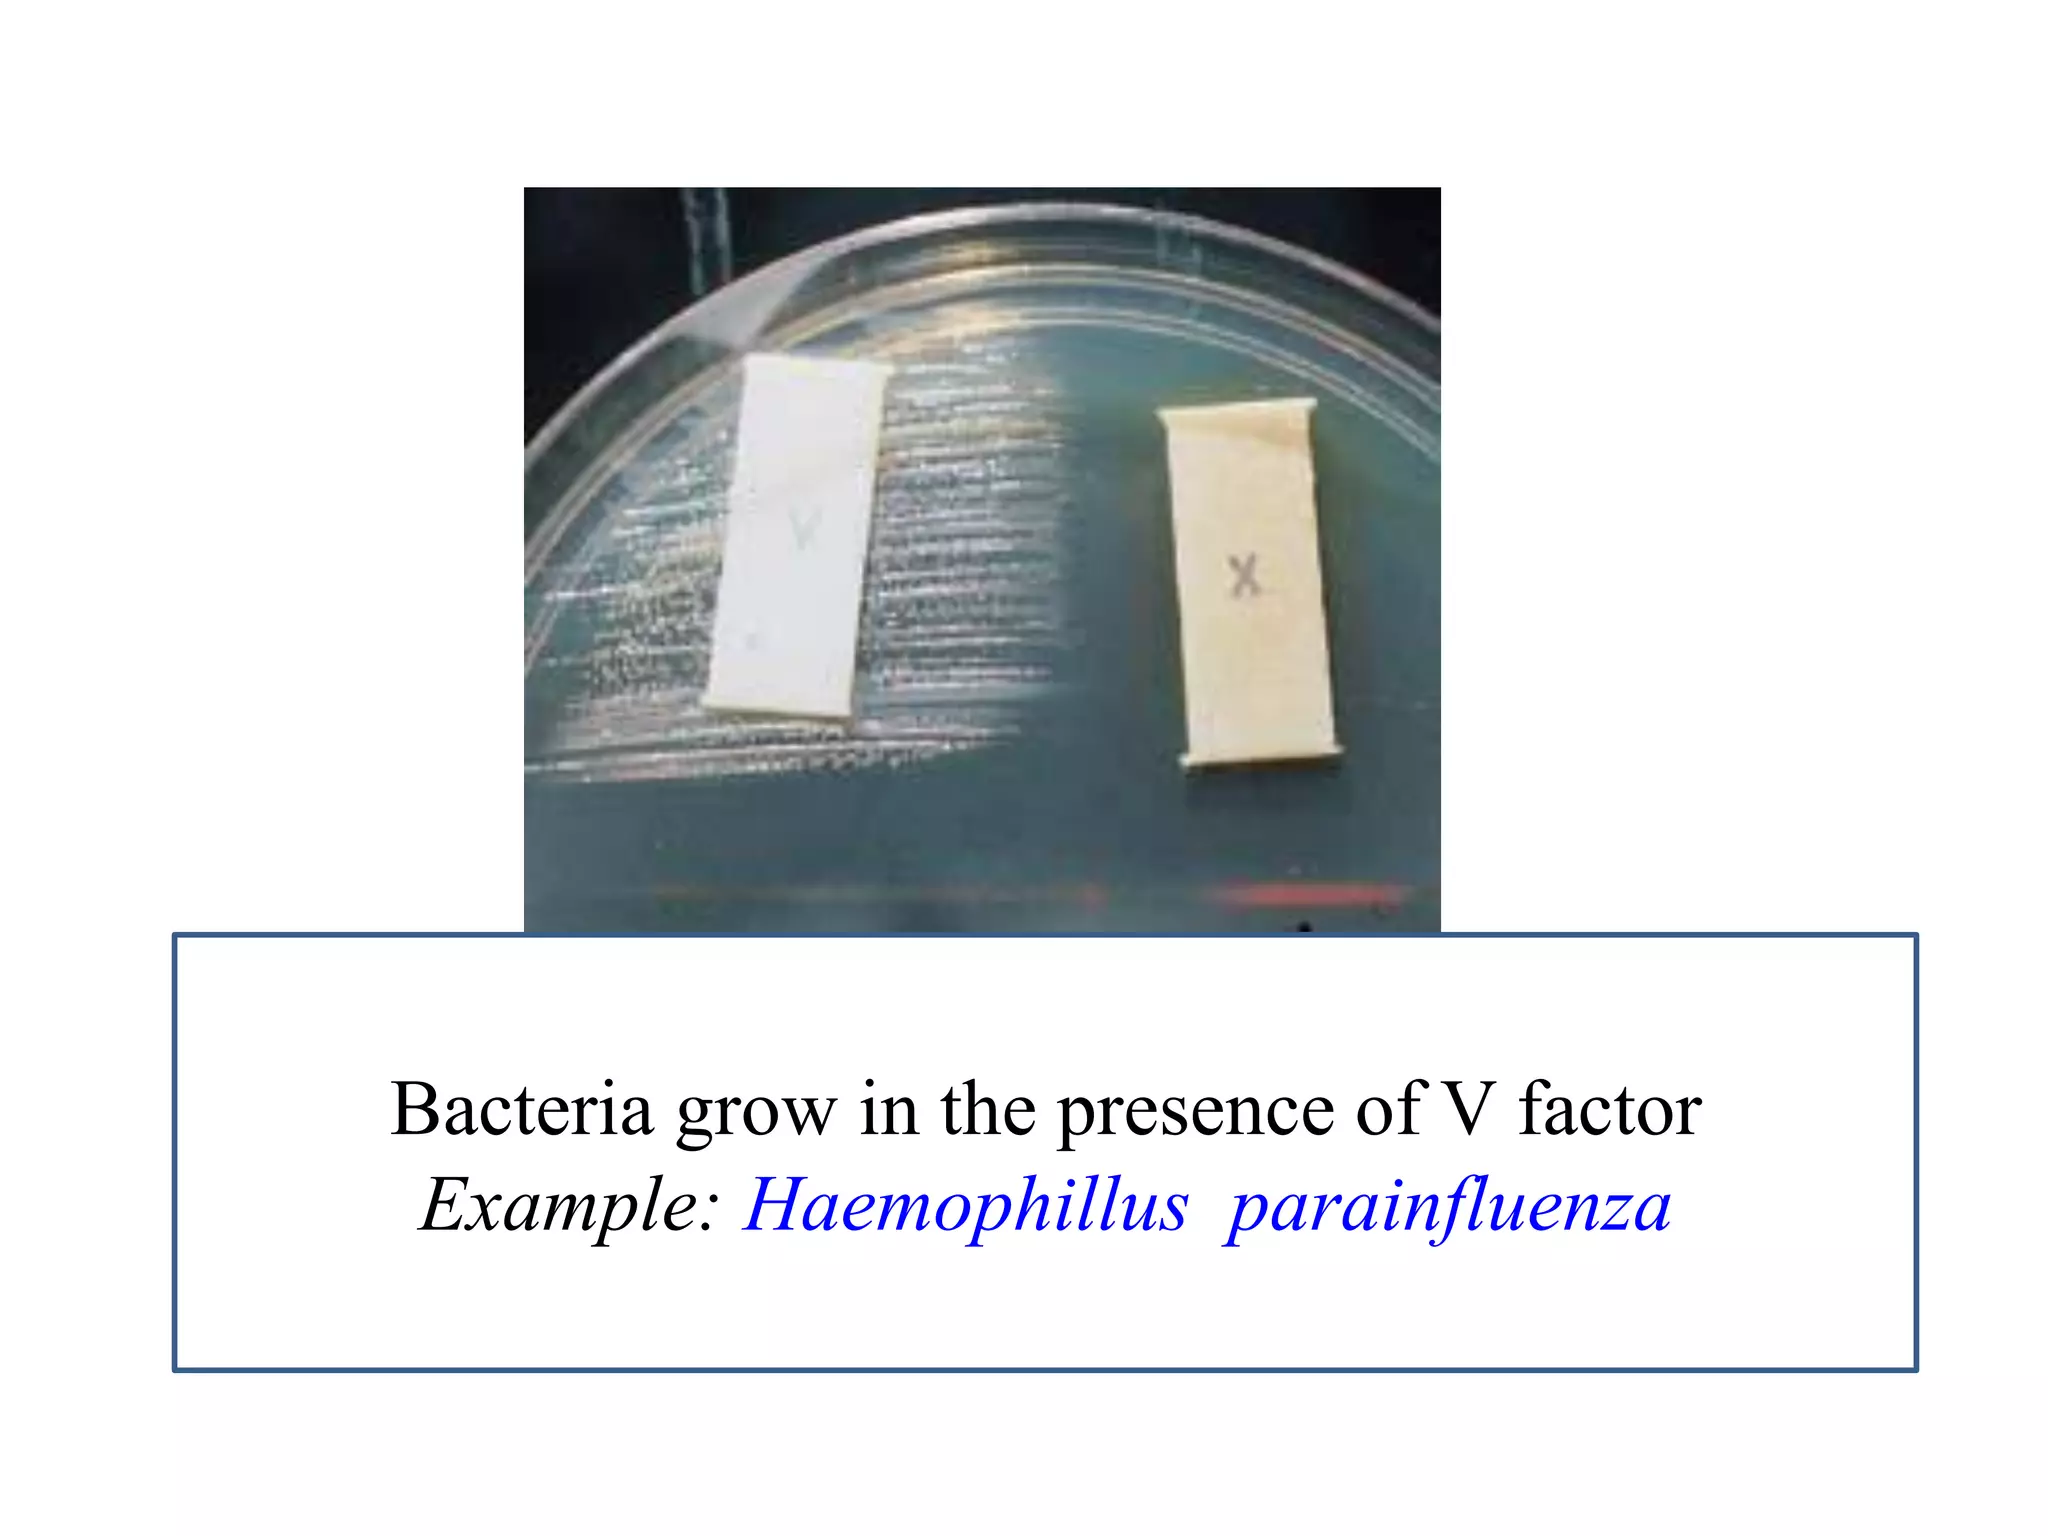
Bacteria grow in the presence of V factor 
Example: Haemophillus parainfluenza
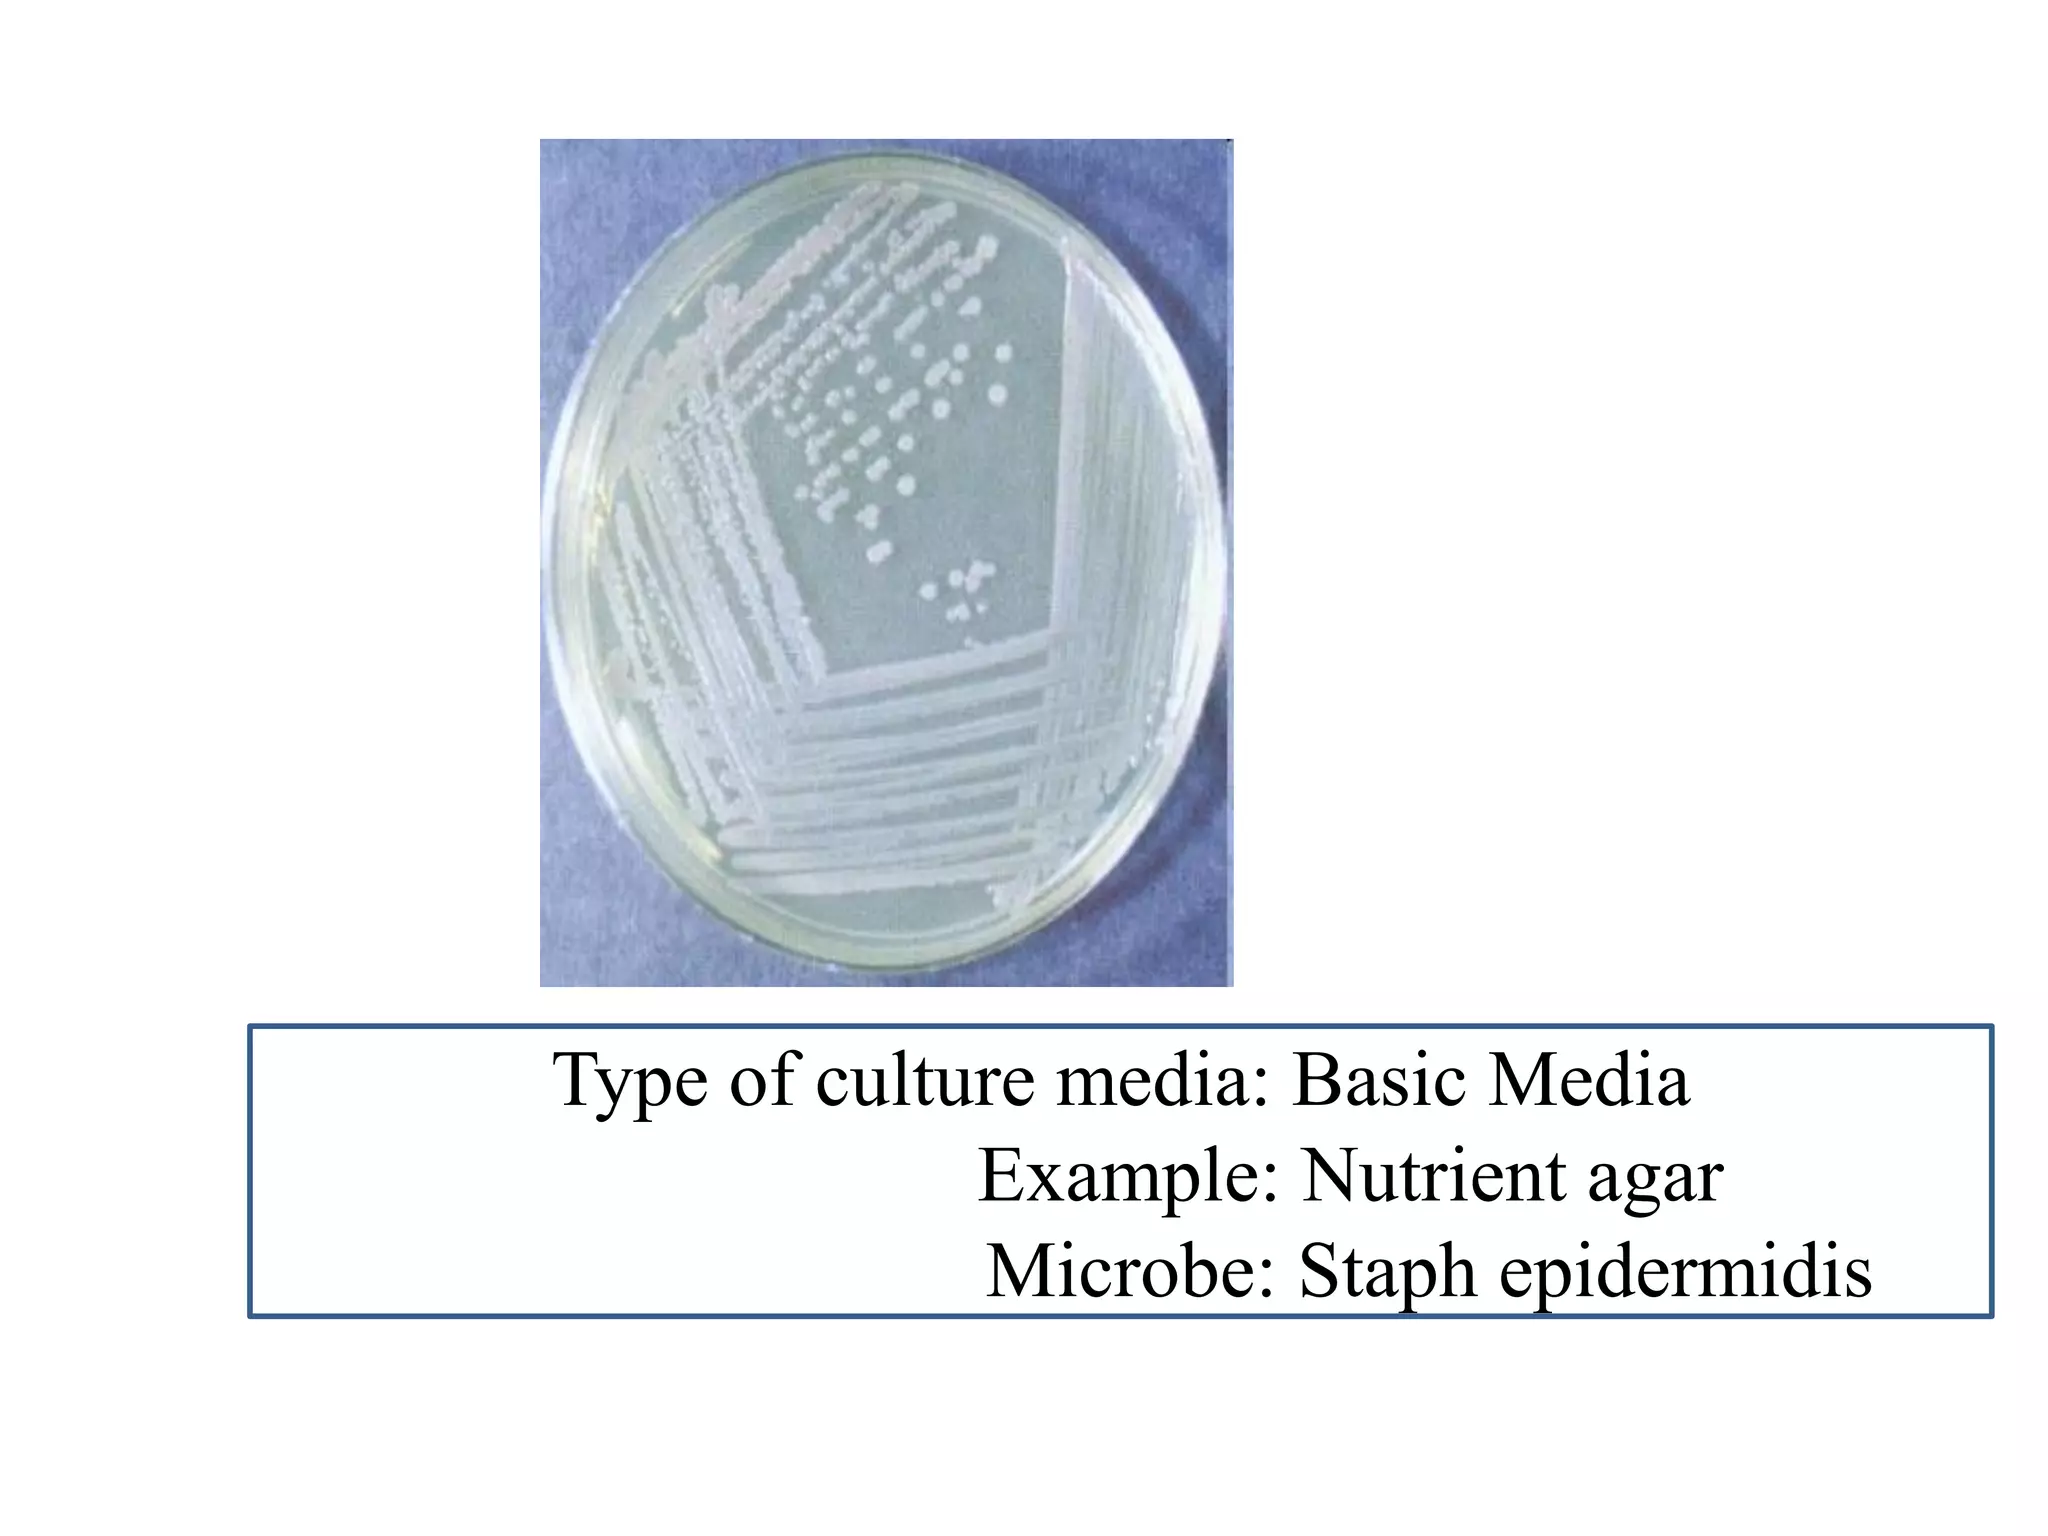
Type of culture media: Basic Media 
Example: Nutrient agar 
Microbe: Staph epidermidis
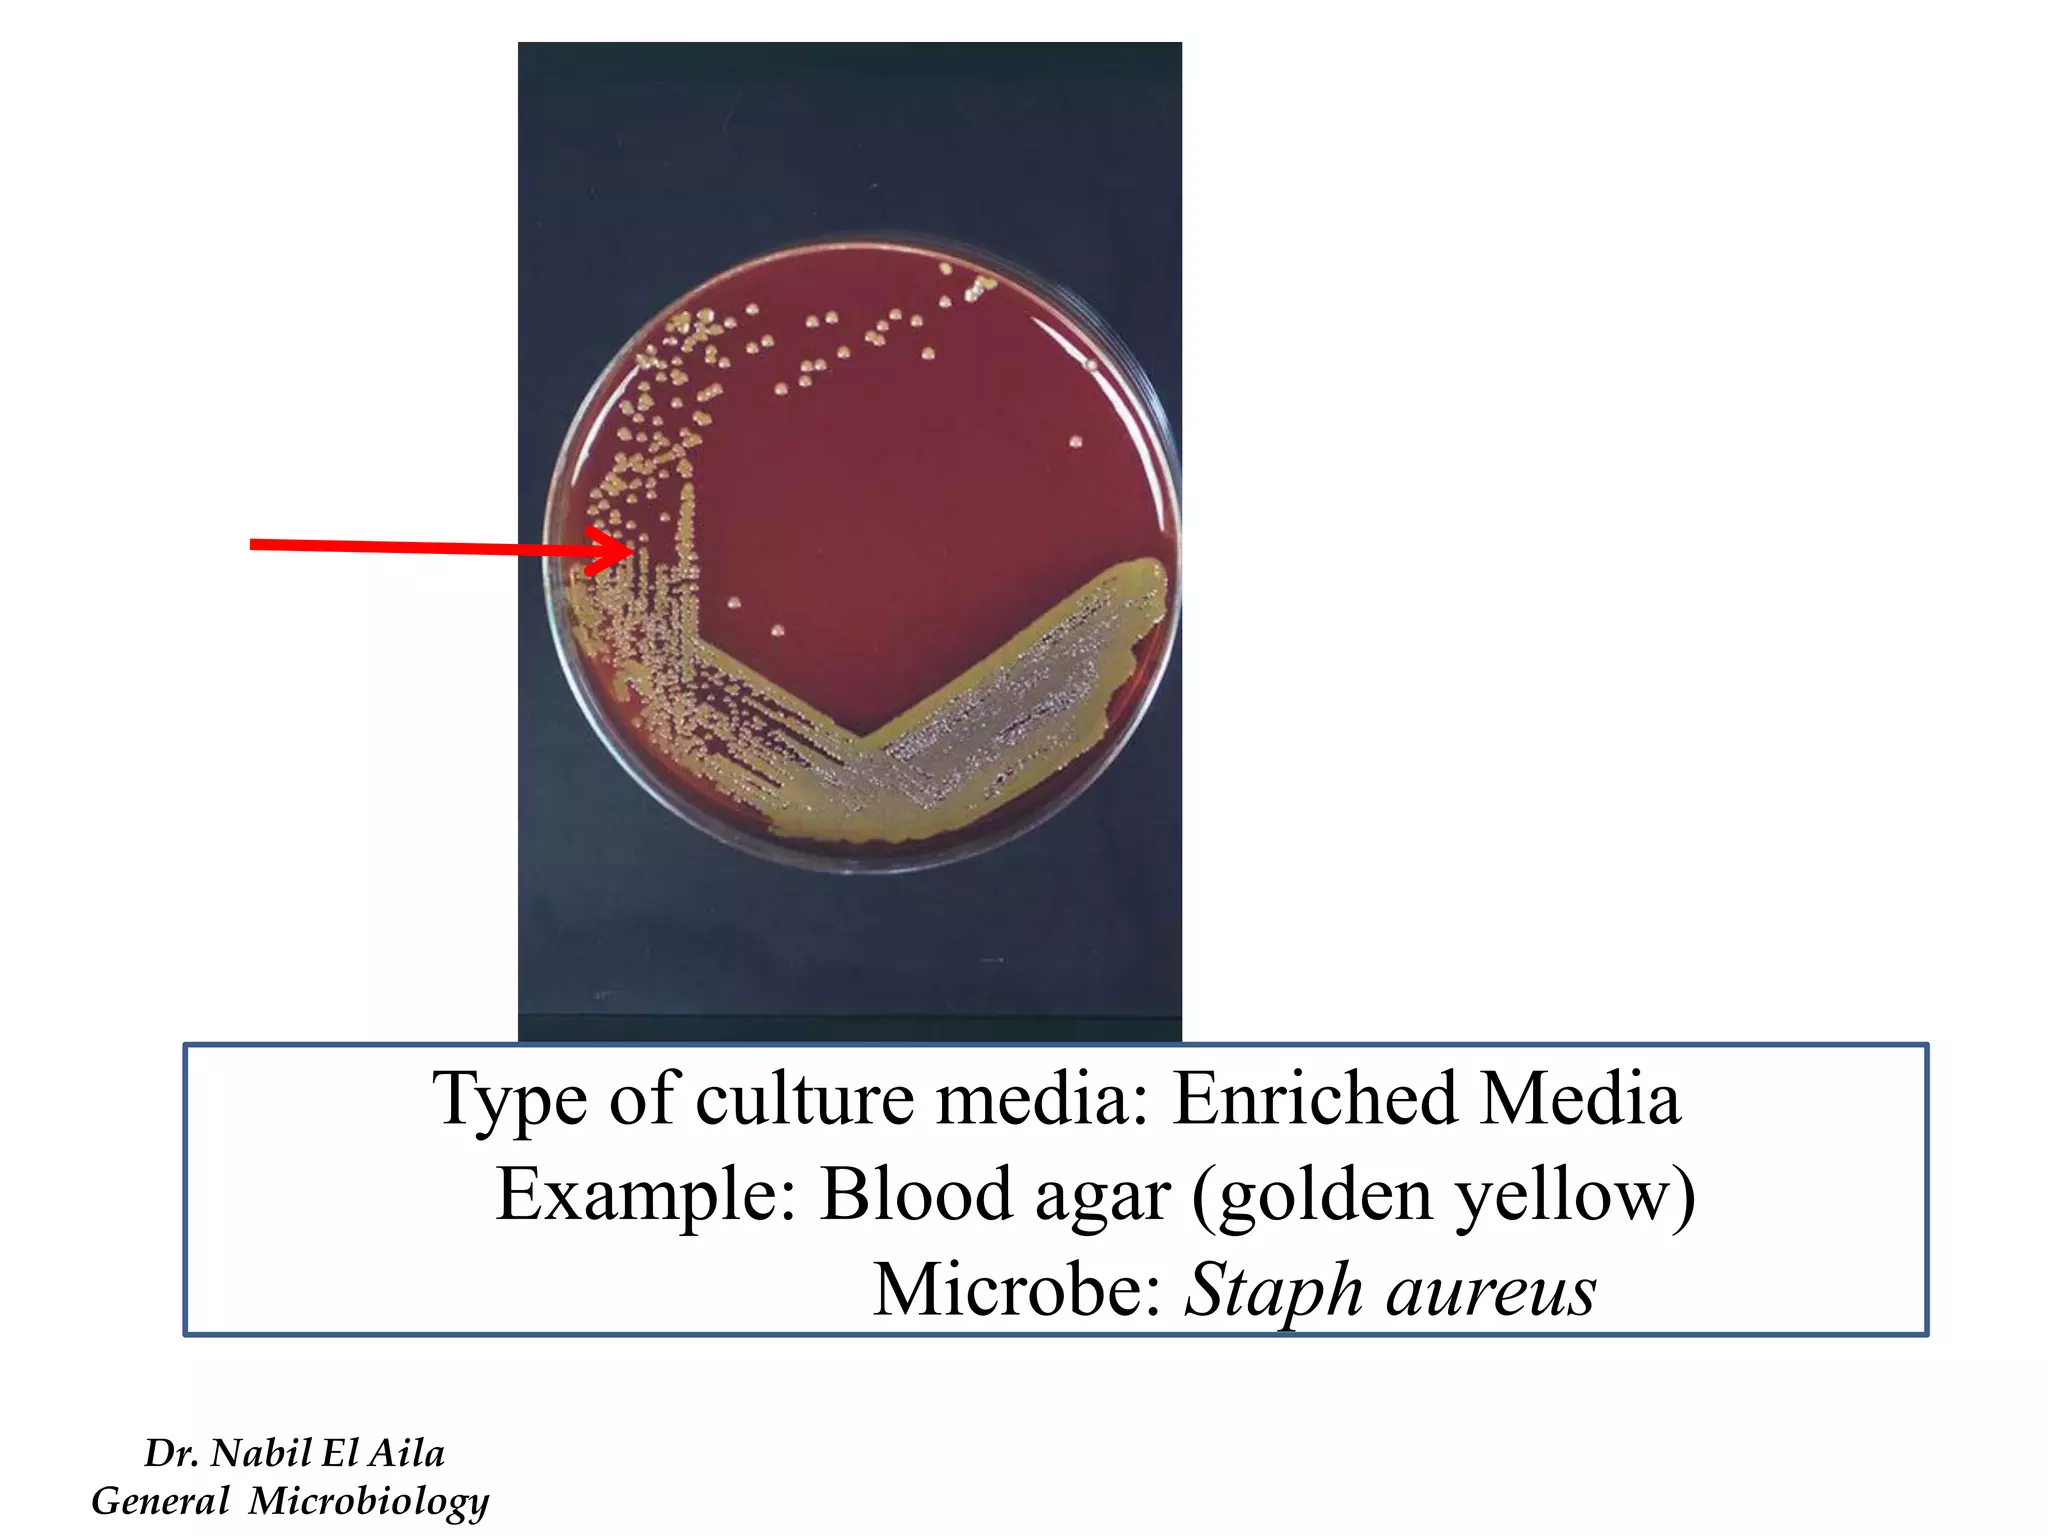
Type of culture media: Enriched Media 
Example: Blood agar (golden yellow) 
Microbe: Staph aureus 
Dr. Nabil El Aila 
General Microbiology
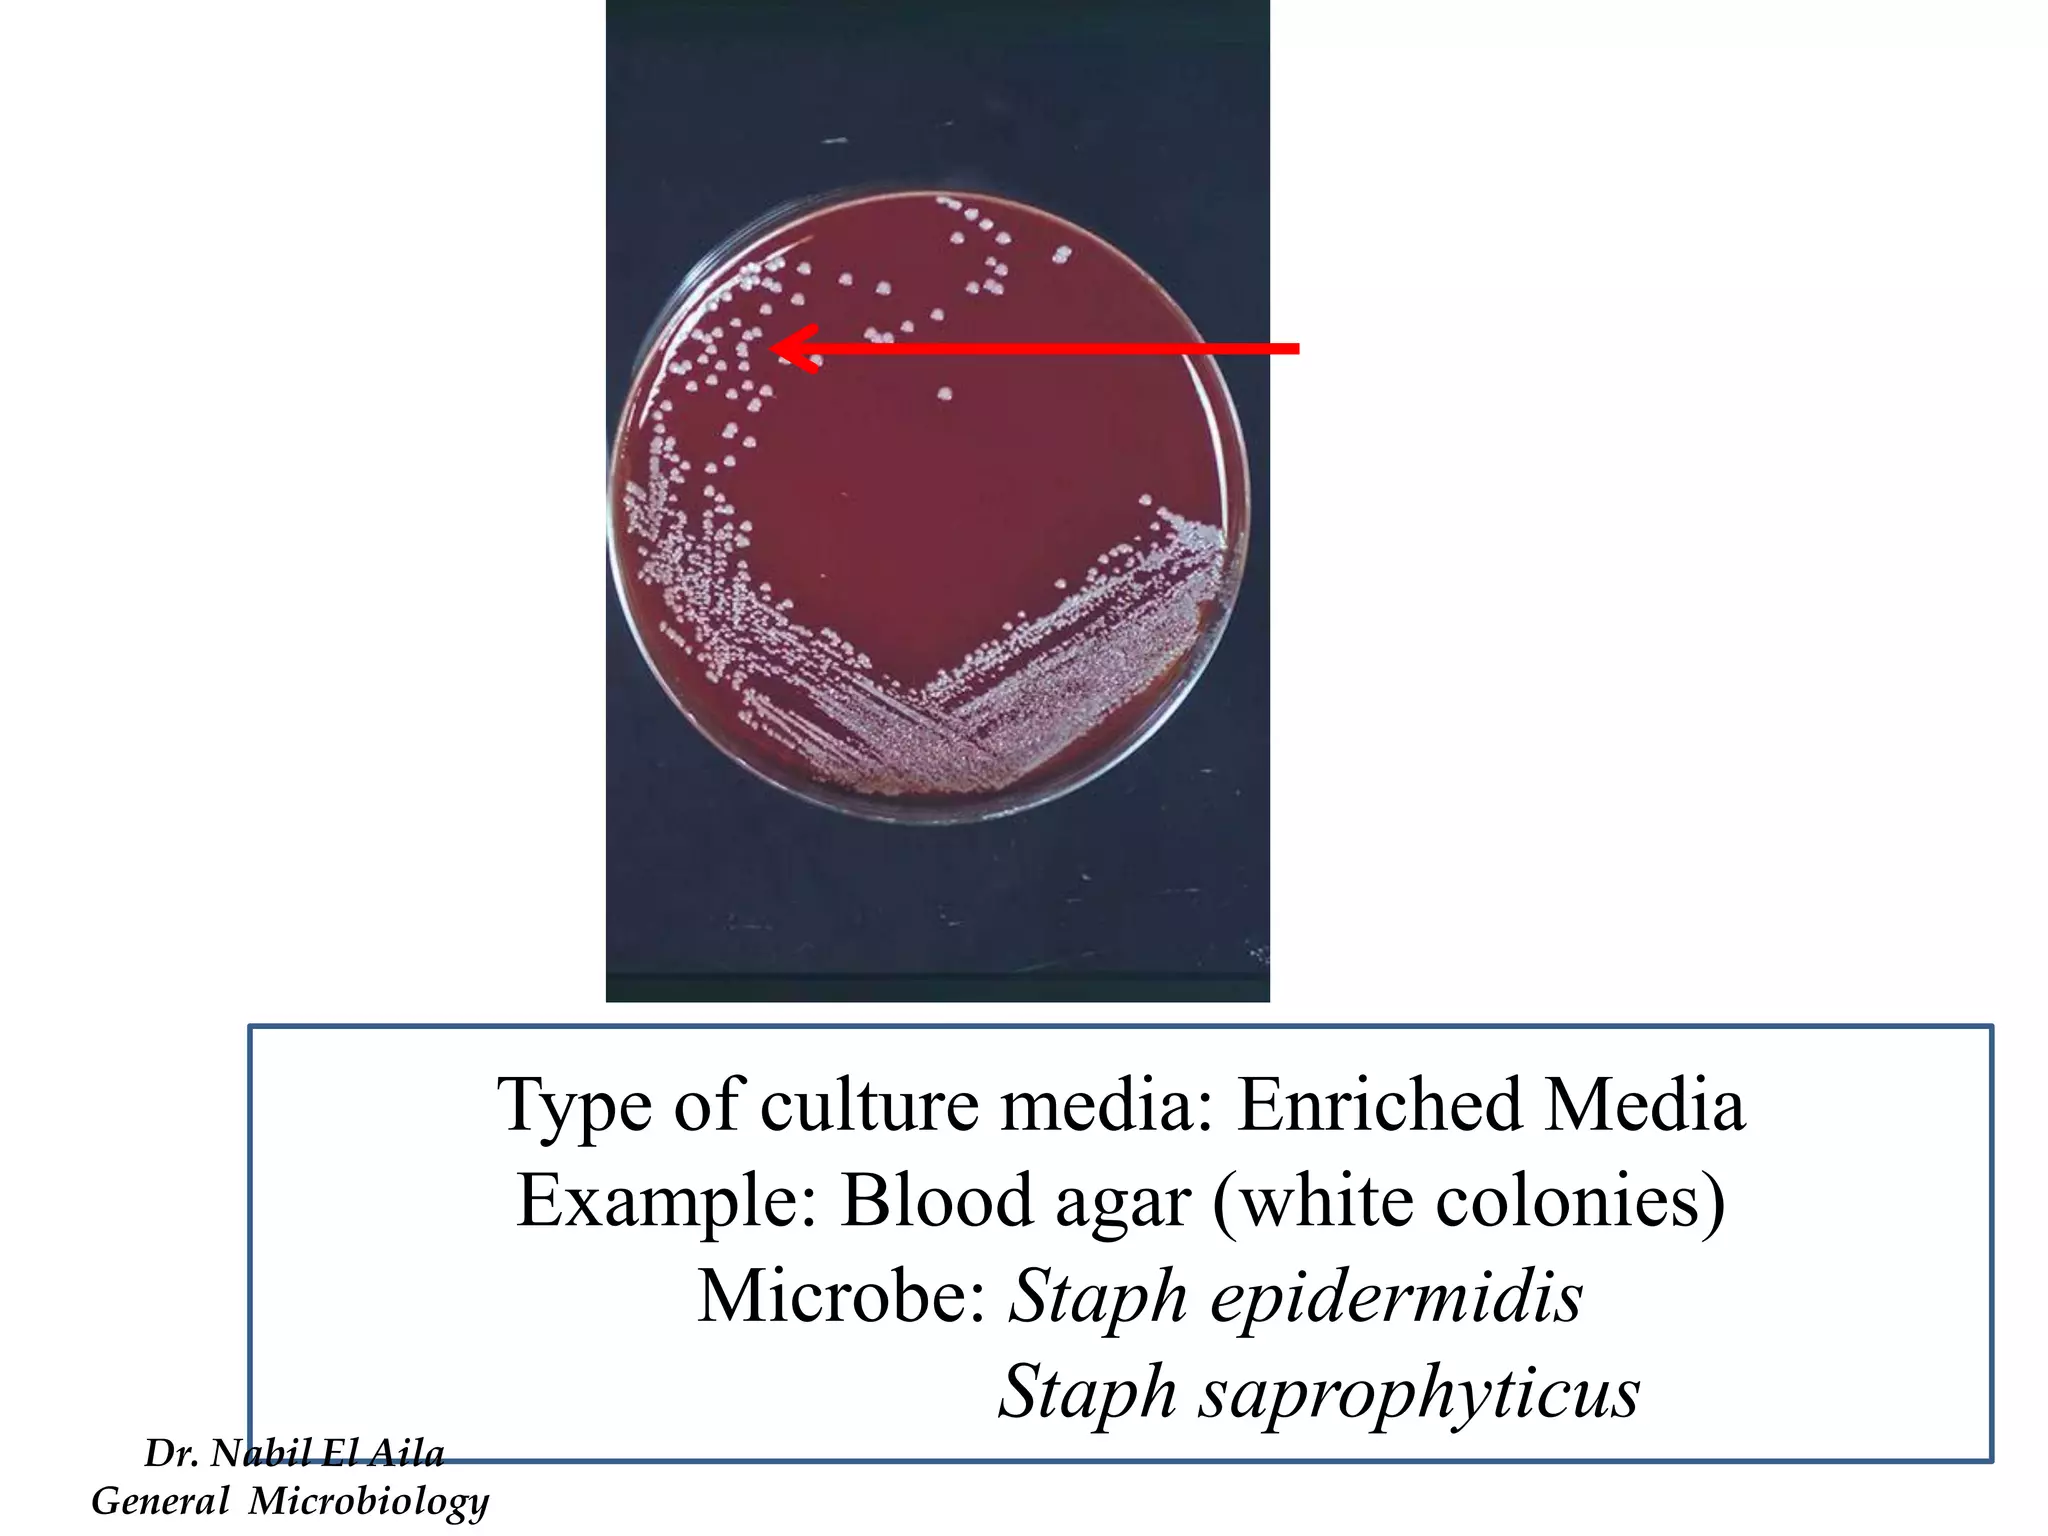
Type of culture media: Enriched Media 
Example: Blood agar (white colonies) 
Microbe: Staph epidermidis 
Staph saprophyticus 
Dr. Nabil El Aila 
General Microbiology
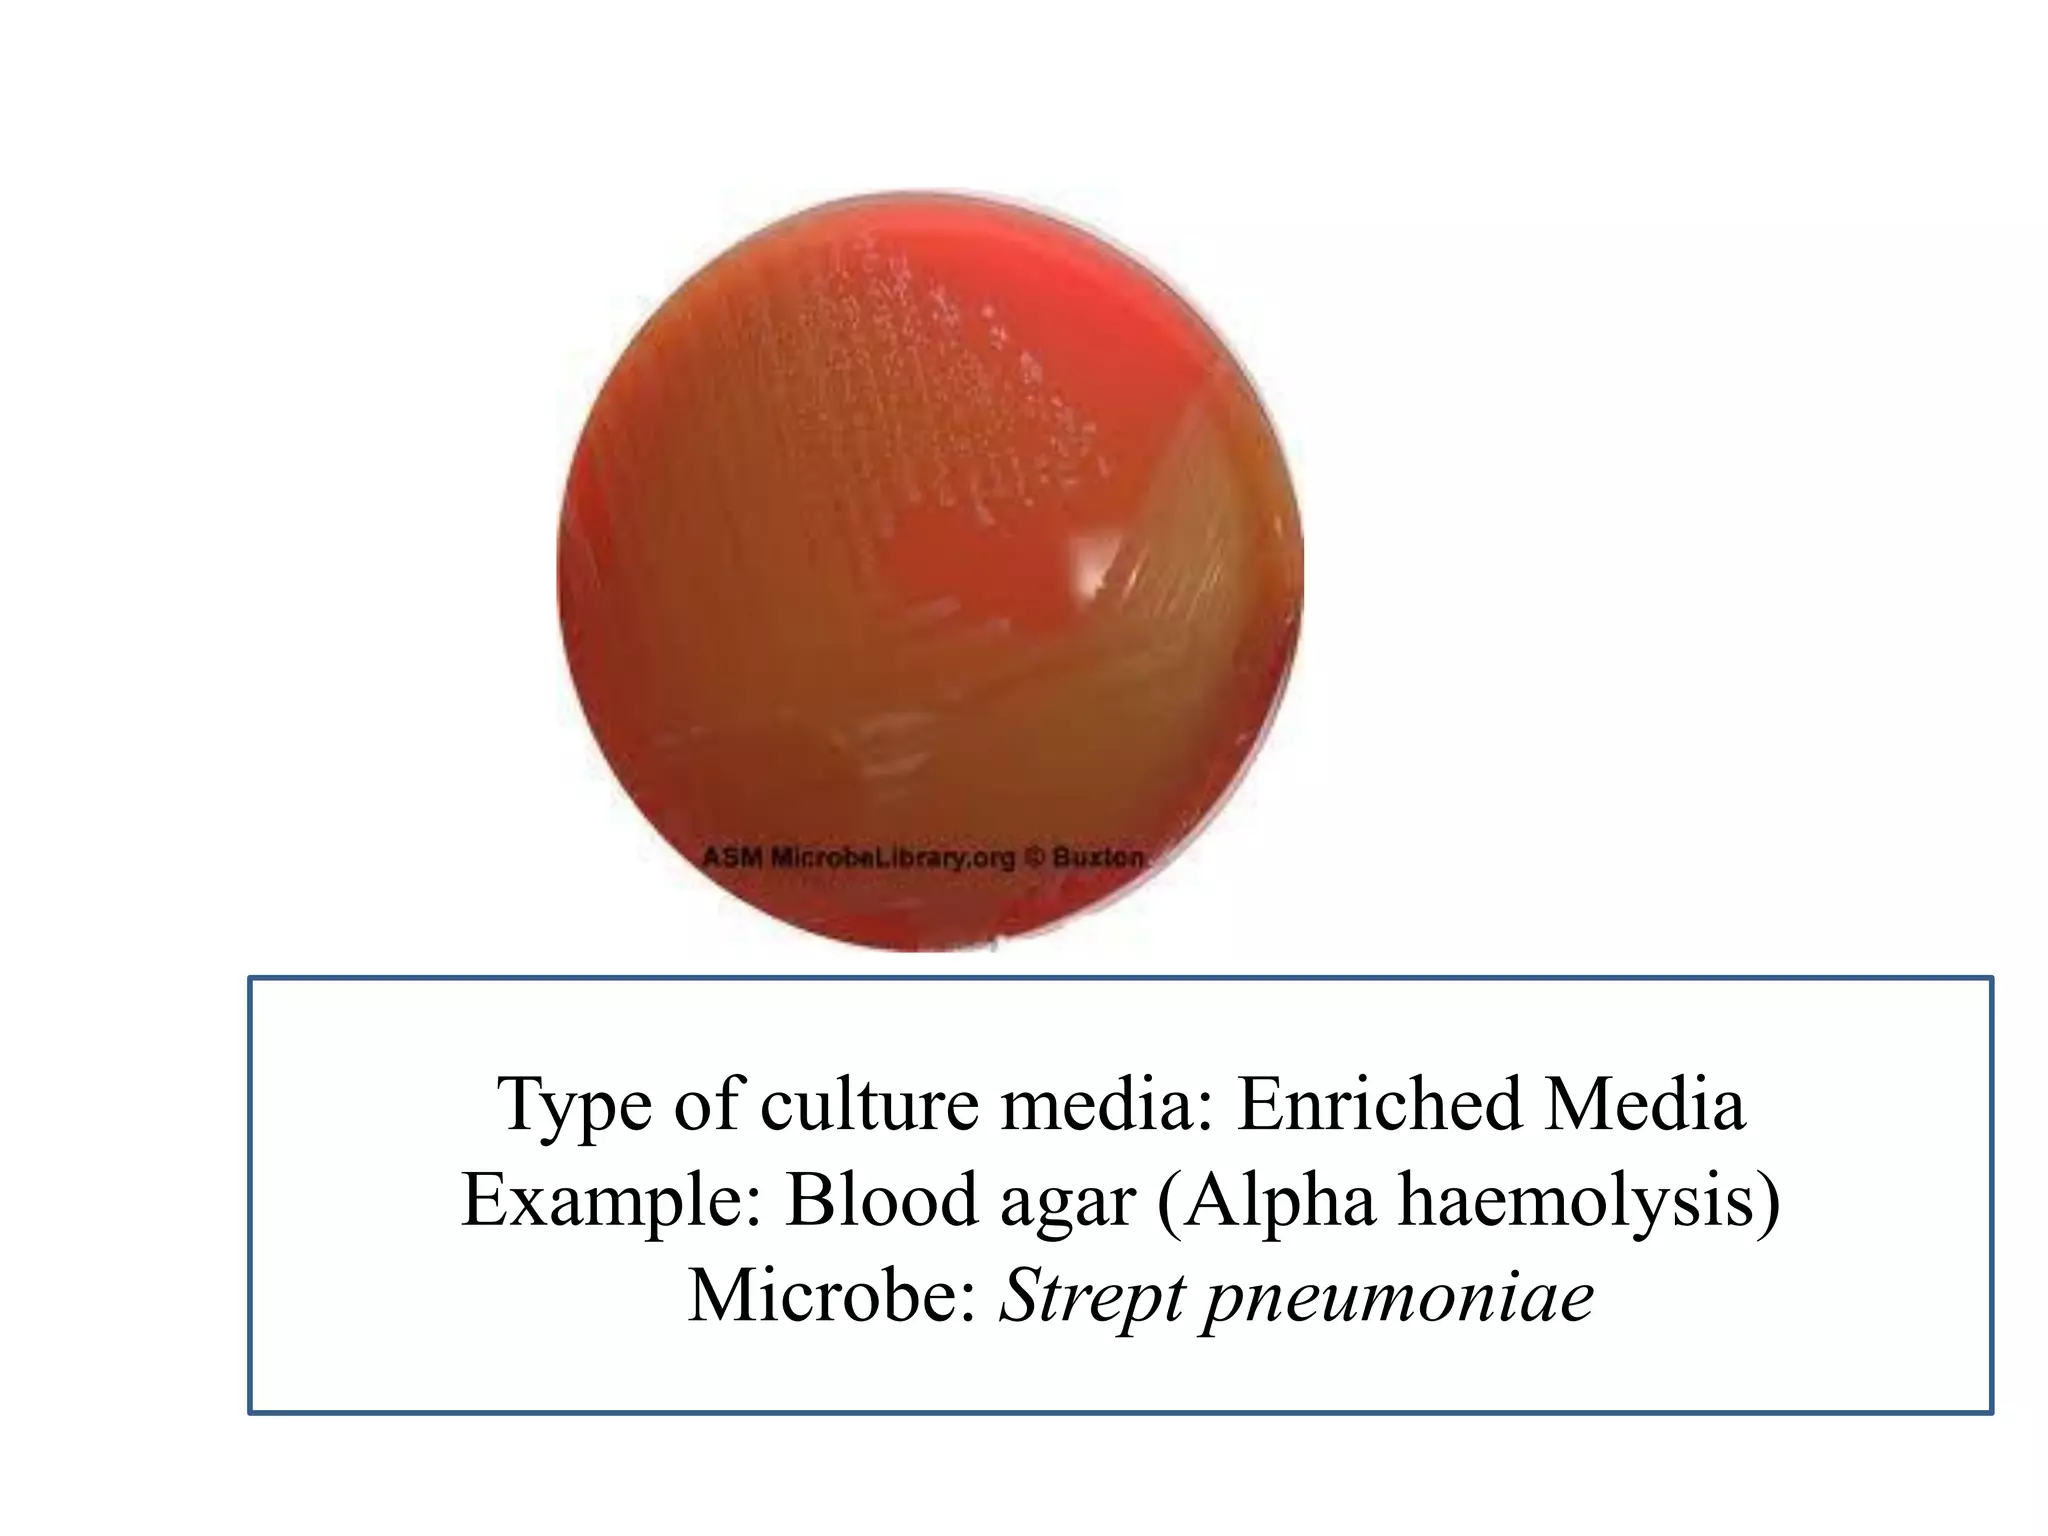
Type of culture media: Enriched Media 
Example: Blood agar (Alpha haemolysis) 
Microbe: Strept pneumoniae
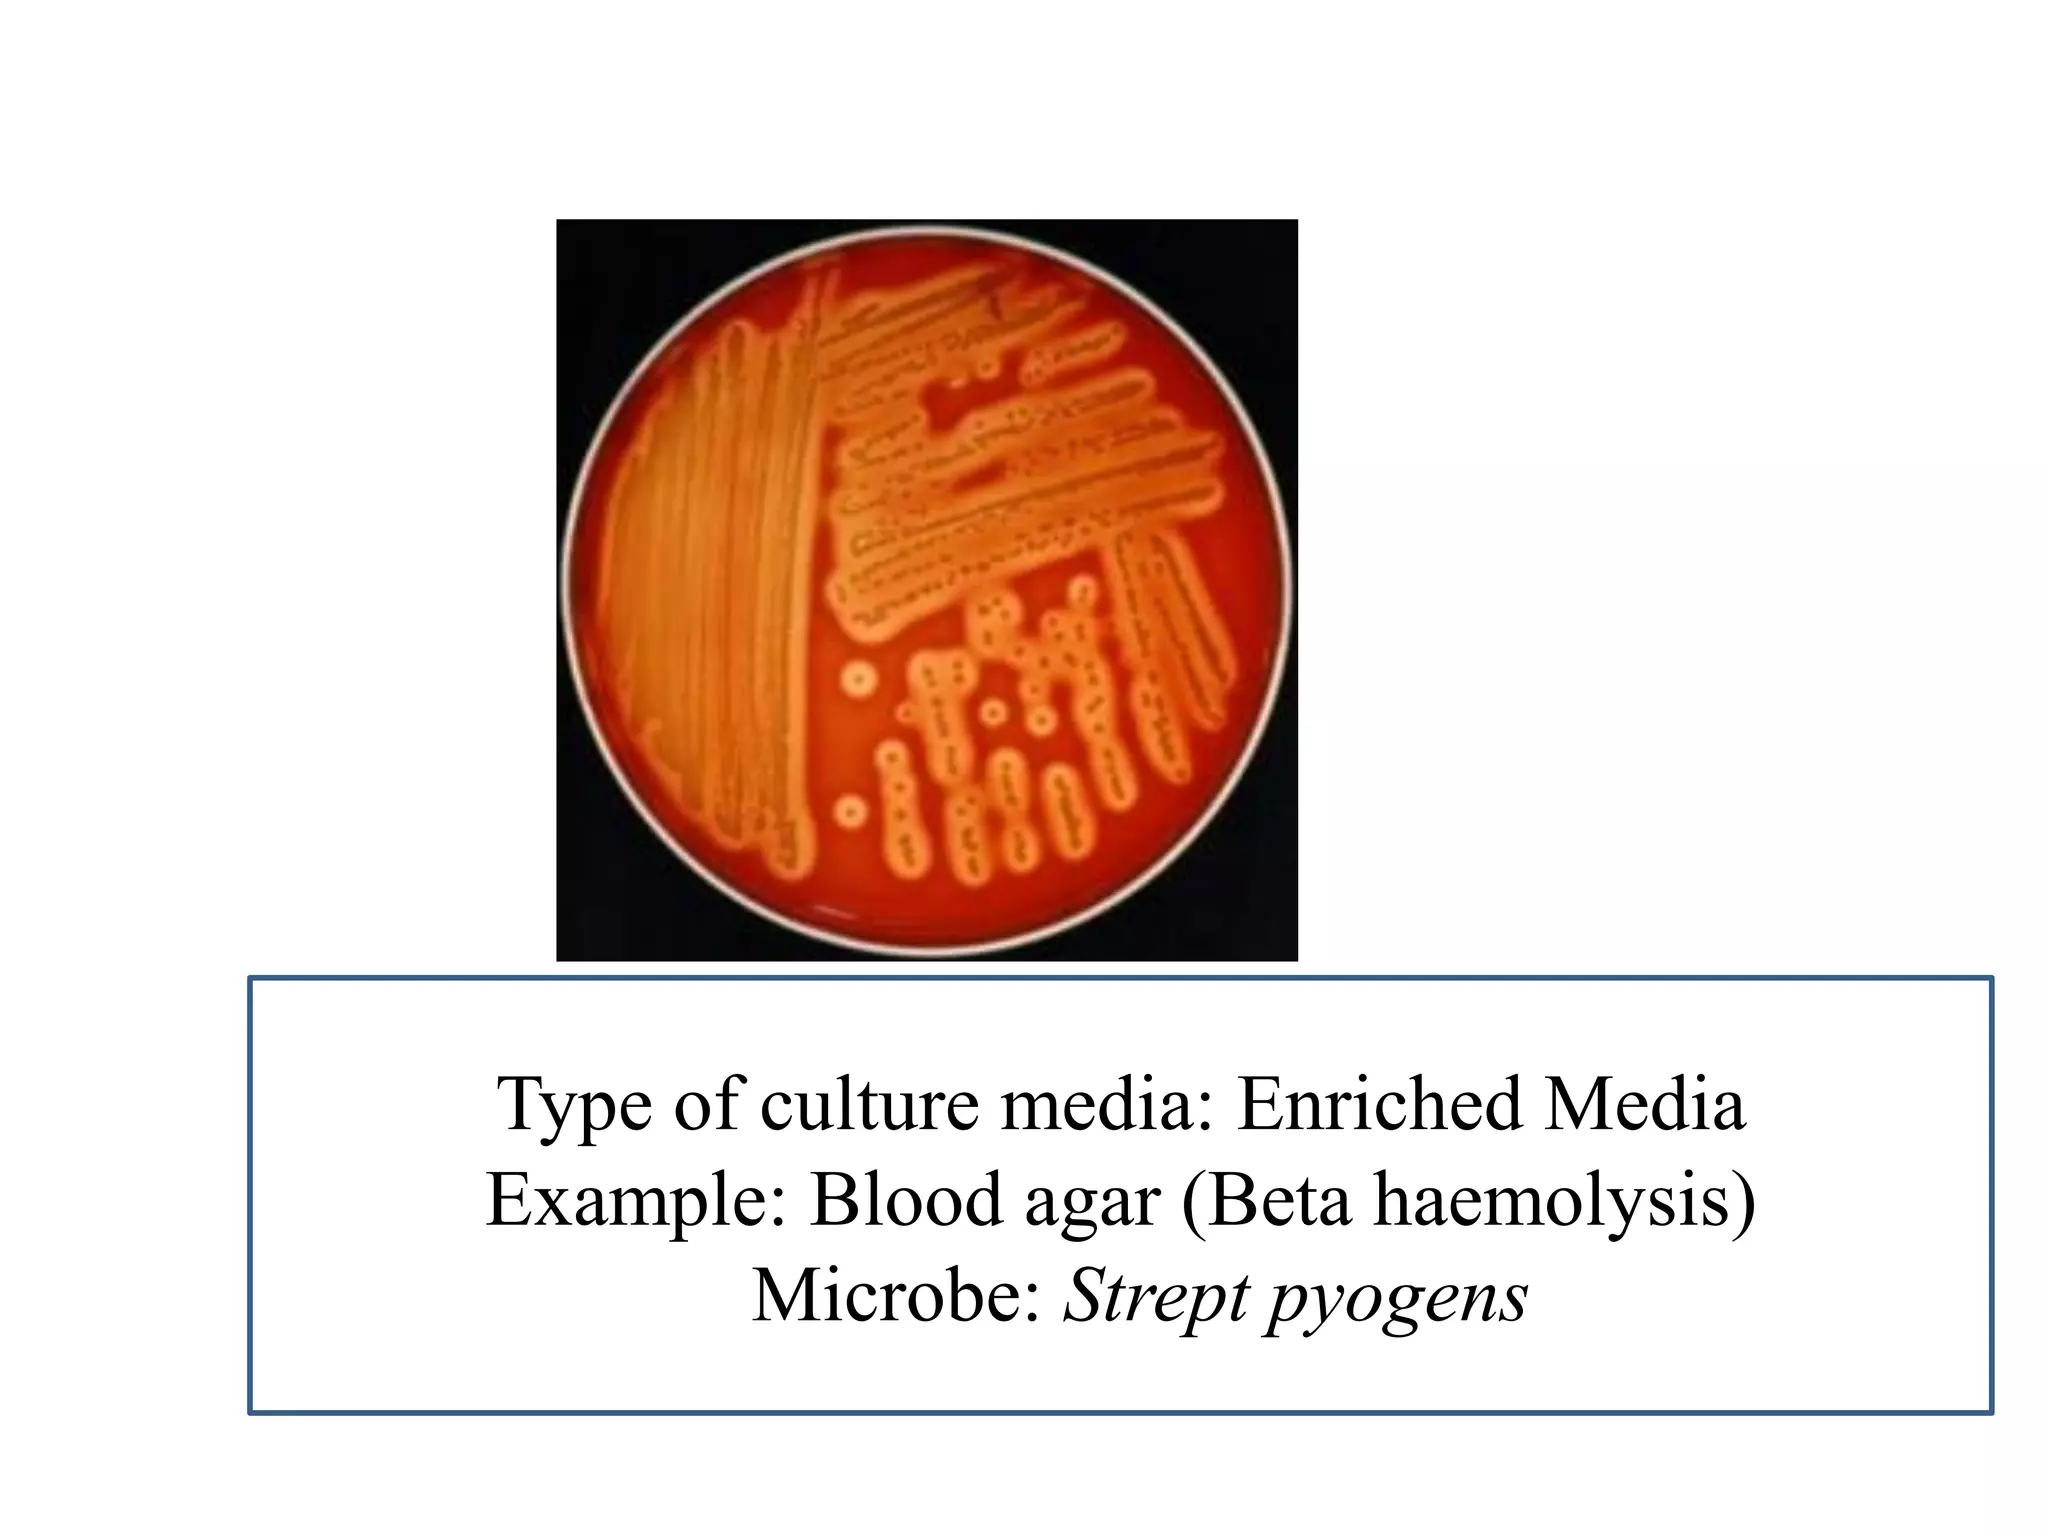
Type of culture media: Enriched Media 
Example: Blood agar (Beta haemolysis) 
Microbe: Strept pyogens
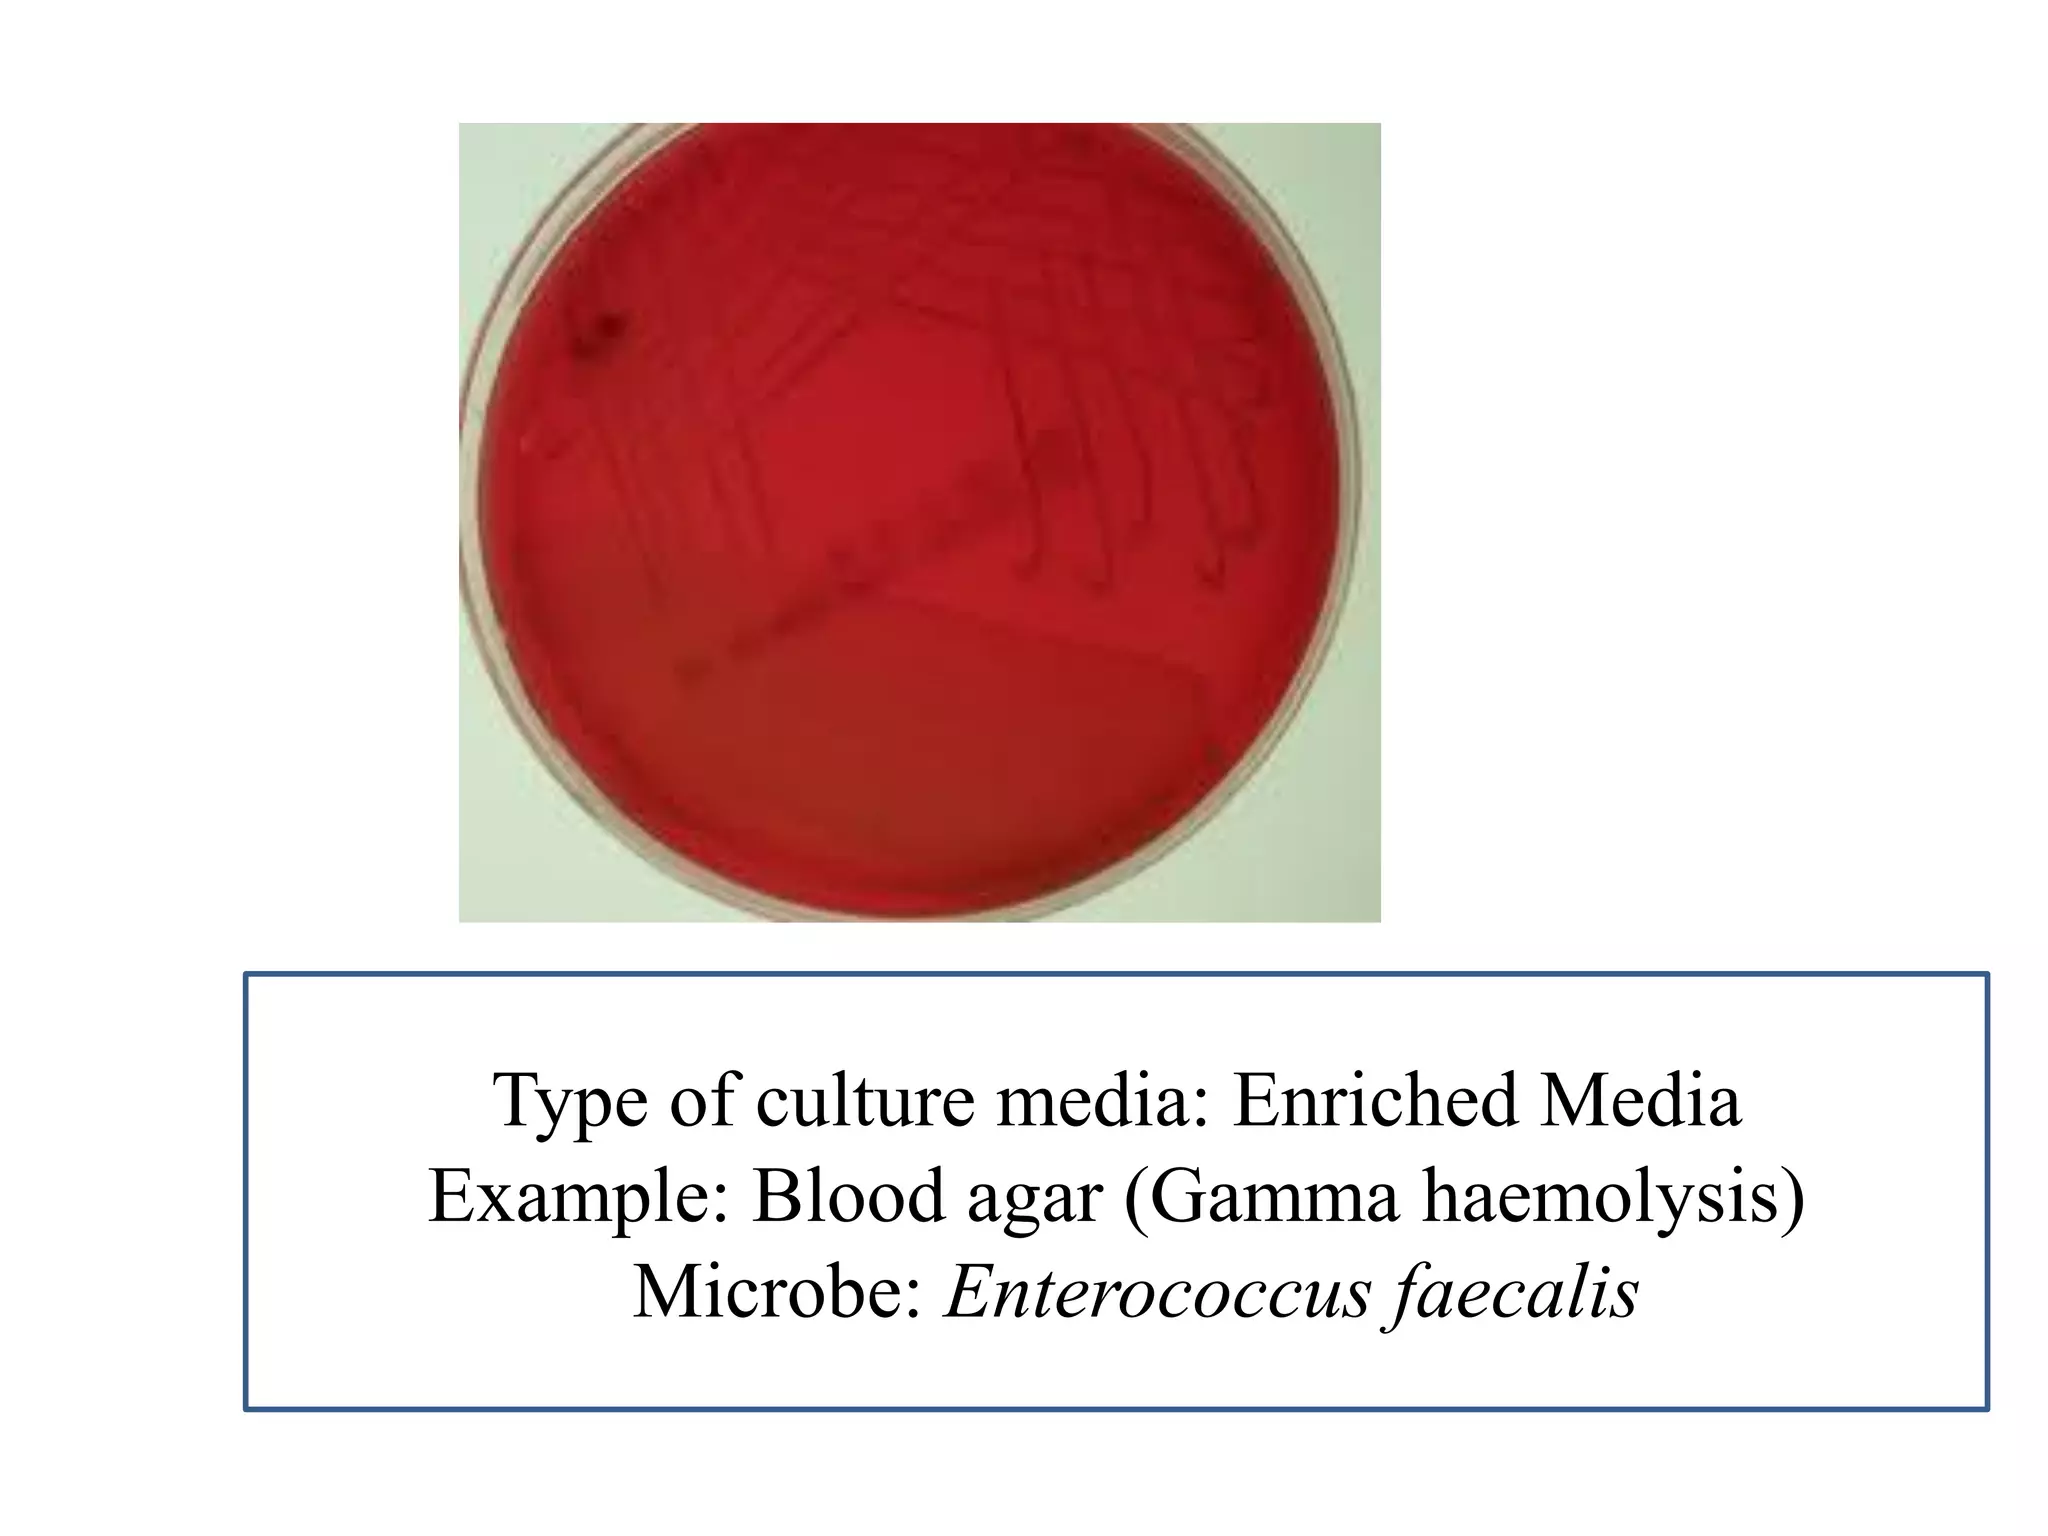
Type of culture media: Enriched Media 
Example: Blood agar (Gamma haemolysis) 
Microbe: Enterococcus faecalis
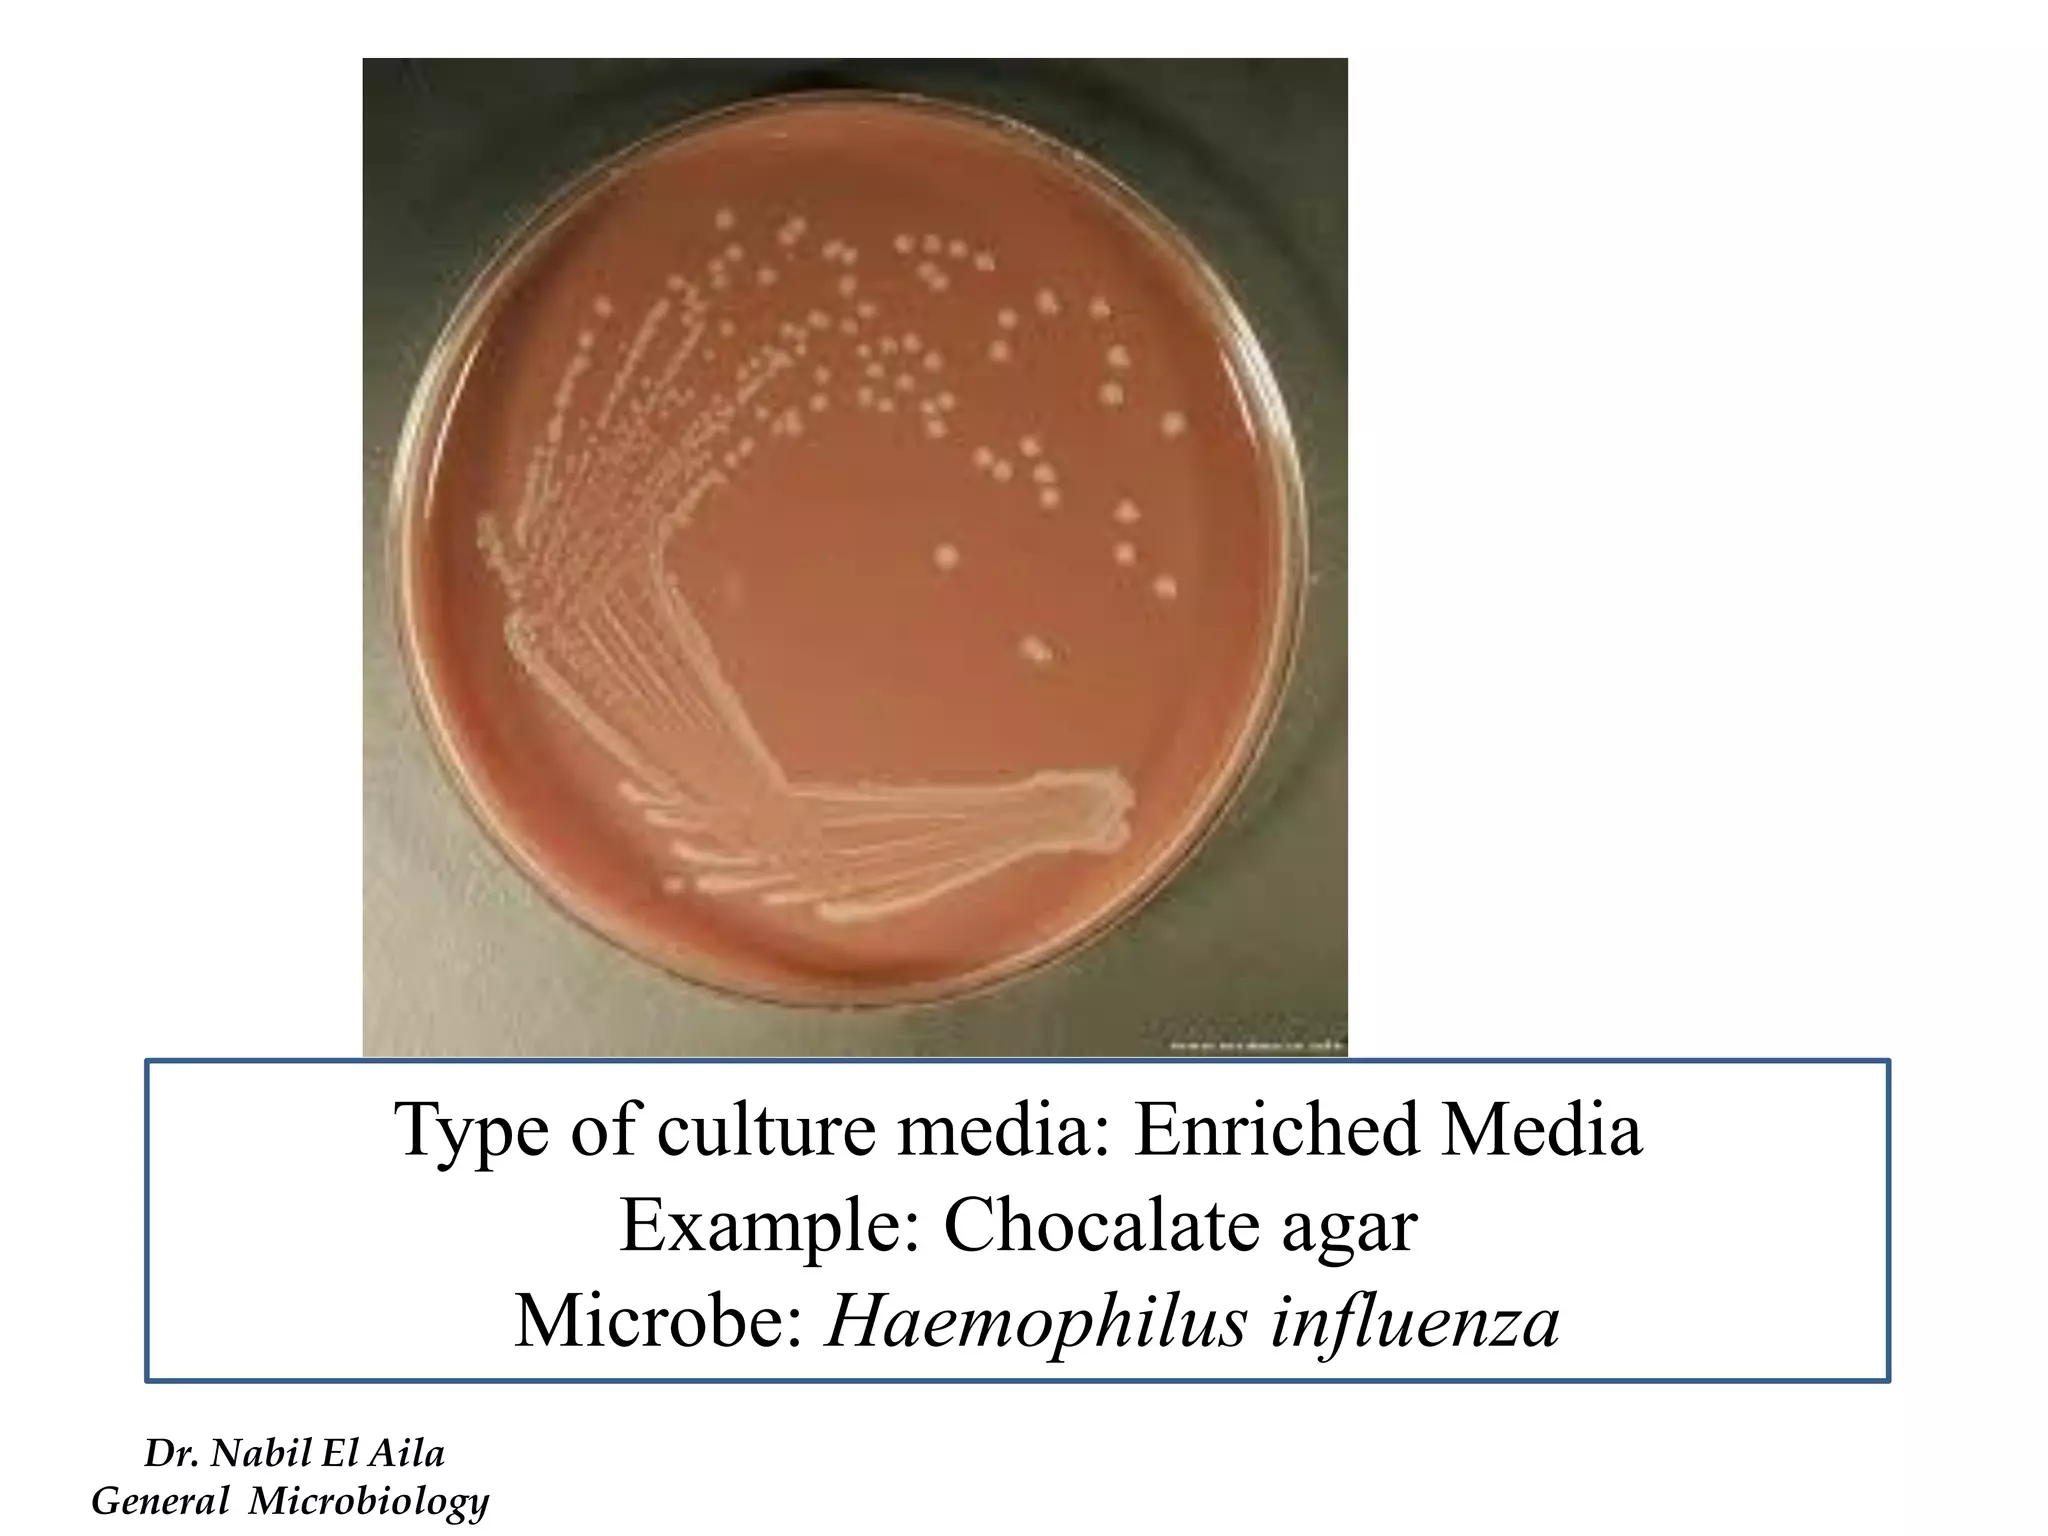
Type of culture media: Enriched Media 
Example: Chocalate agar 
Microbe: Haemophilus influenza 
Dr. Nabil El Aila 
General Microbiology
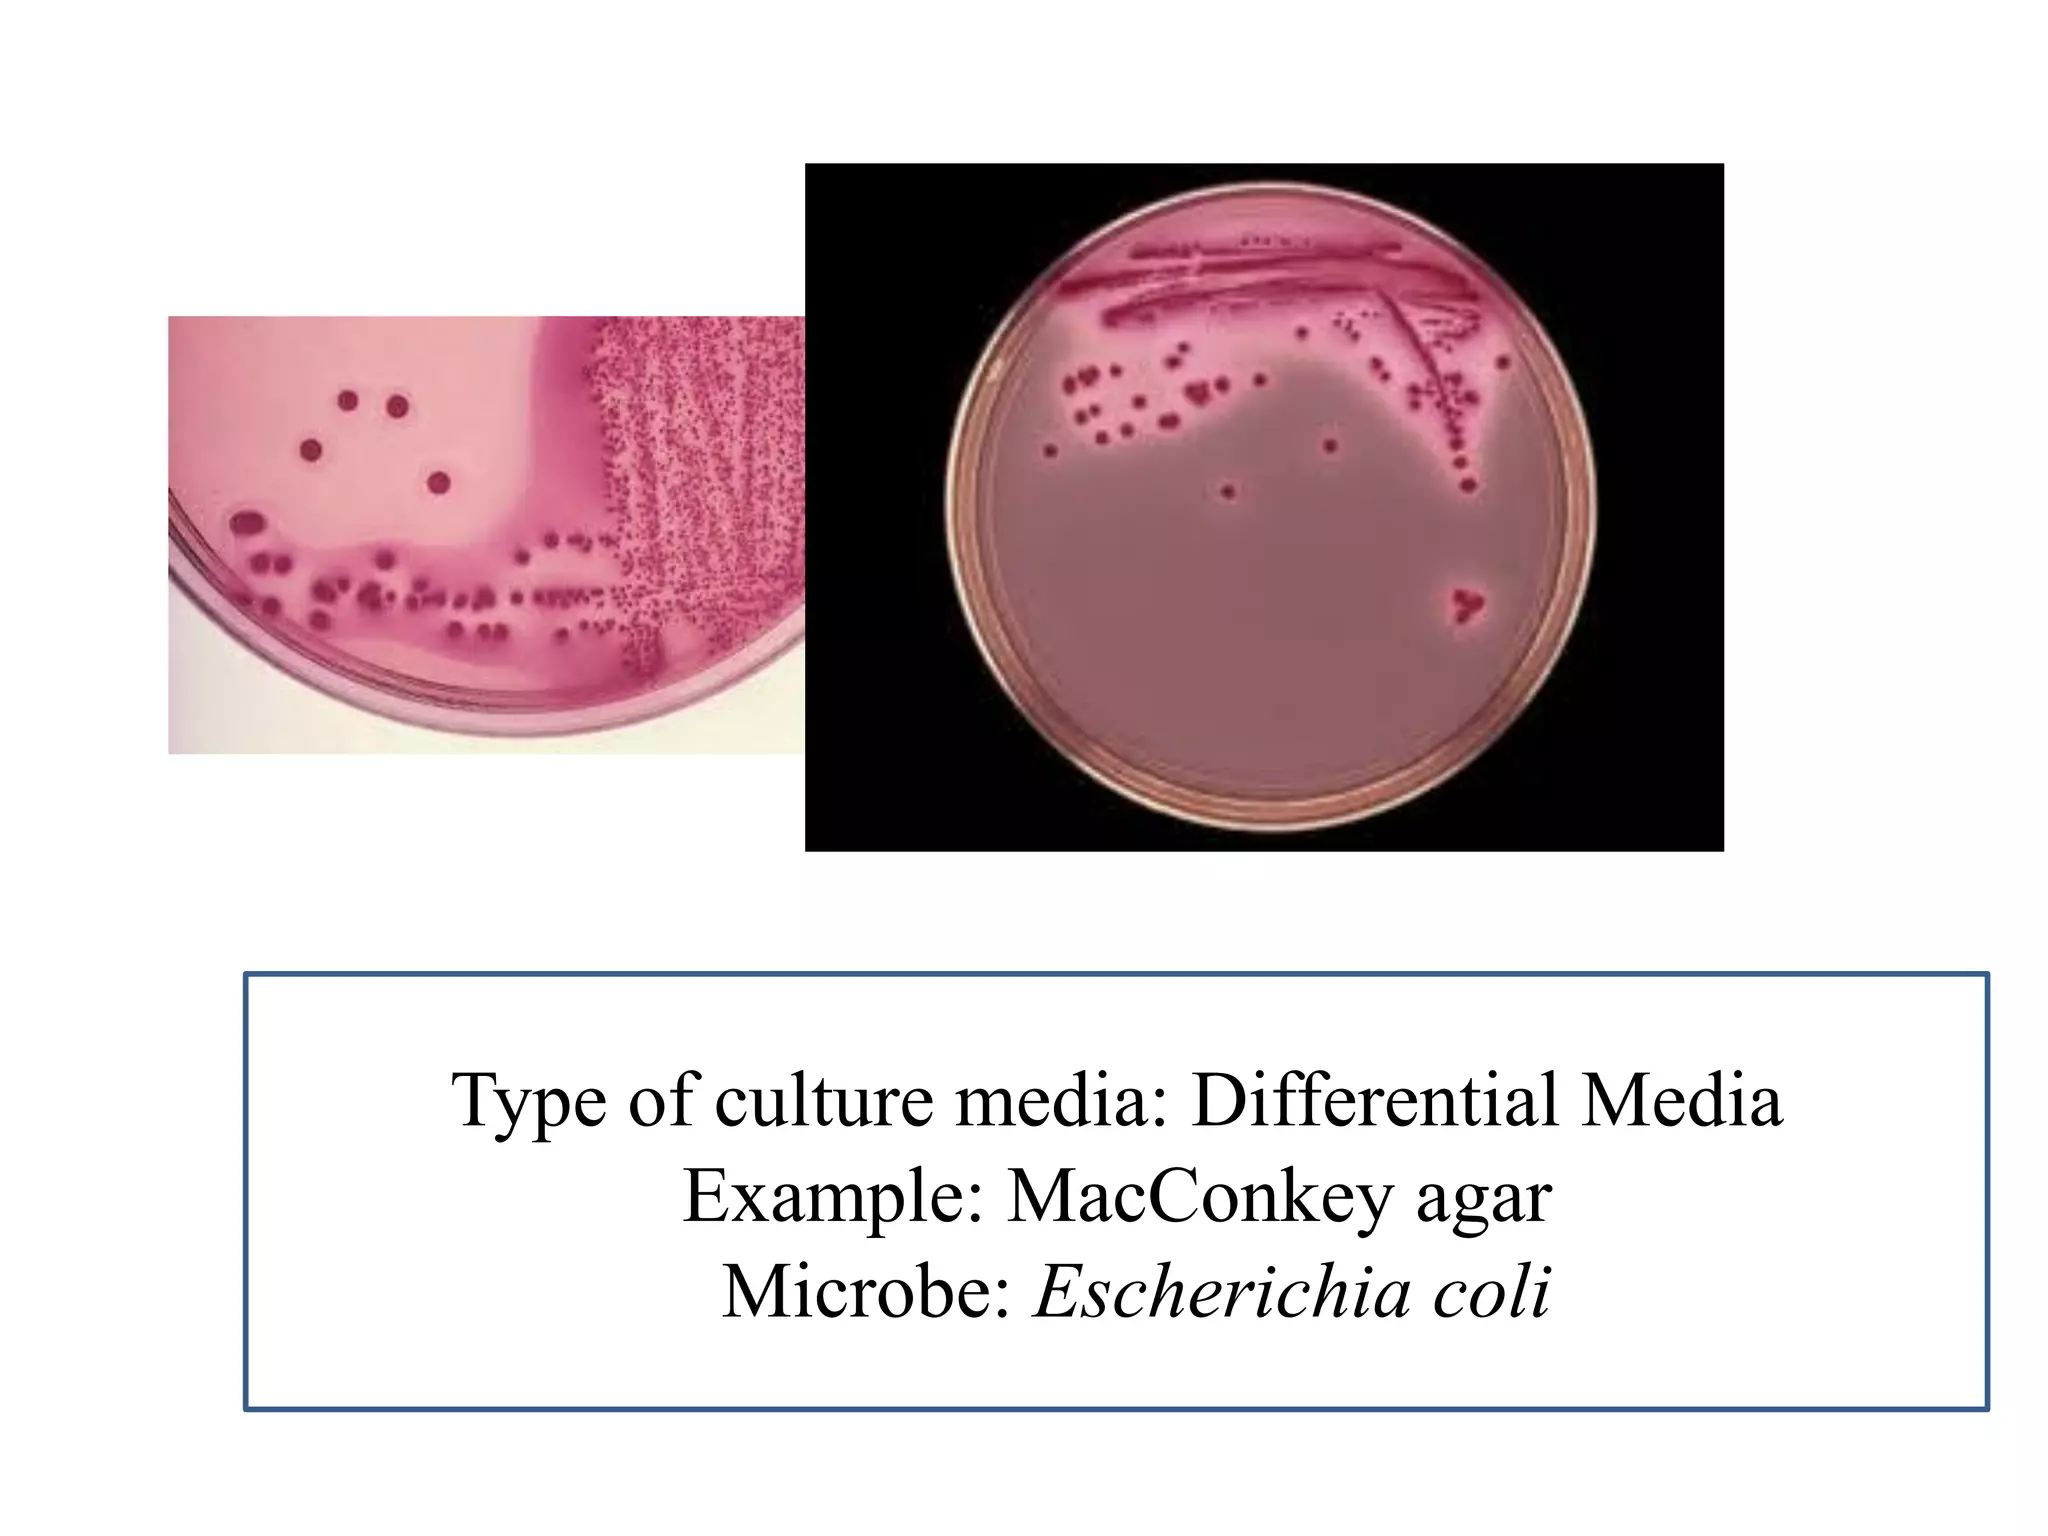
Type of culture media: Differential Media 
Example: MacConkey agar 
Microbe: Escherichia coli
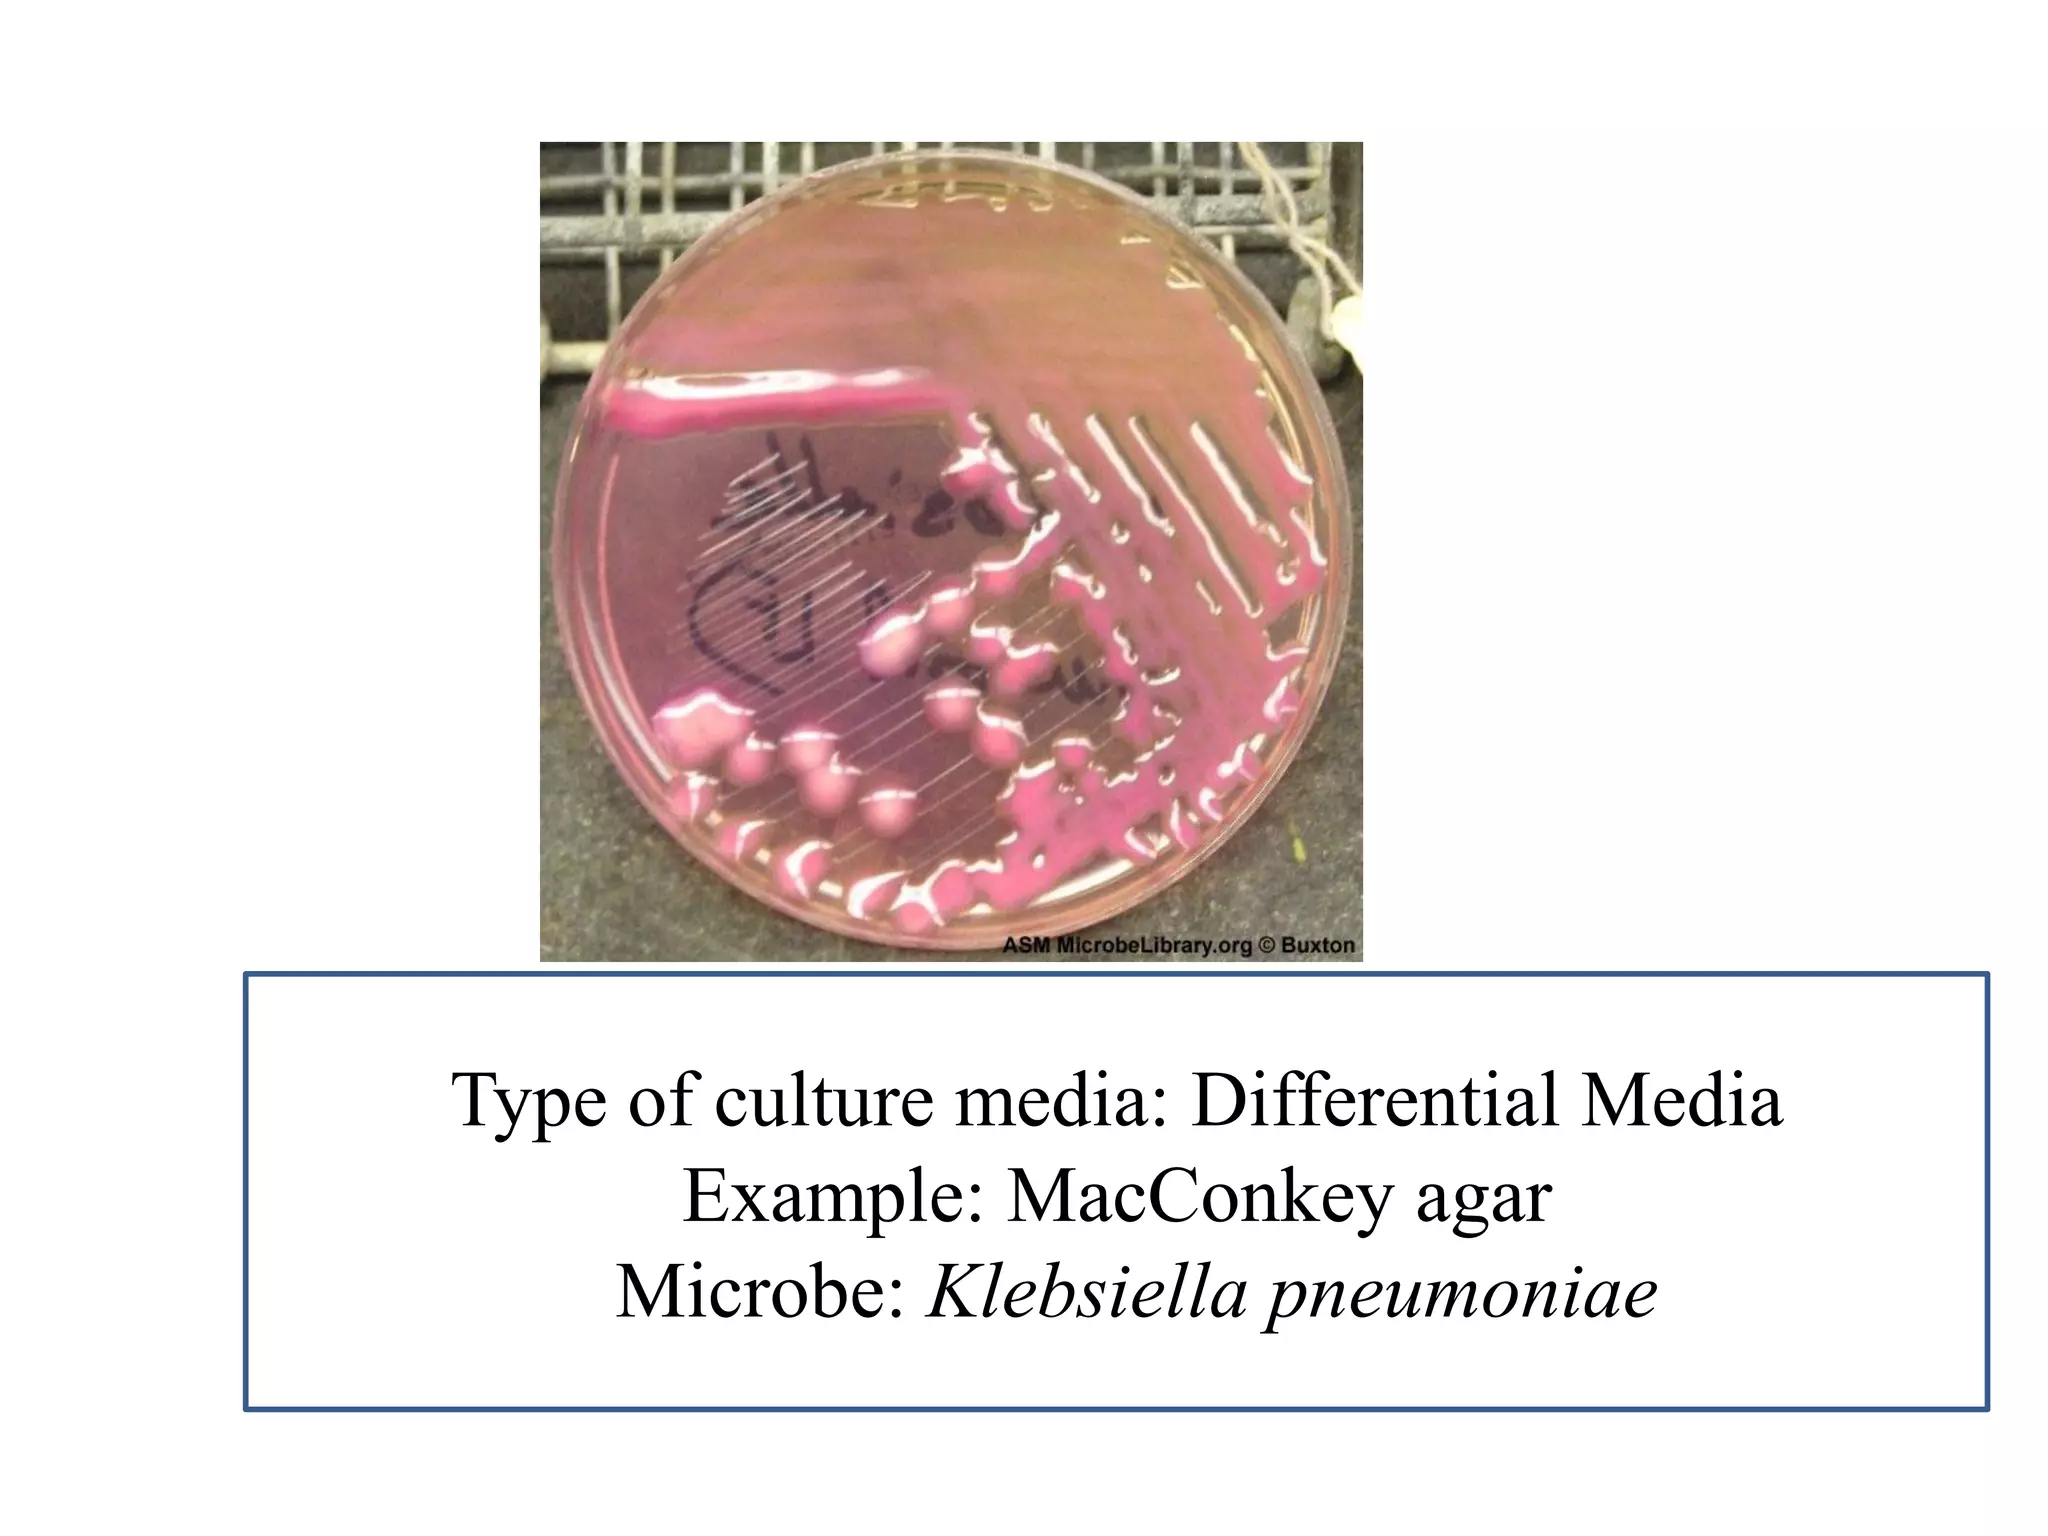
Type of culture media: Differential Media 
Example: MacConkey agar 
Microbe: Klebsiella pneumoniae
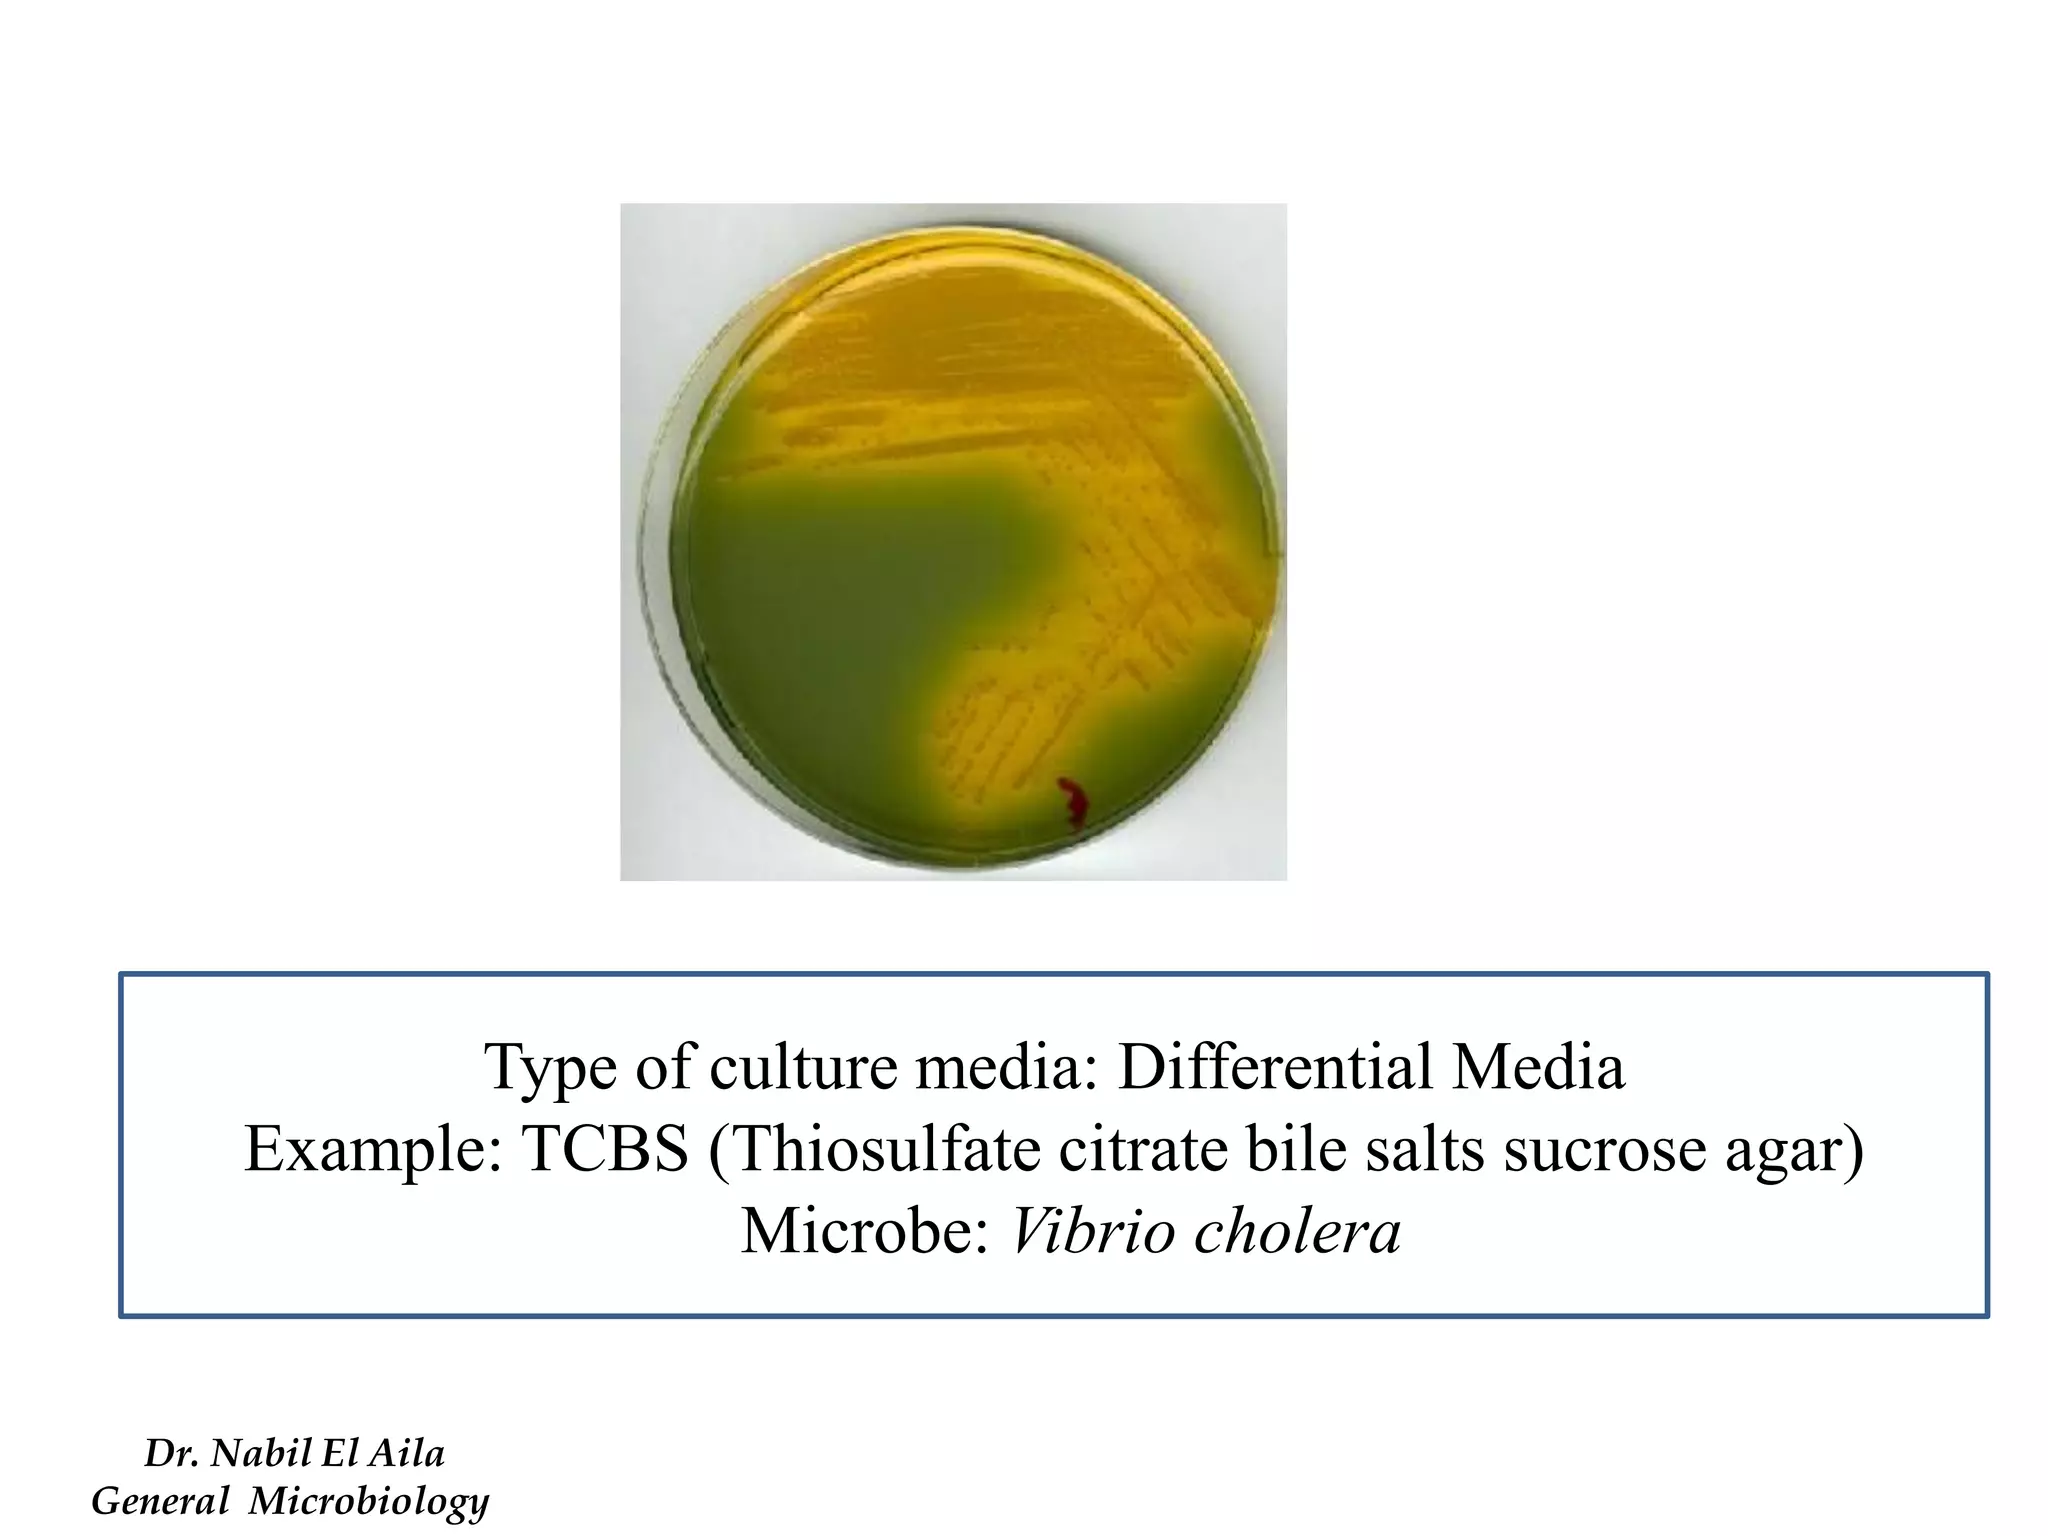
Type of culture media: Differential Media 
Example: TCBS (Thiosulfate citrate bile salts sucrose agar) 
Microbe: Vibrio cholera 
Dr. Nabil El Aila 
General Microbiology
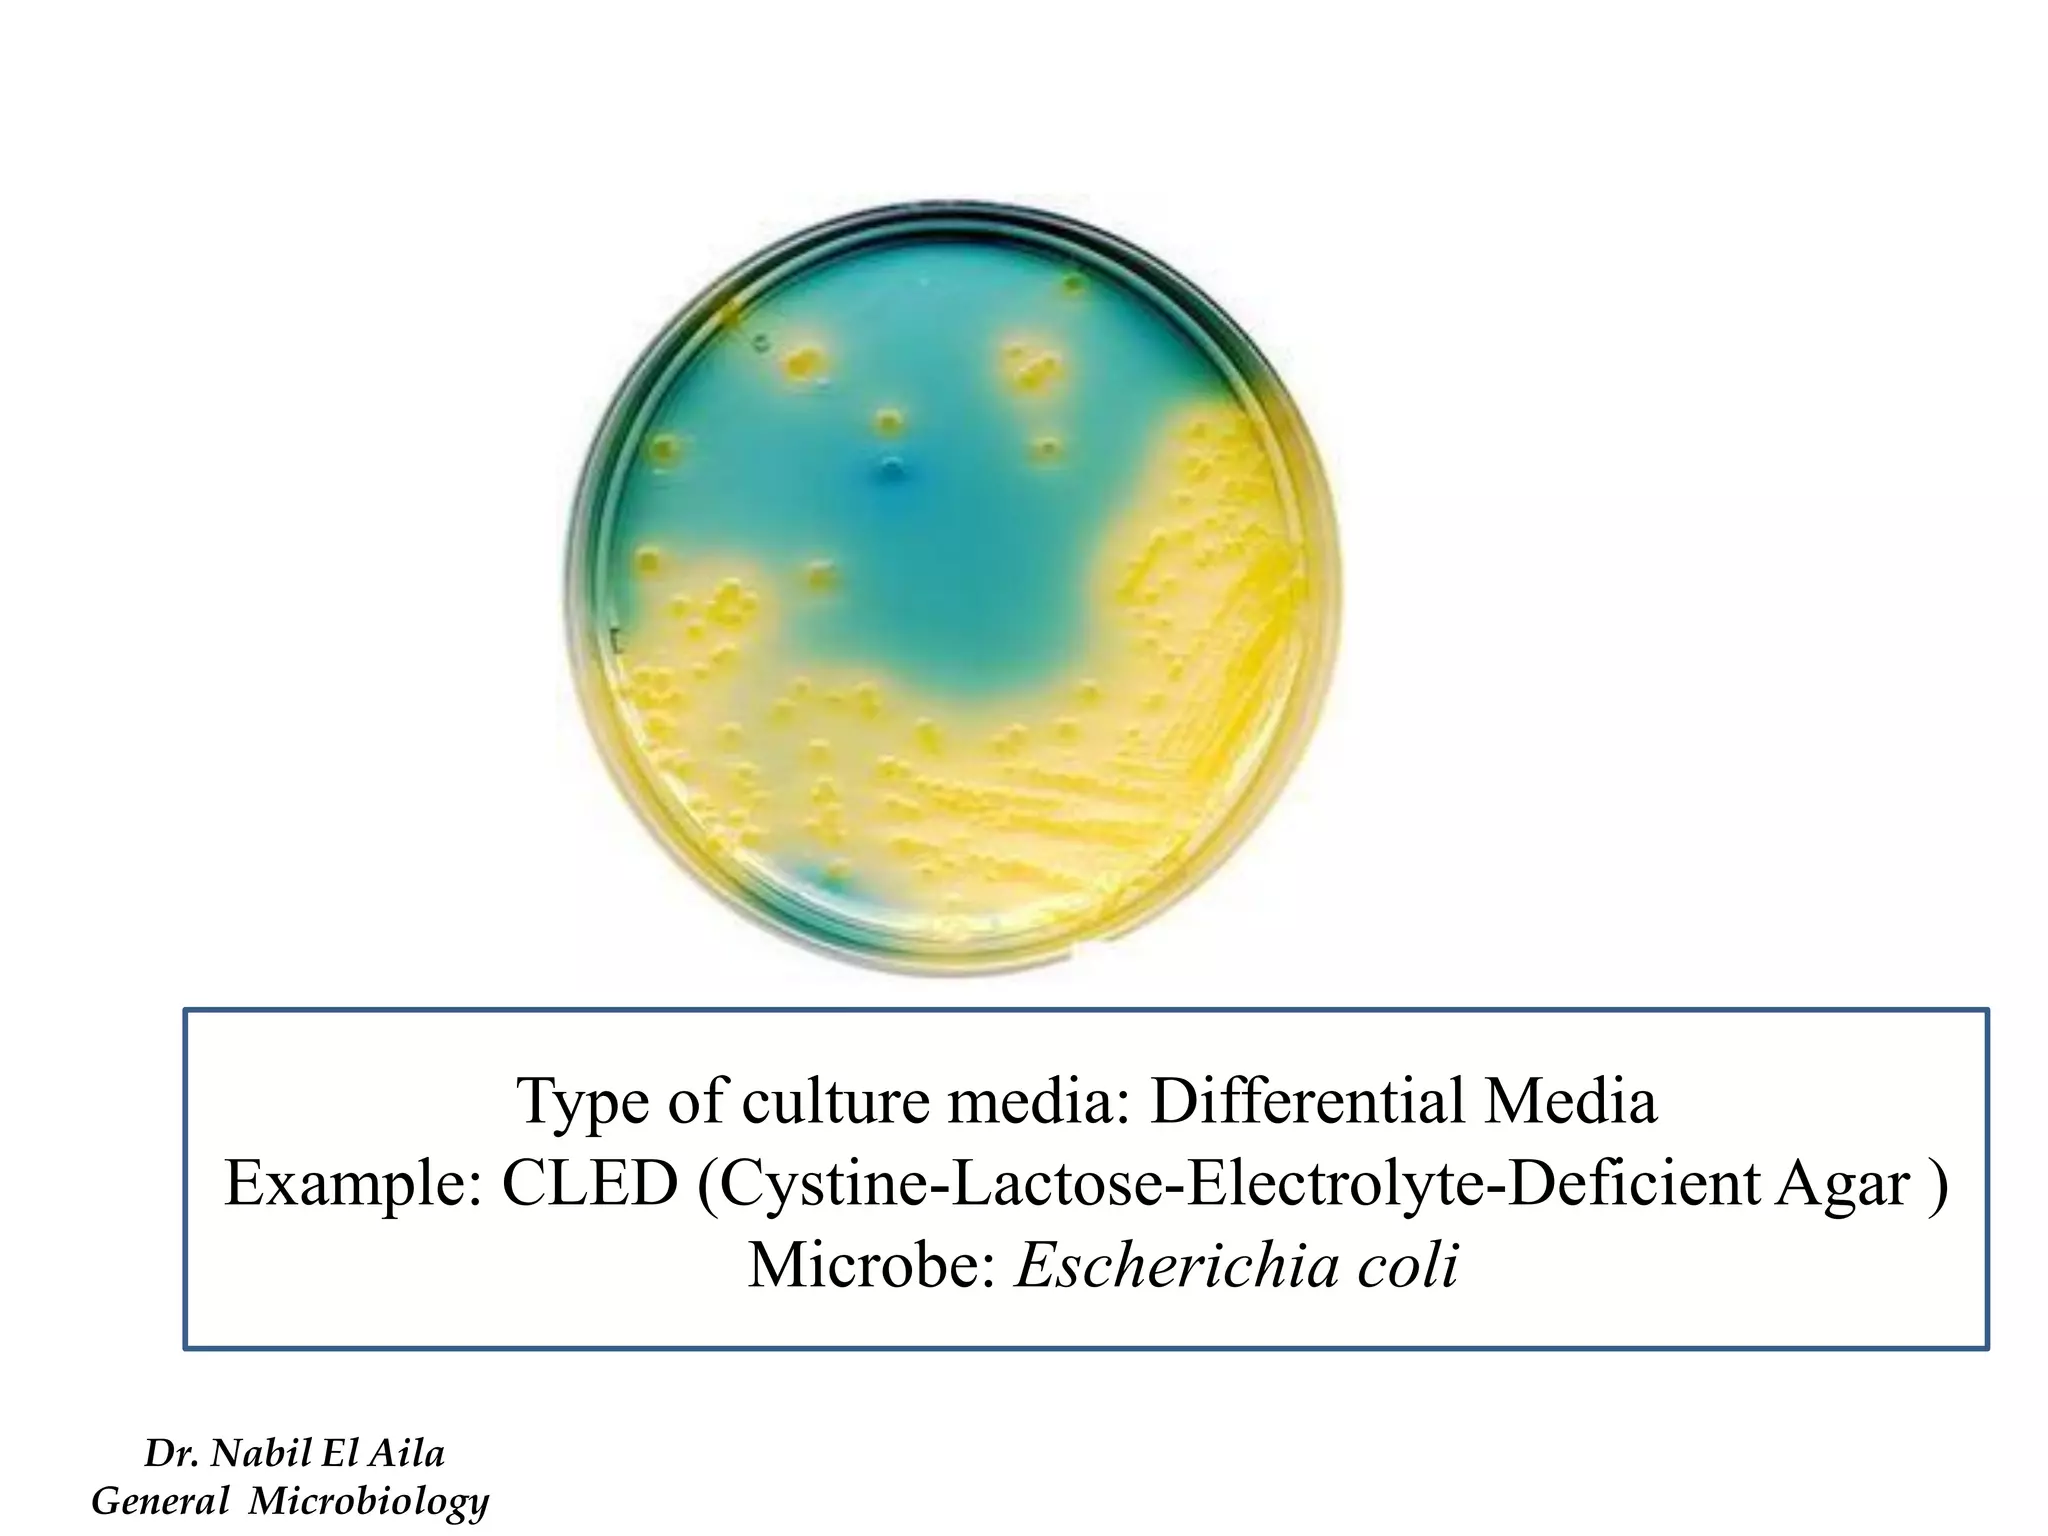
Type of culture media: Differential Media 
Example: CLED (Cystine-Lactose-Electrolyte-Deficient Agar ) 
Microbe: Escherichia coli 
Dr. Nabil El Aila 
General Microbiology
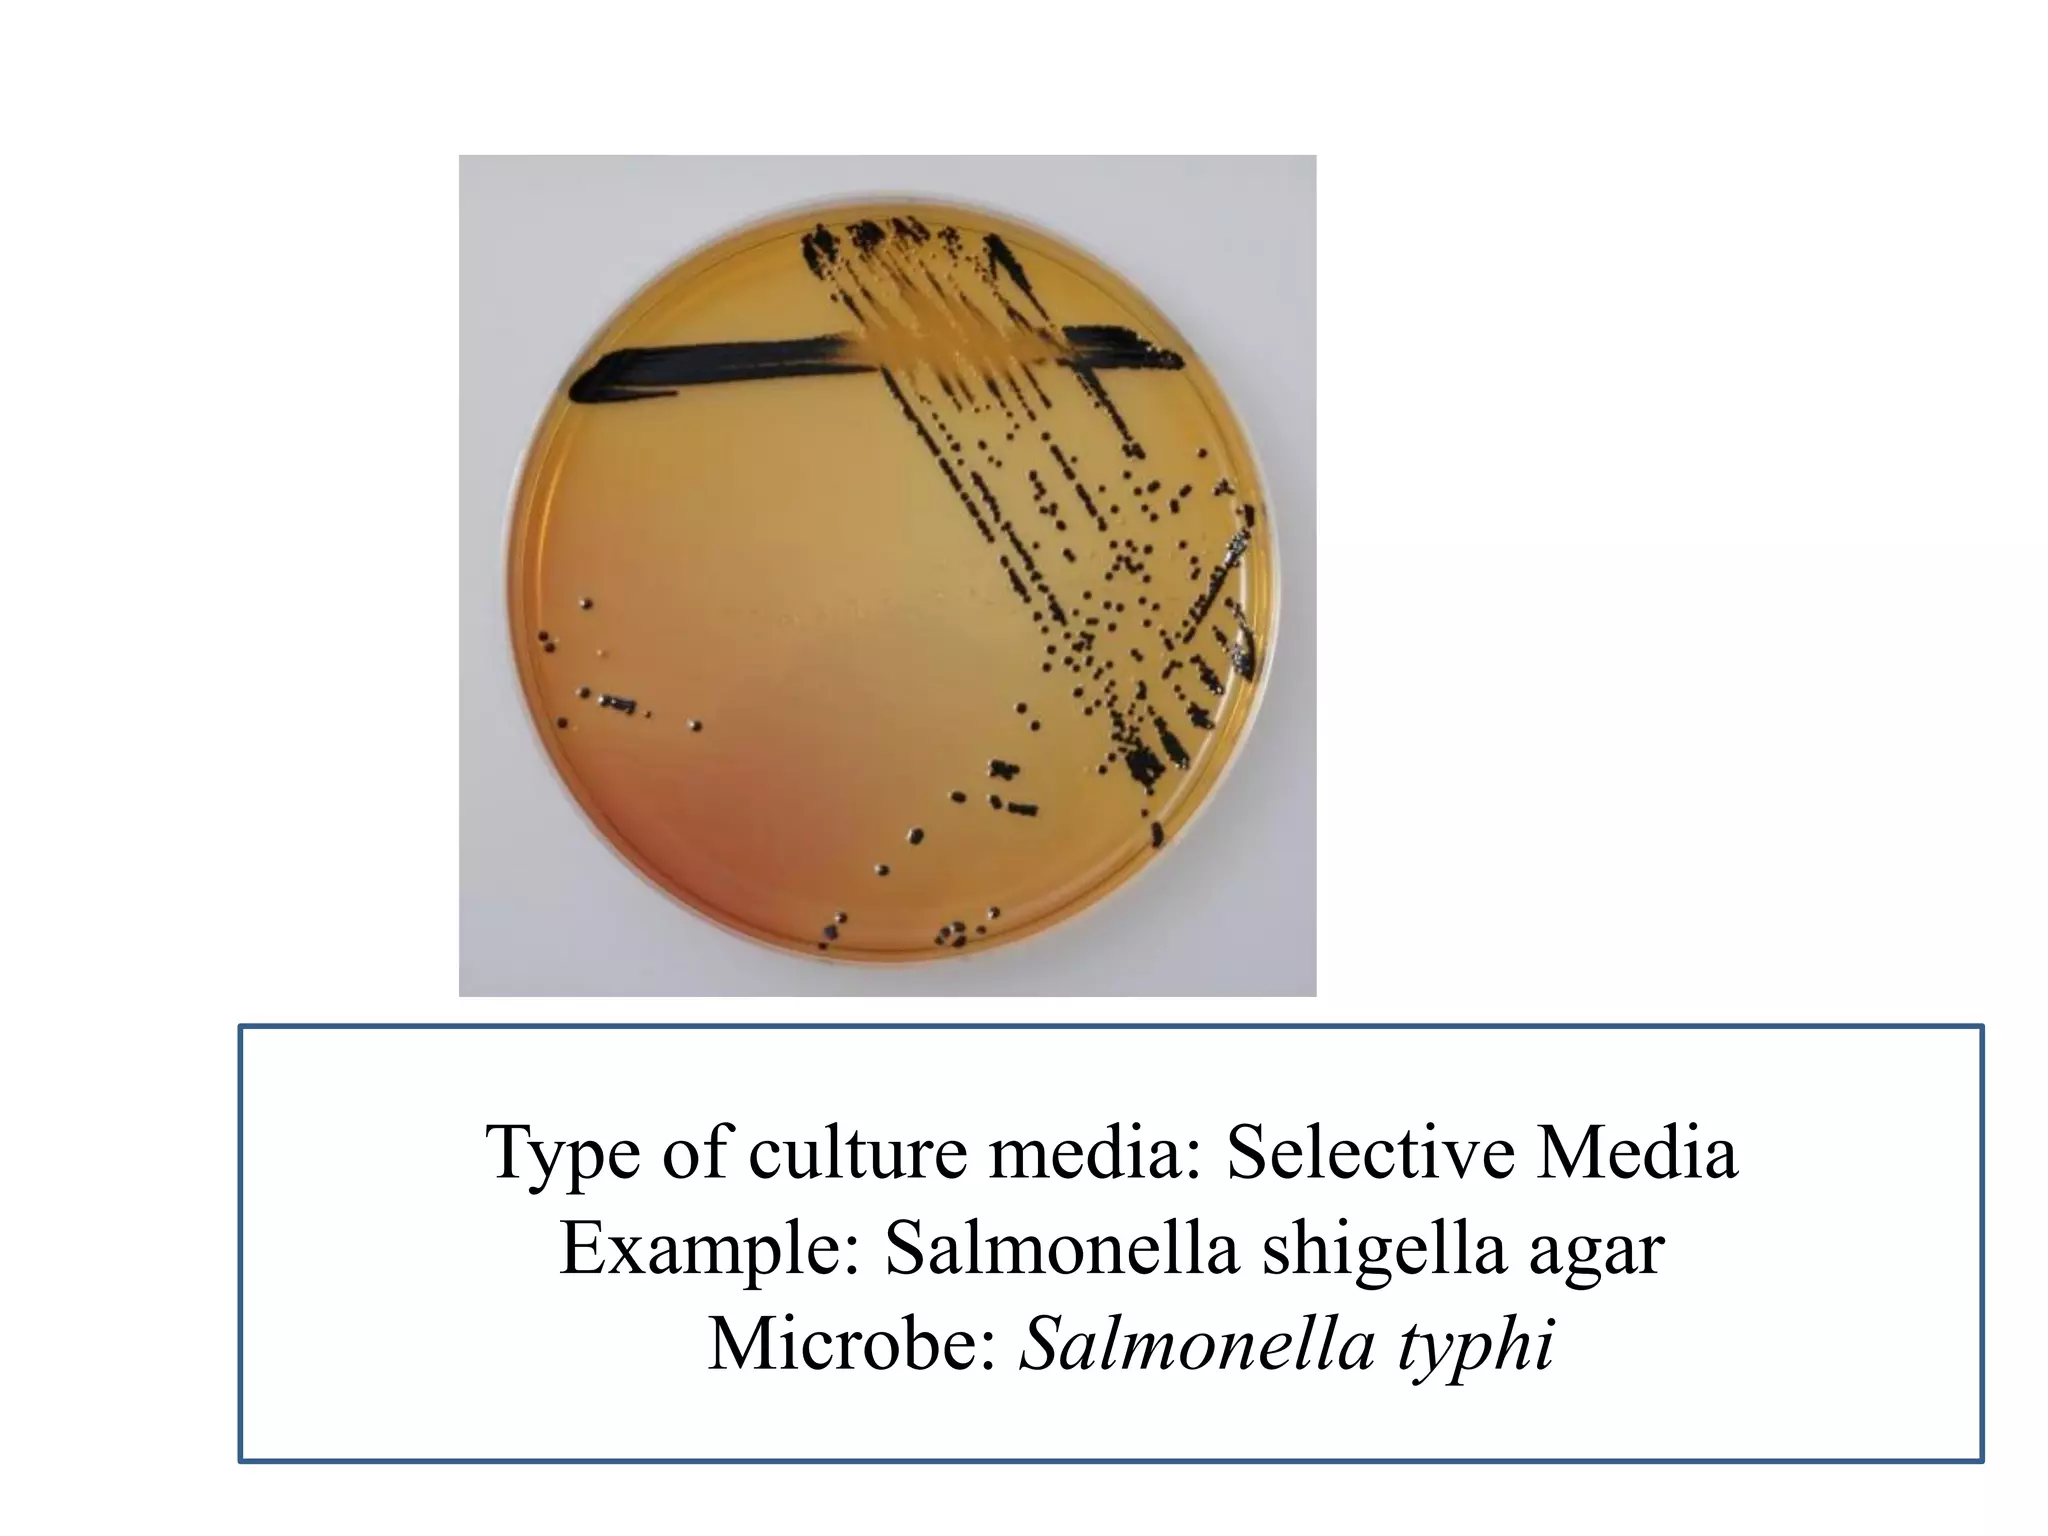
Type of culture media: Selective Media 
Example: Salmonella shigella agar 
Microbe: Salmonella typhi
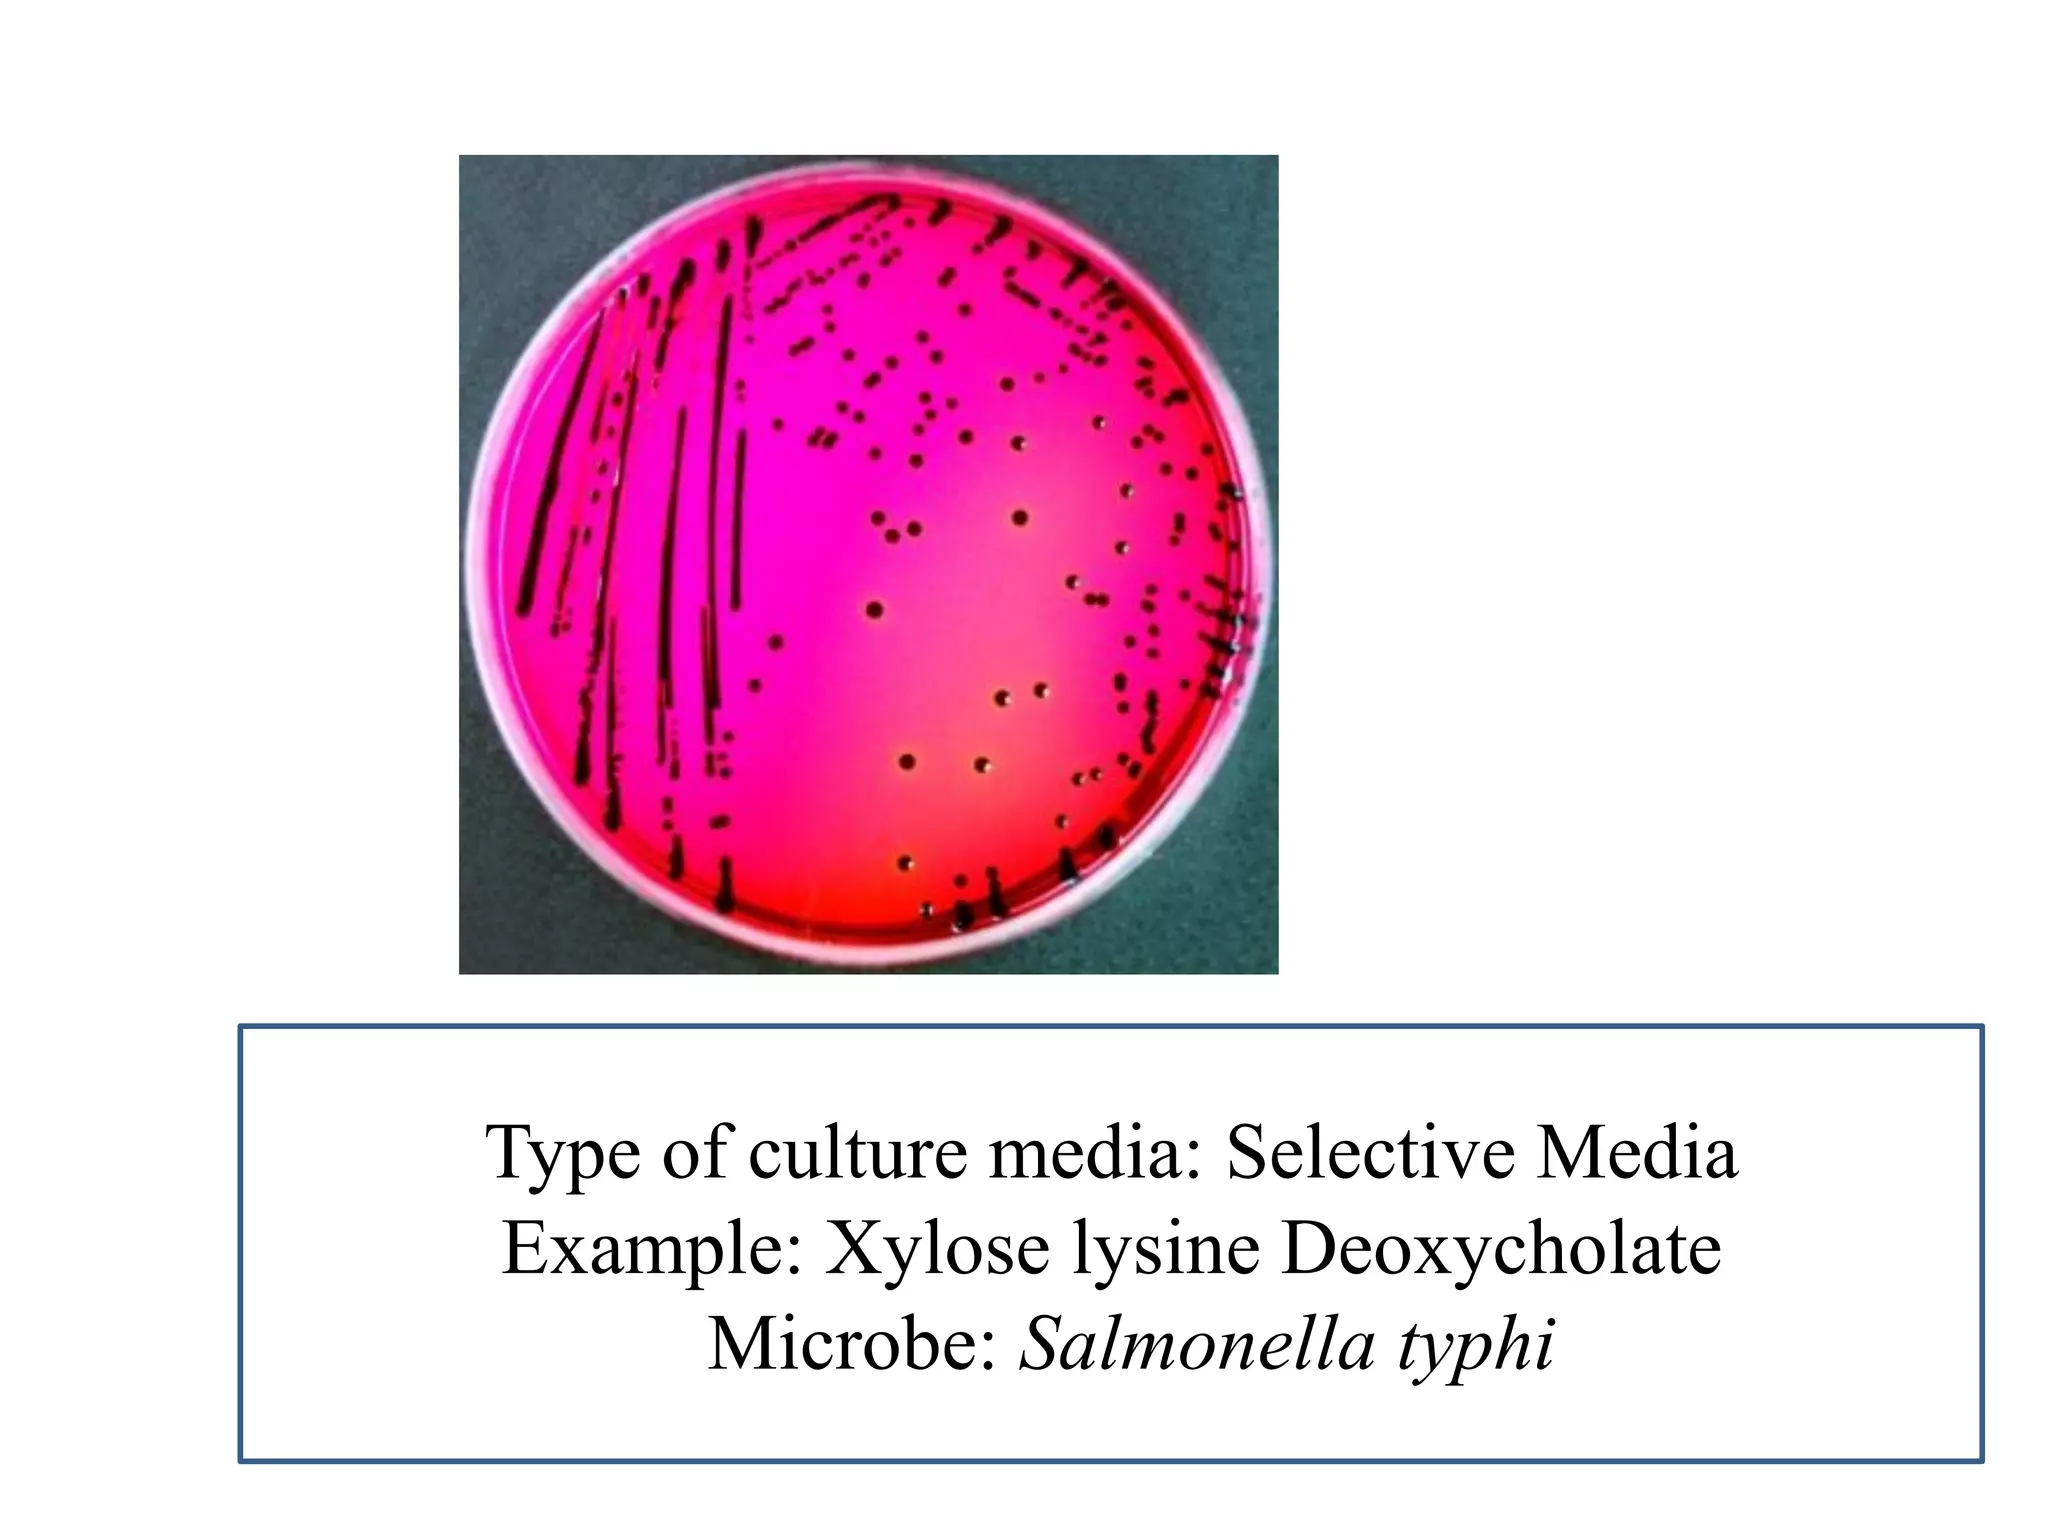
Type of culture media: Selective Media 
Example: Xylose lysine Deoxycholate 
Microbe: Salmonella typhi
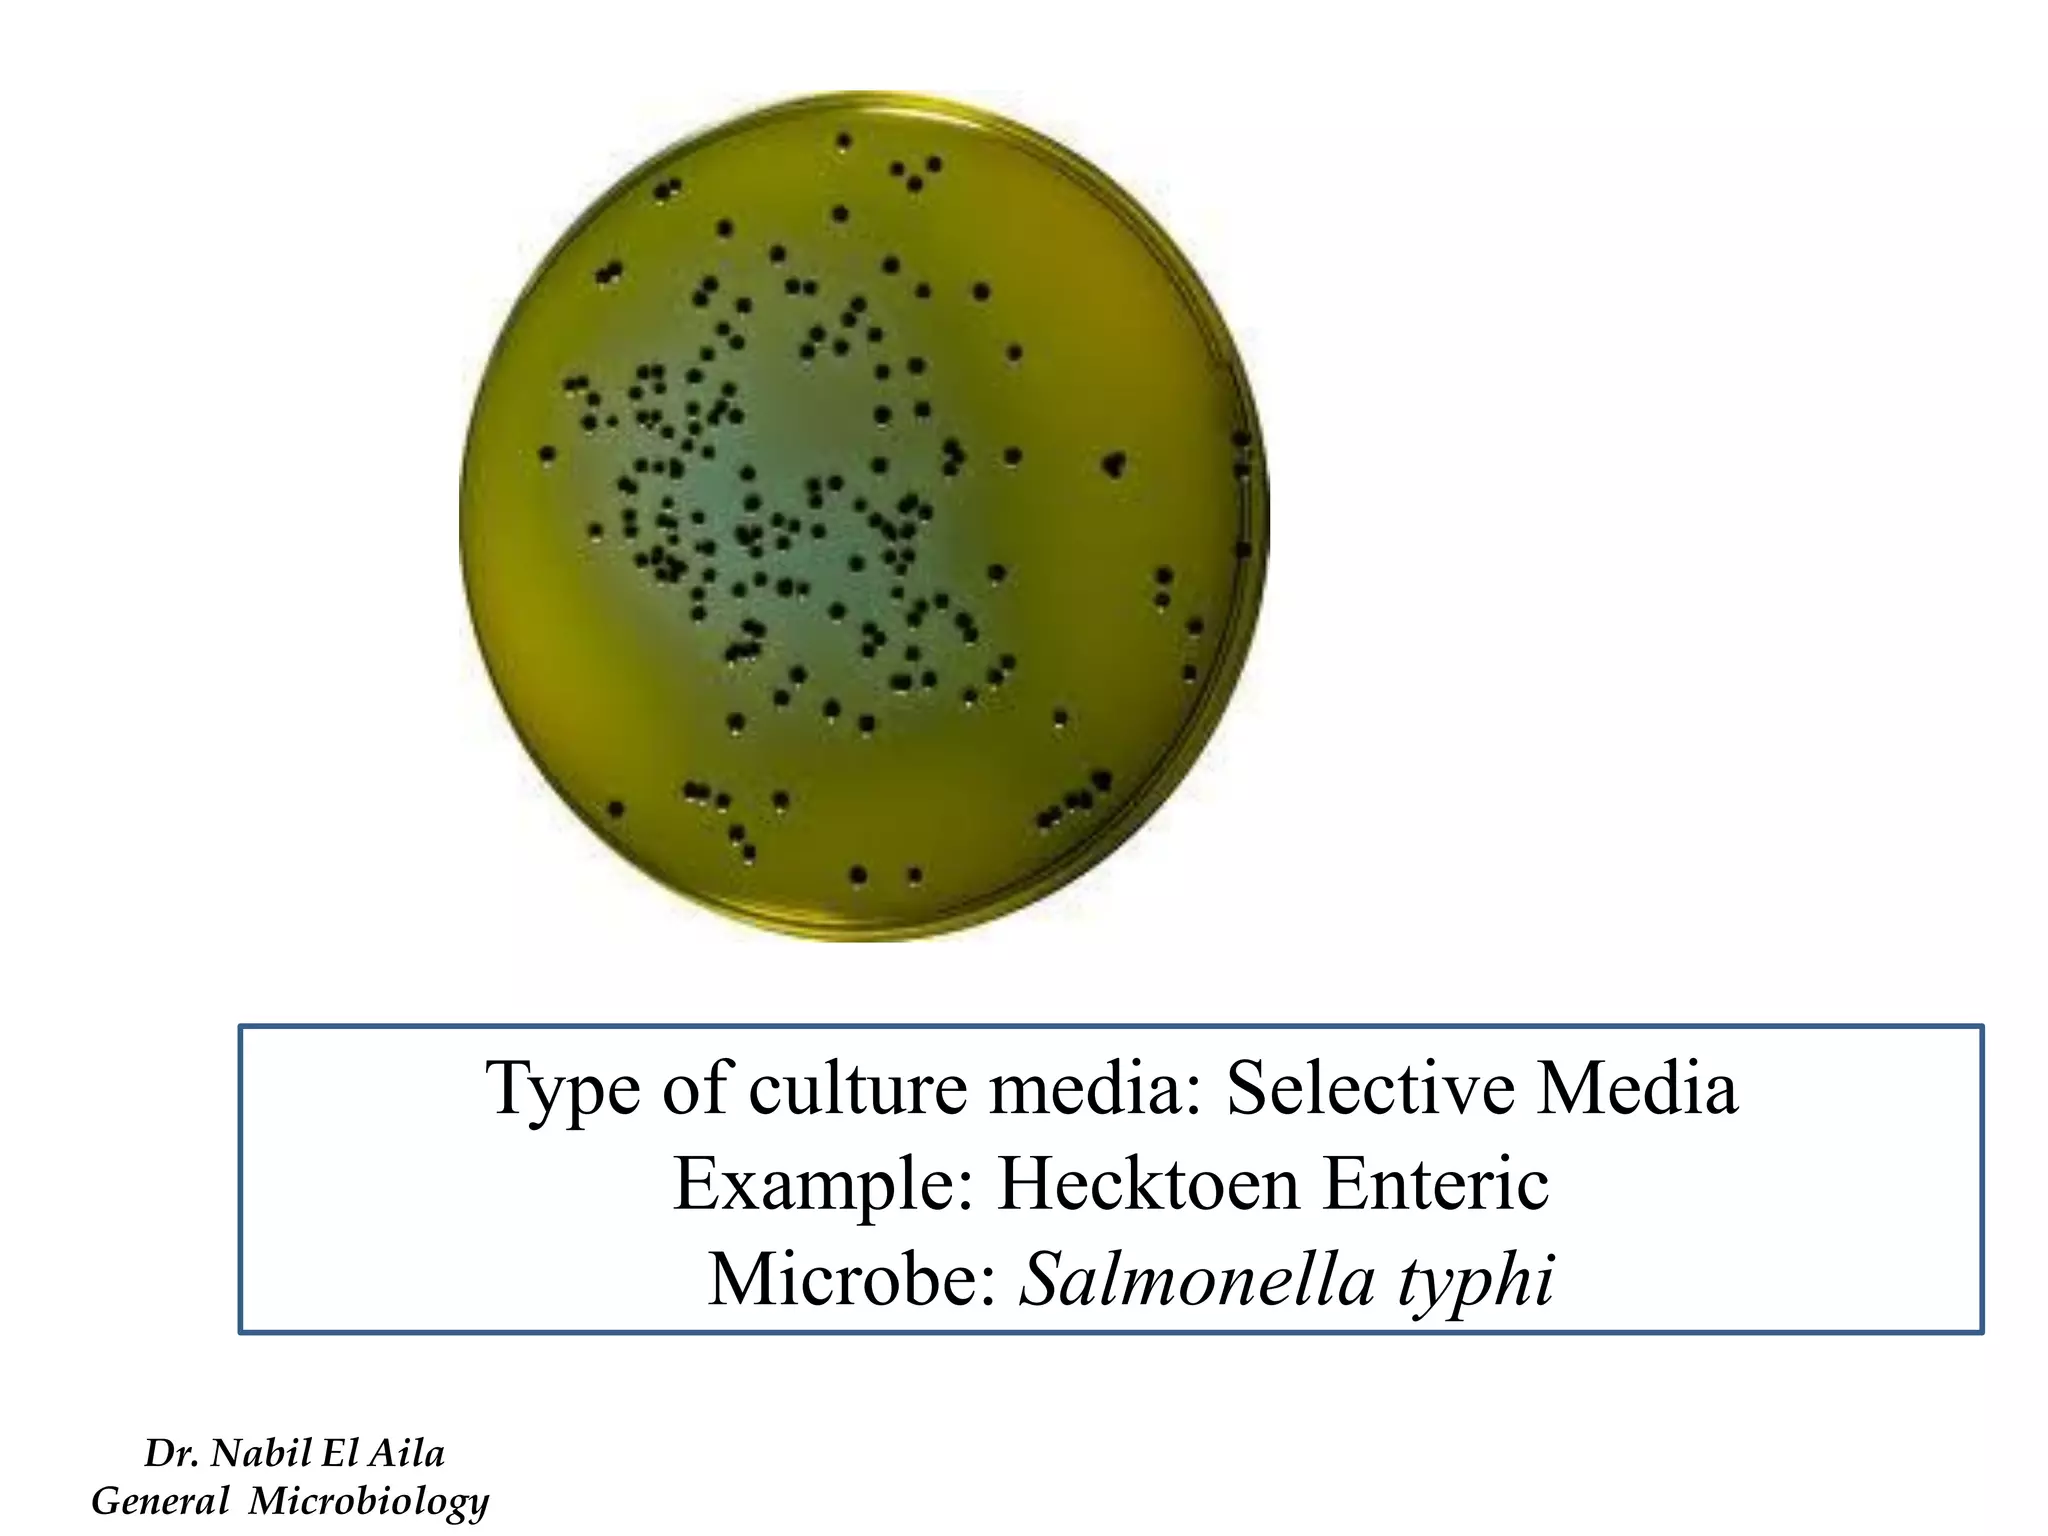
Type of culture media: Selective Media 
Example: Hecktoen Enteric 
Microbe: Salmonella typhi 
Dr. Nabil El Aila 
General Microbiology
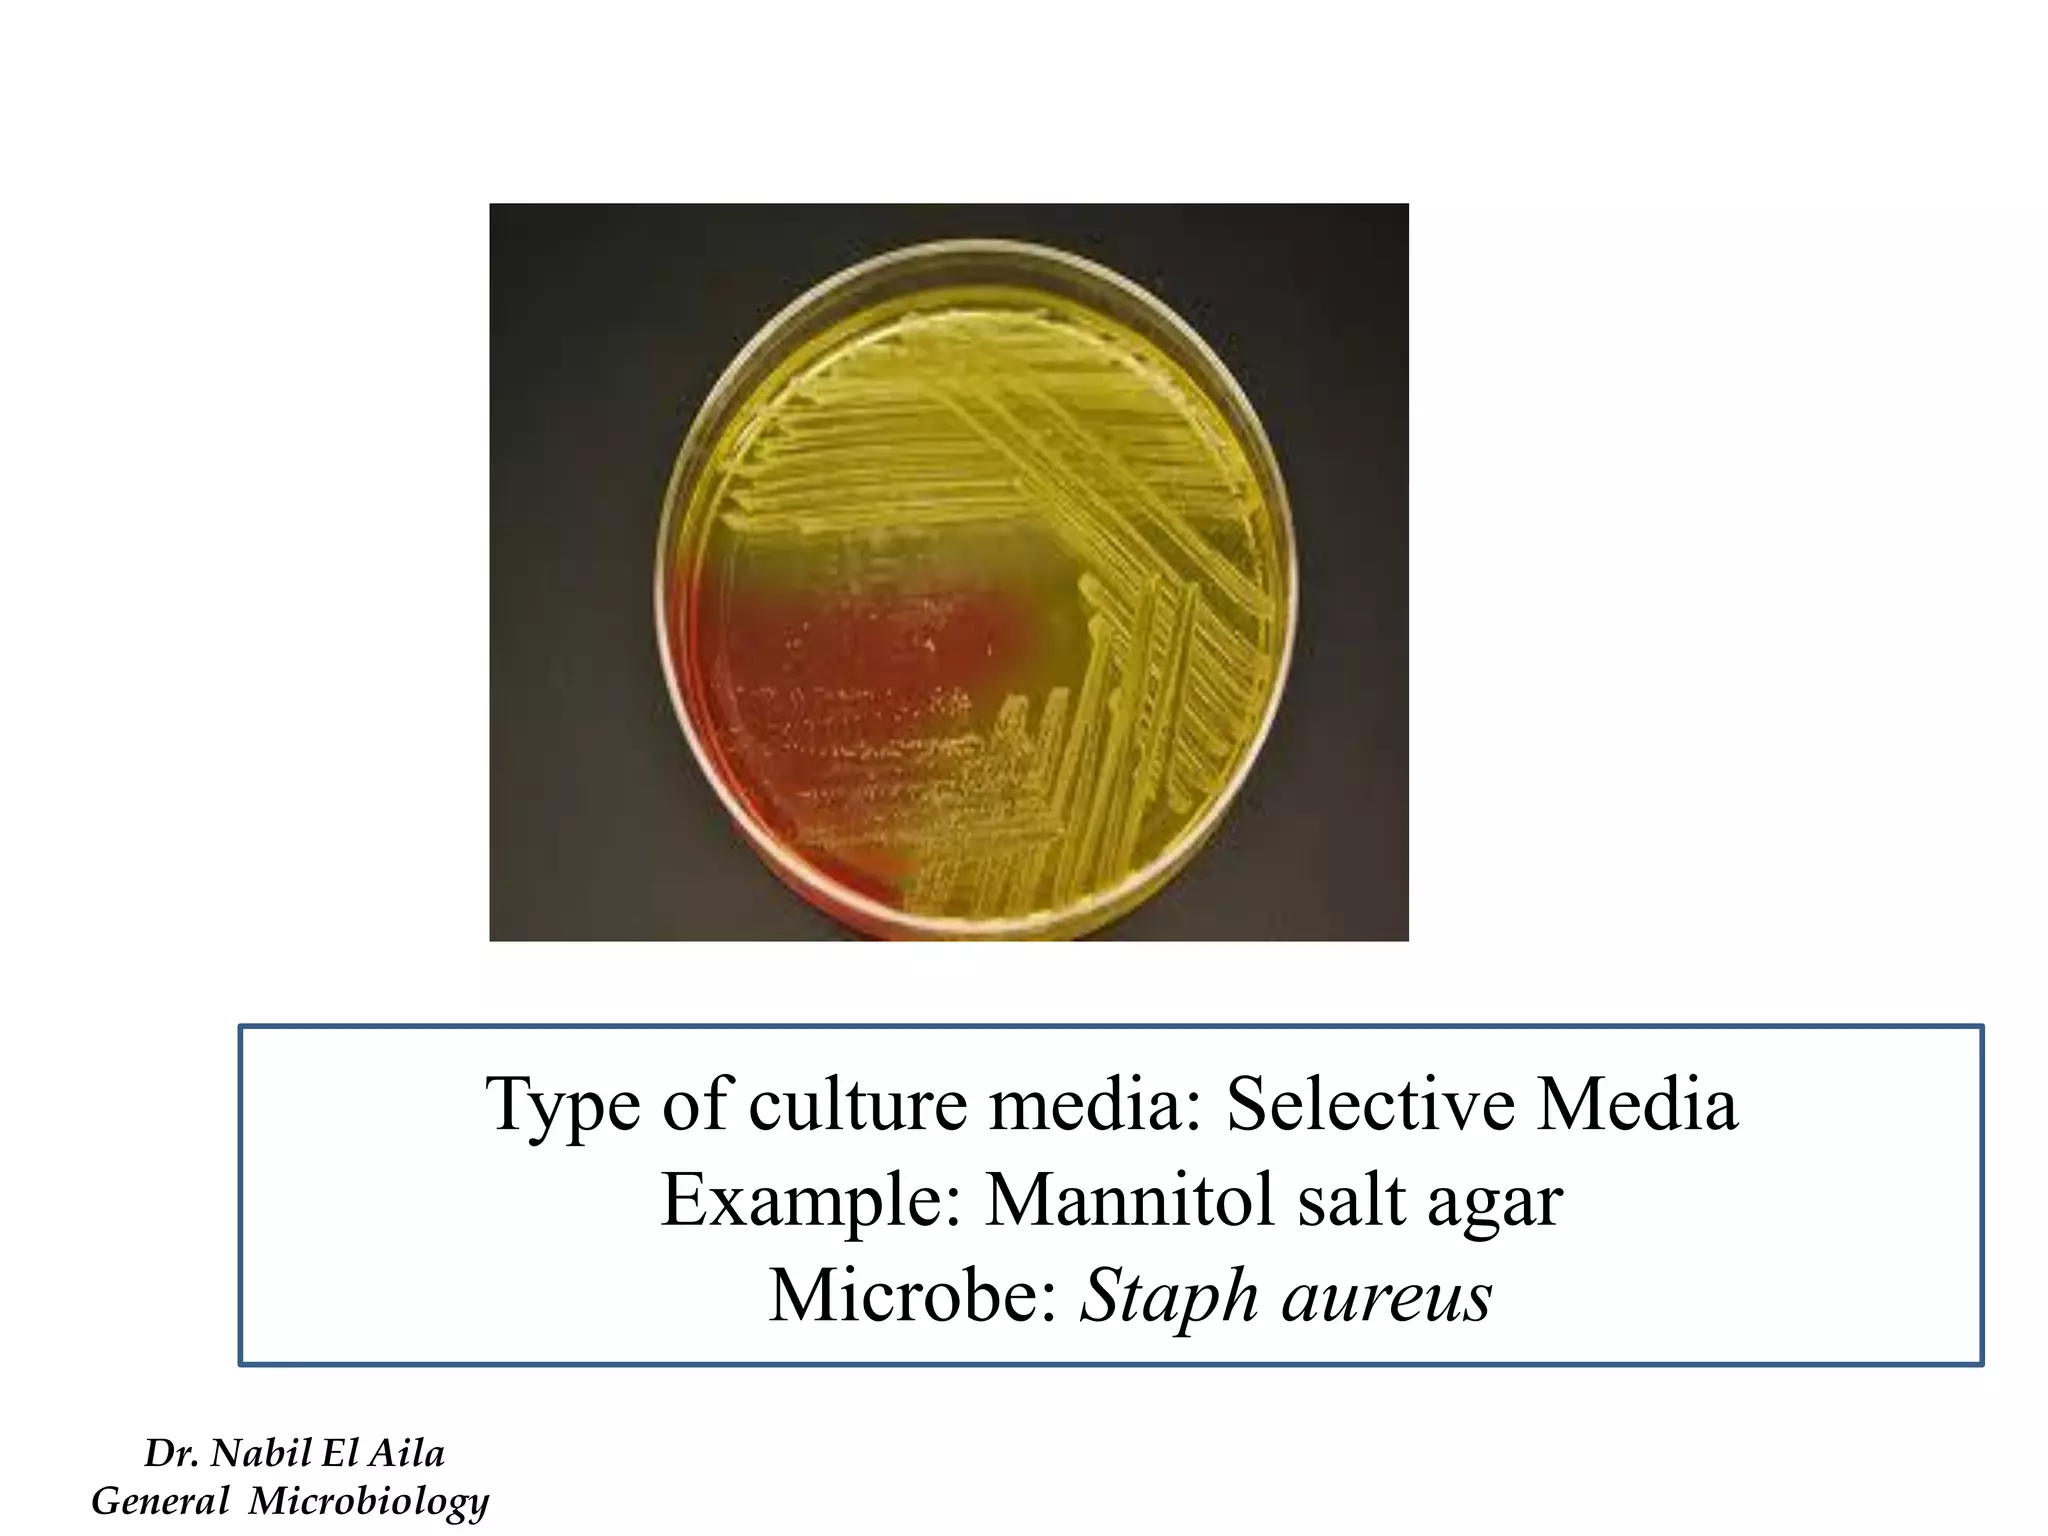
Type of culture media: Selective Media 
Example: Mannitol salt agar 
Microbe: Staph aureus 
Dr. Nabil El Aila 
General Microbiology
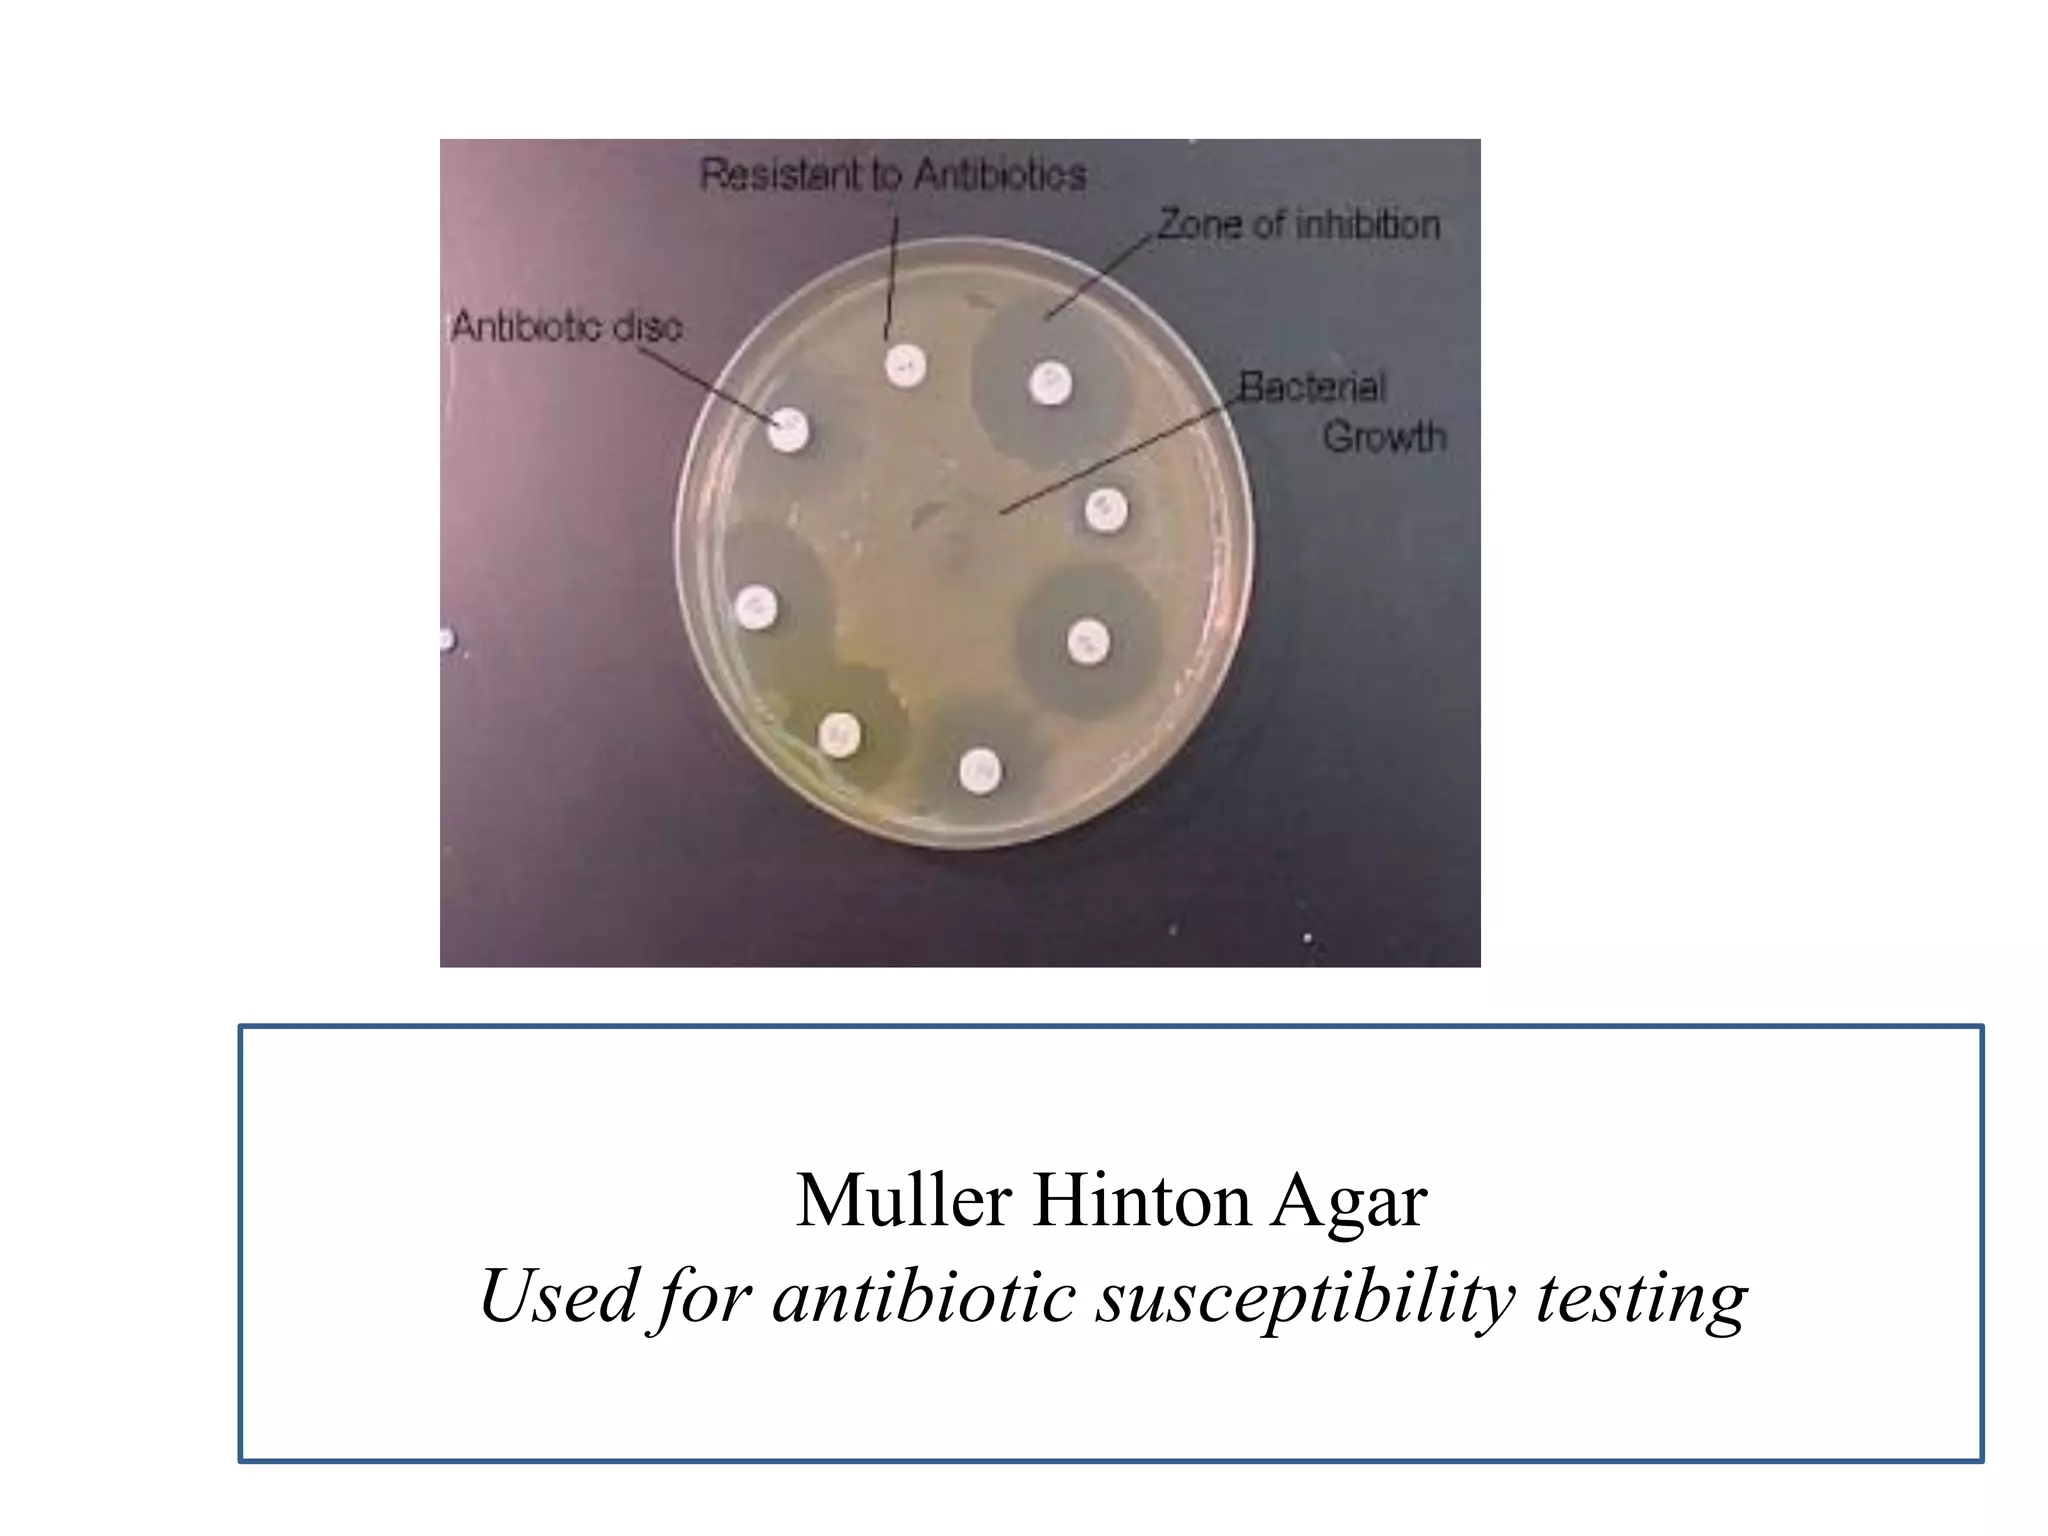
Muller Hinton Agar 
Used for antibiotic susceptibility testing

This document provides information on various microbiology tests used to identify bacterial species, including examples of positive and negative results. It describes tests such as the catalase test to distinguish Staphylococci from Streptococci, the coagulase test for identifying Staph aureus, and the DNase test to differentiate Staph aureus from Staph epidermidis. It also summarizes culture-based tests on different media types to isolate and identify bacteria such as Salmonella, E. coli, and Streptococcus species.